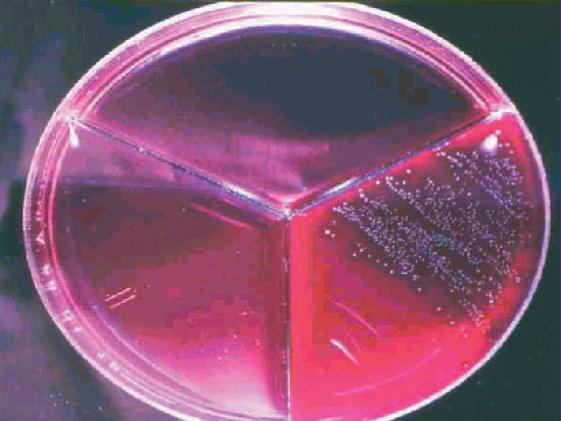

Marzo/abril 2016 - XXXVI Año - Núm. 212


•Ganadería Los Huertos de Aldeanueva
•Concurso Catalán de la Raza Frisona
•Conferencia Mundial Holstein

•Pasión por el Rojo
•Tratamiento de la mastitis clínica
•Retención de placenta
•Reglamento del 37º

Concurso Nacional CONAFE’16

Marzo/Abril 2016 nº 212
Tercera página......................................................................................3

Noticias del sector................................................................................4
REPORTAJES
•Concurso Catalán de la Raza Frisona FEFRIC’16..........................8
•Concursos locales:
Subasta de Chantada (Lugo).......................................................14
30º Concurso de vacuno frisón de Menorca..............................14
30º Concurso de ganado frisón y subasta de Moexmu............15
34º Concurso de la Raza Frisona de Campllong........................16
Subasta de Boimorto (A Coruña).................................................16
•Ganadería Los Huertos de Aldeanueva (Toledo)......................18
•Jornada Bayer. Retos de futuro del sector de vacuno de leche en España.......................................................................24
•Foro Zoetis de Farmacoeconomía en Vacuno de Leche.........28
•Conferencia y 14ª Asamblea de la Federación Mundial Holstein.............................................................................................32
OPINIÓN
• Gabriel Blanco. Nuevo presidente del grupo de trabajo de Calificación de la WHFF ............................................36
CONAFE
• Acuerdos de la Junta de Gobierno..............................................42
•Reciclaje de Jueces de CONAFE.................................................44
GENÉTICA
•Pasión por el Rojo. J.A. Jiménez ..................................................46
•Familias de vacas españolas: Ania. J.A. Jiménez.......................50
•Consultorio Genómico...................................................................52
•Evaluaciones genómicas de las mejores novillas genómicas con edad inferior a 18 meses. Dpto. Técnico de CONAFE.......54
•Nuevos toros en reparto.................................................................58
ESCUELA DE JUECES SOBRE PAPEL
•Resultados sección 73ª...................................................................64
•Sección 74ª......................................................................................65
CALIFICACIÓN
•Animales calificados EX y MB durante los meses de enero y febrero de 2016.................................................................70
CONTROL LECHERO
•Mejores vacas en producción......................................................74
ANEMBE RESPONDE
• Mamitis y reproducción. L. Quintela.............................................78
BUZÓN JURÍDICO
•Indemnización del despido improcedente: nuevo criterio del Tribunal Supremo. M. T. Jurado...............................................80
TEMARIO
•Técnicas avanzadas de manejo alimentario: Alimentación de la excreción de nitrógeno al medio ambiente en sistemas lecheros extensivos. F. Diaz-Royón ................................84
•El tratamiento de la mamitis clínica: cuando el antibiótico no basta. M. Martín-Richard..........................................................88
•Retención de placenta. J.V. González .......................................90
•Uso de cama acumulada de compost en vaca de leche (II). A. Callejo ..................................................................94 y además...
• Reglamento del 37º Concurso Nacional CONAFE’16 de la Raza Frisona..............................................................................102
•Guía Comercial.............................................................................109
•Índice de anunciantes.................................................................110
p. 8
18
36
90
p.
p.
p.


Valoración genómica de hembras para seleccionar las futuras mejores productoras de la explotación.
El genotipado de las novillas permite tomar decisiones rápidas y fiables sobre qué animales comprar o vender, detectar enfermedades genéticas, corregir errores de genealogía o consanguinidad...
ConafeMat es un programa de acoplamientos al que se puede acceder a través de SinBad.
Su objetivo es facilitar al ganadero la selección de los toros más adecuados para sus objetivos de selección.
Programa de recogida de información sobre salud podal para el control y prevención de cojeras.
Con la colaboración de un grupo de podólogos, se recogen datos sobre dermatitis digital e interdigital, úlcera plantar, flemón interdigital, lesión de la línea blanca, laminitis crónica e hiperplasia interdigital.

Vacas en la ganadería
Los Huertos de Aldeanueva
PUBLICACION
BIMESTRAL AÑO XXXVI NUM. 212
Marzo/Abril 2016
Directora: Pilar López Caño
Subdirector: Baldomero Fernández Fernández
Diseño y Publicidad: Departamento propio
Suscripciones: Charo García Tovar
Redacción, Publicidad y Suscripciones Revista Frisona Española - CONAFE Apdo. de Correos 31 28340 Valdemoro (Madrid) Ctra. de Andalucía Km. 23,600
Tlfs: 91 895 24 12/62/68 - Fax: 91 895 14 71
Correo Electrónico: publicidad@revistafrisona.com suscripciones@revistafrisona.com conafe@conafe.com
Páginas Web: www.revistafrisona.com www.conafe.com
Precio Suscripción 2016
España.............48 Euros (IVA incluido) Europa..............77 Euros (IVA incluido) Resto Mundo...90 Euros (IVA includio)
Edita:
Confederación de Asociaciones de Frisona Española
Junta de Gobierno de CONAFE
Presidente:
Germán de la Vega Delgado, AFCA
Vicepresidente:
José Emilio García Suárez, ASCOLAF
Secretario:
José Carlos Vega Rodríguez, FEFRIGA
Tesorero:
José Antonio Hernández Martín, FEFRICALE
Interventor:
Jaime Olascoaga Enseñat, AFB
Vocales:
Antonio Casas García, AFA
Beni Irurita Loiarte, AFNA
Carlos Manuel Sánchez García, AFRIARA
José García Rojas, AFRICAMA
Miguel González de Parla, AFRIDEMA
Valentín Novales Elejalde, EFRIFE
Josep Rebés González-Nandín. FEFRIC
Sofia Alday Martínez de Cestafe, Directora Gerente
Impresión: Monterreina
ISBN. 9211-3767
Depósito Legal: M-5.568-1981
CONAFE no se responsabiliza del contenido de los artículos, anuncios y otros escritos firmados, así como tampoco, necesariamente, comparte los criterios de sus autores. Se permite la reproducción total o parcial de los artículos, informaciones y fotografías de esta revista citando el origen.
www.conafe.com
Producción atascada
Ya hace un año que desapareció el sistema de cuotas lácteas por el que se regía la producción de leche de vaca en la UE y casi estamos reclamando que la Comisión lo vuelva a implantar de nuevo.
En este año, la producción se ha disparado, aunque tampoco tanto, pero lo suficiente, dicen, para que haya demasiada oferta a tenor de la demanda actual.
La situación en los mercados internacionales no ha ayudado, pues como consecuencia del bloqueo de Rusia y el descenso del consumo en China, el excedente de leche que se iba a producir y que se pensaba iba a ser absorbido en su mayor parte, por estos dos países, no ha sido así.
Al tiempo en nuestro país ha descendido el consumo de lácteos, como también en el resto de la UE sin embargo los porcentajes tanto de exceso de producción como del descenso del consumo han sido moderados. No se comprende porqué estas razones conlleven a que por parte de algunas industrias se deje de recoger leche en varias zonas de distintas Comunidades Autónomas o, incluso, a que se plantee el cierre de una industria transformadora histórica, como es el caso de Lauki en Valladolid.
Se ha llegado a una situación en la que muchos ganaderos solo piensan en el dicho “virgencita que me quede como estoy”, y que, al menos les recojan la leche.
¿Qué pasa con los famosos tres millones de toneladas?, la diferencia de producción que tenía nuestro país entre la cuota y el consumo real. En nuestro país ha podido aumentar algo la producción pero, ¿tanto para que quede atascada sin que pueda ser absorbida por la industria que opera en nuestro país? Seguimos pensando que los ganaderos han hecho todo lo posible para ser competitivos, mientras que la industria no ha avanzado ni un paso en dar valor añadido a la leche que producimos, transformándola en productos alimentarios más apetecidos por los consumidores que la simple leche UHT en brik. No nos queda más remedio que dar la razón a aquellos que apuntaban que esos tres millones se debían a la cantidad de productos ya elaborados, que importábamos y que iban directamente a los lineales.
Y, respecto a fomentar el consumo de productos lácteos, nos gustaría que las campañas publicitarias tuvieran más difusión.
Ante la situación tan dramática y -no exageramos- que vive hoy el sector lácteo, la Comisión, a petición de los distintos estados miembros, ha tenido que tomar medidas, como la de sugerir un descenso de la producción voluntaria y sin remuneración ni ayuda alguna, hasta el mes de septiembre, decisión que no todos los países comparten, como Holanda e Inglaterra entre otros.
A estas medidas hay que añadir las decisiones tomadas por el Gobierno en funciones en nuestro país, que en Consejo de Ministros aprobó un Real Decreto por el que se regulan las declaraciones obligatorias a efectuar por los fabricantes de leche líquida envasada de vaca. Se establece así la obligación para los fabricantes de remitir, durante los primeros 20 días del mes, información mensual al FEGA, de las transacciones comerciales efectuadas el mes anterior, de forma análoga a la obligación que se introdujo para los productores y primeros compradores mediante el Real Decreto de 24 de abril 2015, sobre declaraciones obligatorias a efectuar por primeros compradores y productores de leche y productos lácteos de vaca, oveja y cabra.
Al tiempo en INLAC están trabajando para ver de qué manera se puede poner en práctica la reducción voluntaria de la producción, sin que afecte a nuestros ganaderos y que no sea una brecha por la que entre más leche de fuera de nuestras fronteras.
Sí, es verdad que nuestros ganaderos lo tienen bastante claro y son conscientes de la realidad del mercado y saben, porque así se lo han manifestado, que el futuro pasa por una producción más eficiente con más calidad y menos costes de gestión en definitiva que tienen que poner en práctica, como la mayoría ya lo están haciendo, las herramientas que durante todos estos años han utilizado en su labor de selección y que les han facilitado las organizaciones y empresas que les prestan servicio, y también la Confederación, tanto a nivel de alimentación, de sanidad, de morfología, de genética y genómica, por citar algunos campos. Herramientas que están ahí, que son suyas, como también lo son los últimos programas de Salud podal (ISAP), salud animal (ISA) sin dejar de recordar el programa de acoplamientos ConafeMat o el Servicio Genómico, arma de futuro, hoy ya una realidad, con la que trabajan los ganaderos de selección en el mundo
tercera página
noticias del sector
Jornada Técnica de Producción de Leche de Africor Lugo y la revista Afriga
El pasado mes de marzo la Facultad de Veterinaria de Lugo acogió la novena edición de la Jornada Técnica de Producción de Leche organizada por Africor Lugo y la revista Afriga. En la primera conferencia del día se abordó el cruce industrial de ganado frisón con razas de aptitud cárnica. María Traba, veterinaria de Acruga, resaltó la dificultad de parto, la duración de la gestación y la fertilidad como los tres parámetros fundamentales a tener en cuenta y ofreció las conclusiones de un estudio específico hecho con datos del control lechero de la provincia de Lugo de 2010 a 2014 que sitúan a la raza Rubia Gallega como la más equilibrada para dichos cruces, puesto que sus toros son los más fértiles y posee una facilidad de parto elevada.
A continuación intervino el también veterinario Christoph Egli, director mundial de marketing de Idexx, para presentar una nueva herramienta con la que diagnosticar la preñez de las vacas a partir de una muestra de leche, un servicio que implantó recientemente el Ligal y cuyo objetivo es la mejora de la eficiencia reproductiva. Sirve para detectar las glicoproteínas asociadas a la gestación que se producen a nivel placentario y que aumentan hasta el momento del parto y puede hacerse a los 28 días postinseminación.
Por su parte, Fernando Fariñas, codirector del ImmuneStem de Málaga, explicó en un par de charlas la inmunología en el periparto de la vaca. Comenzó por describir el sistema inmune del animal y el tipo de respuestas de este contra las infecciones para enfatizar que cuando una vaca está gestante, en el denominado periparto, parte de ese sistema está bloqueado y la hace más vulnerable, lo que sumado al estrés fisiológico, a una mala alimentación con un balance energético negativo y a la inmunodepresión en la glándula mamaria va a generar una bajada de defensas que puede desencadenar un aumento de mamitis, metritis y retención de placenta en el posparto. En sus palabras, “los problemas del día a día en el posparto tienen que ver totalmente con el sistema inmunológico” y “el futuro está en el uso de fármacos inmunomoduladores para equilibrar todo este proceso”. Su segunda intervención ahondó precisamente en la inmunomodulación en la mamitis como


medio de prevención de las complicaciones infecciosas secundarias relacionadas con la inmunodepresión. La mesa redonda
El periodista Xoán Ramón Alvite moderó un debate sobre la disponibilidad de tierras para usos agrarios en Galicia en el que participaron Ramón Saavedra (Colegio de Ingenieros Agrónomos de Galicia), Antonio Crespo (Agader), Quico Ónega (Laboratorio del Territorio de la USC) y César Resch (Centro de Investigaciones Agrarias de Mabegondo) y en el que se trataron, entre otros, los siguientes puntos:
-la necesidad de respetar la ordenación para que sean compatibles la producción forestal y la agroganadera, y de canalizar las denuncias de
Ana Morcate directora general de Merial
forma anónima e incluso de “forzar la movilidad” de tierras;
-ya se han dado una serie de pasos, como el Banco de Terras, la Ley de montes o la Ley de mejora de la estructura agraria de Galicia, pero habría que acercar esta legislación a la gente para que se aprovechen mejor estos instrumentos;
-sería interesante cuantificar qué necesidad hay de tierras, en alusión a parcelas que llevan años en el Banco y no han sido solicitadas para uso agrario;
-las leyes en vigor son suficientes pero hay que aplicarlas y dotar de recursos humanos y económicos las herramientas con las que ya se cuenta.
Ana Morcate sustituye a Alberto-Ivo Perello al frente de Merial, la Unidad de Negocio de Salud Animal
Sanofi anuncia el nombramiento de Ana Morcate como nueva directora general de Merial para España y Portugal. Morcate asume el reto de liderar la división de salud animal de Sanofi en estos dos países.


La nueva directora general de Merial Iberia sustituye en el cargo a Albert-Ives Perello, nombrado responsable de Merial para los Mercados Emergentes en Europa, África y Oriente Medio.
Ana Morcate, licenciada en Veterinaria por la Universidad de Zaragoza y con master en Marketing por la Escuela de Negocios ESIC, inició su carrera en Merial en el 2002 como directora de Equino. Desde el 2012 ha ocupado el cargo de directora de Marketing y técnico de Animales de Compañía de Merial. Su fuerte mentalidad estratégica, así como su actitud innovadora serán claves para el crecimiento y desarrollo de Merial en España y Portugal.
Antes de aportar su experiencia al Grupo, Ana Morcate inició su andadura profesional en Norel, empresa de Nutrición Animal entre 1992 y 1996, momento en el que se incorporó a Purina para trabajar en ventas como jefe de Zona y posteriormente como especialista de equino.
El ascenso de Ana Morcate significa también el nombramiento de Enric Valladares como Director de Marketing y Servicios Técnicos de Animales de Compañía Iberia
4 Frisona Española 212 m/a
noticias del sector
La Interprofesional Láctea y Food for Life-Spain, de FIAB, firman un acuerdo para fomentar la investigación y la innovación en el sector lácteo
La cooperación en el desarrollo de actividades de investigación, innovación y desarrollo tecnológico en el sector lácteo es el principal objetivo del Convenio de Colaboración firmado entre la Interprofesional Láctea InLac y la Plataforma Tecnológica Española de los Alimentos Food For Life, gestionada por FIAB. La colaboración entre ambas organizaciones se enmarca en un contexto de liberalización del sector lácteo en el que la valorización de los productos lácteos es un factor clave.
La Interprofesional Láctea tiene entre sus fines promover programas de investigación y desarrollo que impulsen la innovación y la mejora de la calidad en el sector lácteo, así como la creación de productos con mayor valor añadido adaptados a las demandas del mercado. Además del acuerdo firmado con FIAB, InLac celebró recientemente el XXII Foro de Colaboración Público Privada Producción de leche y productos lácteos. Posibilidades, I+D y Cadena Alimentaria junto con el Instituto Nacional de Investigación y Tecnología Agraria y Alimentaria INIA.
Plataforma Tecnológica Food For Life-Spain
Bajo la gestión de FIAB, la Plataforma Tecnológica Food For Life-Spain actúa como punto de encuentro de todos
Nutega, S.L. obtiene la acreditación bajo la Norma ISO 22000:2005
Nutega, fiel a su compromiso con la Calidad y Seguridad Alimentaria, ha obtenido la Certificación según la Norma Internacional ISO 22000:2005. Nutega, como parte integrante de la cadena alimentaria, garantiza la calidad y la inocuidad de sus productos con la implantación conjunta y la certificación de la norma internacional ISO 22000:2005 Sistemas de Gestión de la Inocuidad de los alimentos y el Código europeo de buenas prácticas para explotadores de aditivos y premezclas para la alimentación animal FAMI-QS. El sistema de Gestión de Seguridad Alimentaria de Nutega está certificado por la empresa SGS.
En su misión de ofrecer productos de la más alta calidad e inocuidad, esta empresa fabrica sus productos desde 2007 bajo los estándares de calidad y seguridad alimentaria ISO 9001: 2008 y FAMI-QS. En el año 2015 se añade la norma ISO 22000:2005 Sistema de Gestión de Inocuidad Alimentaria, que viene a reforzar los ideales de servicio y excelencia, y que continuará en constante desarrollo para mantener la mejora continua de la seguridad alimentaria a lo largo de la cadena del suministro de los productos alimenticios.
los que buscan el interés común de fomentar el desarrollo tecnológico y la innovación del sector de alimentación y bebidas. Desde su creación en 2009, la Plataforma ha participado activamente en la promoción de numerosos proyectos de innovación alimentario. Sólo en 2015, se llevaron a cabo más de 100 proyectos a nivel europeo en los que FIAB ha estado presente a través de la Plataforma. Actualmente, Food For Life-Spain cuenta con más de 700 miembros.
InLac
InLac es la interprofesional que engloba a todo el sector lácteo, cuyos miembros representan tanto a la rama de producción –ASAJA, COAG, UPA y Cooperativas Agro-Alimentarias de España- como a la rama transformadora –FENIL y Cooperativas Agro-Alimentarias de España-. InLac es el instrumento vertebrador del sector lácteo cuya misión es representar los intereses comunes de la cadena del sector lácteo de vaca, oveja y cabra; mediante el diseño, el acuerdo y la implantación de medidas vinculantes dirigidas hacia su vertebración y estabilidad sectorial.
1941 – 2016: Syva cumple 75 años
Laboratorios Syva celebra en 2016 sus 75 años de experiencia en investigación, producción y comercialización de medicamentos veterinarios para la prevención y tratamiento de enfermedades en animales. La empresa, creada en 1941 en León y perteneciente al grupo IAPSA (Industrias y Almacenes Pablos), fue pionera en investigación y producción de “Sueros Y VAcunas para ganadería”, que constituye el acrónimo del nombre de la empresa “S.Y.V.A.”. Su primer vademécum ya contaba en los años 40 con más de treinta especialidades inmunológicas contra las enfermedades infecciosas más relevantes del momento; destacando especialmente los sueros contra el virus de la Peste Porcina, el Mal Rojo o la Septicemia Hemorrágica.
La trayectoria de Syva en investigación, desarrollo y fabricación de medicamentos veterinarios, ha conducido a una situación privilegiada de la compañía, tanto dentro como fuera de nuestras fronteras. La compañía mantiene su sede central en León, donde cuenta con unas instalaciones de 12.000 m2 y con una plantilla de más de 200 empleados, 40% de los cuales son titulados universitarios y, entre ellos, 11 doctores.


En la actualidad los productos de Laboratorios Syva combaten y previenen eficazmente las patologías que afectan a la producción ganadera en 75 países a lo largo de cuatro continentes. La empresa está representada en el mercado internacional por dos empresas filiales, IAPSA Portuguesa y SYVA México, y una amplia red de distribución extendida a lo largo del mercado europeo, asiático, Oriente Medio, América Central y Sudamérica. Para celebrar su 75 Aniversario, Syva tiene programadas varias acciones a lo largo de 2016, entre la que se encuentra la inauguración de una nueva planta de productos de Penicilánicos.
m/a 212 Frisona Española 5
noticias del sector
La cooperativa francesa Sodiaal e InLac analizan la situación del sector lácteo
Cerca de una decena de representantes de la cooperativa Sodiaal visitaron Madrid a mediados del mes de marzo, reuniéndose con representantes del sector lácteo de nuestro país para conocer la situación y las gestiones llevadas a cabo en el mismo.
En su encuentro con representantes de InLac trataron sobre la situación actual del sector lácteo en España y Francia, el papel de InLac y el de las asociaciones.
Sodiaal es la primera cooperativa láctea de Francia, la tercera de Europa y la quinta a nivel mun-


Hypred celebra el Starter Day
Uniform-Agri adquiere Repro GTV
El pasado mes de noviembre, la empresa holandesa UniformAgri, especialista en desarrollo de software de gestión de explotaciones de ganado vacuno lechero adquirió Repro GTV, la empresa liderada por el conocido veterinario Joan Galí, experto en la gestión de explotaciones.
Según informa Uniform-Agri, con este acuerdo, Joan Galí se asegura de que sus clientes tengan un buen futuro en lo referente a su software de gestión. Como afirma el director de la compañía holandesa “hemos identificado las funciones espe-


El Uniform-Repro, que se espera esté disponible a principios de verano de 2016, es un programa híbrido que mantendrá todos los beneficios de ambos sistemas de gestión, Repro GTV y Uniform. Los usuarios de Repro GTV podrán acceder al nuevo software siempre y cuando se hayan subscrito al contrato de soporte y mantenimiento anual de Uniform-Agri.
Hypred celebró el pasado mes de febrero en León el Starter Day que contó con la presencia de una parte de los integrantes de la distribución y sirvió como lanzamiento y


todo su potencial genético, a través de un óptimo desarrollo para convertirse pronto en vacas lecheras de élite. El objetivo es incrementar los beneficios y la rentabilidad de las explotaciones lecheras como rige el nuevo lema de Hypred “Your Hygh Performance”
Nueva forma de tratar infección e inflamación
Virbac lanza Curacef Duo, una combinación de antibiótico (ceftiofur 50 mg/ml) y AINE (ketoprofeno 150 mg/ml) en inyectable, para ganado vacuno, que trata y alivia a la vez sin dejar de producir.
Entre las características del producto están la doble acción en una sola inyección; 0 días de tiempo de espera en leche; mayor biodisponibilidad de cada principio activo para una antibioterapia sostenible; recuperación más rápida de los animales con menos dolor y mayor bienestar y excelente tolerancia
6
212 m/a
Frisona Española
noticias del sector
Homenaje de Vicente Bou
El pasado 3 abril durante la 34ª edición de la Fira multisectorial de Primavera de Campllong y dentro del 34º Concurs Morfologic de Raça Frisona de Primavera de la fira de Campllong, los ganaderos de Girona rindieron un homenaje a Vicenç Bou, maestro y amigo ganadero de la ganadería Can Quirch y gran apasionado y entusiasta de la ganadería de selección y los concursos morfológicos. Bou ha sido uno de los grandes impulsores de los concursos morfológicos en Girona, siendo el fundador y gran impulsor de la feria de Campllong, que lleva más de 34 años celebrándose y que ha tenido entre sus actividades, desde el primer año, la realización del concurso morfológico. Vicente ha contribuido al desarrollo de este certamen hasta el día de hoy, con más de 85 años y la ayuda de su familia. El de Campllong es el primer concurso informatizado de España, enviando los resultados a CONAFE a pie de pista y el primero que se juzga en Catalán siempre que haya un juez que se pueda comunicar con dicha lengua.
De los primeros ganaderos catalanes en participar a las escuelas de Jueces con ANFE y más tarde en CONAFE, Vicente Bou no paró hasta conseguir llevar una escuela de jueces nacional a Girona, a mediados de los 80, a la que seguirían dos más.
Durante mucho tiempo fue miembro activo de la Junta
AFRIGI (asossiació frisona de Girona) donde ayudó a crear la asociación y desde donde también organizó varias escuelas de jueces provinciales y concursos locales,


En el centro de la imagen, Vicente Bou recibe el homenaje de sus amigos
convencido desde el primer día de la necesidad de mejorar la morfología de nuestros animales para aumentar la rentabilidad.
Durante toda su vida ha ayudado a los ganaderos jóvenes a seguir en la ganadería de selección, enseñando cuál era el tipo de vaca que había que buscar, y animándoles a formarse y a participar en concursos y escuelas de jueces.
Ganadero pionero, fue de los primeros en usar la inseminación artificial con toros holstein probados americanos y canadienses, en estar en control lechero y calificar vacas, tener cubículos libres, trabajar con nutrólogo, reproductivo, hacer silos, acoplamientos correctivos, usar los índices genéticos, de los primeros en usar novillos en prueba de Aberekin de que AFRIGI es socia, y un largo etcétera.
Motivos más que suficientes para merecer la placa que sus compañeros y amigos le entregaron.
Neiker-Tecnalia ganador del “Premio Isabel Mínguez
Tudela a la Innovación en Sanidad Animal” 2016
La Plataforma Tecnológica Española de Sanidad Animal (Vet+i), a través del tribunal calificador formado por su Consejo Gestor, acordó en su reunión del pasado 5 de abril otorgar a otorgar a Ramón A. Juste Jordán del grupo de investigación del Instituto Vasco de Investigación y Desarrollo Agrario de Neiker-Tecnalia, el “Premio Isabel Mínguez Tudela a la Innovación en Sanidad Animal” en la edición de este año, por el trabajo “El inmunoestimulante frente a la tuberculosis animal: EMDIAR”.
Este trabajo se llevó a cabo con la colaboración del Centro de Vigilancia Sanitaria Veterinaria (VISAVET) de la Universidad Complutense de Madrid y el Grupo de Sanidad y Biotecnología (Grupo SaBio), integrado en el Instituto de Investigación en Recursos Cinegéticos IREC (CSIC-UCLMJCCM).
El premio se entregará el próximo 1 de junio en Madrid en el transcurso de la VIII Conferencia Anual de la Plataforma Tecnológica Española de Sanidad Animal, que este año tratará sobre “La innovación como clave para el futuro de la sanidad animal”, que permitirá analizar y poner en
valor la importancia de la innovación en la mejora de la sanidad animal y por ende de la sostenibilidad, el medio ambiente y la situación socioeconómica del sector agroganadero.
Tras el fallo, el Consejo Gestor expresó su felicitación a los premiados y agradeció a todos los organismos públicos de investigación y grupos de investigación de las universidades su participación en esta convocatoria, al mismo tiempo que mostró su satisfac-
ción por la alta calidad de los trabajos presentados.
El premio, creado por Vet+i para honrar la memoria de la doctora Mínguez Tudela por su decisivo apoyo a la creación del sistema de plataformas tecnológicas de la Unión Europea, así como su gran labor de investigación en el campo de la sanidad animal en la Comisión Europea, tiene como objetivo reconocer, incentivar y promover una I+D+i en sanidad animal que se traduzca en la promoción de la competitividad, la internacionalización, el crecimiento económico y la creación de empleo.
Calendario

Mayo:
7 Subasta de ganado Frisón. Mercado ganadero de Sarriá (Lugo)
7/8 Concurso Morfológico de Ganado Vacuno Frisón de Mallorca Campos (Mallorca). Juez de CONAFE: Conrado González Antón
10 Livestock Forum. Fira de Barcelona, Recinto Gran Vía
11/13 XXI Congreso Internacional ANEMBE de Medicina Bovina Santiago de Compostela
Junio:
8-12 Feria Internacional Abanca - Semana Verde de Galicia Silleda (Pontevedra): IX Concurso de Xóvenes Preparadores; XXV Concurso Autonómico FEFRIGA'16; XXXII Concurso Internacional de Xóvenes Manexadores "Memorial Luis Louzao"
11 38º Concurso Regional de Raza Frisona de Asturias Recinto Feria de Muestras de Asturias "Luis Adaro". Gijón.
14/19 Confrontación Holstein Europea. Colmar (Francia)
m/a 212 Frisona Española 7

Coma 118 Sid. Vaca Gran Campeona FEFRIC-16
Incluido en la programación del tradicional Mercat del Ram que anualmente viene celebrándose en la ciudad de Vic (Barcelona), se celebró, el pasado19 de marzo, el 19º Concurso Cata-
lán de la Raza Frisona FEFRIC-16.
El concurso está organizado por FEFRIC, la Concejalía de Ferias y Mercados del Ayuntamiento de Vic, el Departamento de Agricultura, Ganadería, Pesca

y Alimentación de la Generalitat de Cataluña, contando con el patrocinio de Provetsa y la Cooperativa Plana de Vic, además de numerosas empresas colaboradoras del sector lácteo.
La participación, muy numerosa, alcanzó los noventa animales pertenecientes a ganaderías de las Asociaciones Frisonas de Terres de Ponent, del Alt Urgell i Cerdanya, de Girona, de Osona y del Valles.
El concurso fue juzgado por el juez italiano Primo Betti, juez de la Asociación Frisona Italiana, ANAFI, que contó con la colaboración de Toni Garcia.


Está edición tuvo la particularidad de que el juzgamiento se hizo el sábado Soca


118 SId - Cal Soca Vaca Gran Campeona de Cataluña FEFRIC
2016,
8 Frisona Española 212 m/a
FEFRIC-16
19º Concurso Catalán
El concurso retorna al Mercat
El juez del concurso con Toni García

Cuadro de Honor
Ternera Campeona
Campgran Irlanda Delta - El Campgran
Ternera Subcampeona

DI.Doly 391 Durbin- Cal Diligent
Novilla Campeona
Campgran Rosanna Atwood - El Campgran
Novilla Subcampeona
Clota Atwood 3 Sirena - La Clota
Novilla Gran Campeona de Cataluña
Campgran Rosanna Atwood - El Campgran
Vaca Joven Campeona
Comas Novas Adrirose Goldsun - Cal Marquet
Vaca Joven Subcampeona
Pol Santana Aleluya - Can Pol
Vaca Campeona
Soca 118 SId - Can Soca
Concurso
19º
Vaca Subcampeona
Duf Golf - Can Soca
Vaca Gran Campeona de Cataluña
Soca 118 SId - Can Soca


Mejor Sistema Mamario de Cataluña
Soca 118 SId - Can Soca
Mejor Rebaño de Cataluña: Cal Marquet
Segundo Mejor Rebaño de Cataluña:
Can Soca
Mejor Criador de Cataluña: Cal Marquet
Segundo Mejor Criador de Cataluña:
Can Soca
Mejor Lote por Asociación: AFO
Segundo Mejor Lote por Asociación: AFAUC



m/a 212 Frisona Española 9
Ternera Campeona
Vaca Joven Campeona
Catalán Fefric’16 del Ram
Novilla Campeona








ganadería Can Soca fue la primera que colocó el juez por delante Di.Kalia 432 Mc Kayne de Cal Diligent, por su fortaleza, carácter lechero y abertura de costilla.
En la segunda sección terneras de 6 a 9 meses, Campgran Irlanda Delta de la ganadería El Campgran, fue la que ocupó la primera posición. Una ternera alta y larga con muy buenas patas posteriores, por delante de la ternera de la ganadería Marí, Mari Lockerley Careta 230. Irlanda sería elegida por Primo Betti, Ternera Campeona del concurso.
De la sección tercera, terneras de 10 a 12 meses, saldría la Ternera Subcampeona, DI.Doly 391 Durbin, de la ganadería Cal Diligent, su estilo, abertura de costilla, fortaleza y línea dorso lumbar, la definían, según explicó el juez. La ternera de Can Pou, Pou Titi Mccutchen, fue segunda de esta sección.
Las secciones de terneras acabaron con Marquet Jayma Delta ocupando la primera posición de la sección cuarta. Una ternera de 15 meses, de la ganadería Cal Marquet, sobresaliente por la calidad de su esqueleto en general, destacando la abertura de costilla y la calidad de su grupa. Marquet Kisa Explode fue segunda.
Esta ganadería de AFAUC, volvería a estar en primera posición en la sección sexta de novillas de 16 a 20 meses con Marquet Jaira Delete por delante de Campgran Lisboa Maccutchen de El Campgran.
Las dos primeras colocadas en la sección séptima, novillas de 21 a 26 meses serían también la Novilla Campeona y Subcampeona FEFRIC-16, hablamos de Campgran Rosanna Atwood de la ganadería El Campgran y de Clota Atwood Sirena de la ganadería La Clota. El carácter lechero de la novilla de Pol Collell, propietario de El Campgran, unido al equilibrio que presentaba en todas sus partes, la llevaron, también, a ser elegida por el juez italiano como Gran Campeona de Cataluña FEFRIC-16(Terneras y Novillas)
Antes de proceder al juzgamiento de las vacas de leche, salieron a pista los jóvenes, muy jóvenes, representantes de varias de las ganaderías que acudieron al concurso, demostrando, pese a sus pocos años, su cariño por sus animales y el buen hacer. El púbico no pudo por menos que reconocerlo con una gran ovación.
A continuación se juzgó la sección de vacas jóvenes con la elección de Vaca Joven Campeona y Subcampeona. Comas Novas Adrirose Goldsun, de la ganadería Cal Marquet, fue la campeona por su altura, abertura de costilla y el sistema mamario que presentaba, con un ligamento suspensor fuerte y muy marcado. La Vaca Joven Subcampeona fue Pol Santana Aleluya de la ganadería Can Pol.
En la sección de vacas jóvenes en lactación de tres años, juzgada a continuación, estaba la Vaca Campeona y y Vaca Gran Campeona del concurso, Soca 118 Sid de la
1. DI. Doly 391 Durbin Ternera Subcampeona
2. Clota Atwood 3 Sirena, Novilla Subcampeona
3. Soca 212 Alex, 1ª clasificada de la sección primera de terneras.
4. Marquet Jayma Delta. 1ª Sección 4ª Terneras de 13 a 15 meses.
5. Marquet Jaira Delete. 1ª Sección 6ª Novillas de 16 a 20 meses


1 2 3 4 5
Novilla Subcampeona
Ternera Subcampeona


ganadería Can Soca, un animal muy equilibrado, largo y profundo, con un magnífico sistema mamario, destacando la colocación de los pezones.
Soca se impuso en el Campeonato de Vacas a su compañera de establo, Duf Golf, primera de la sección de vacas en lactación de 4 años, que sería la Vaca Subcampeona.
En la última sección saldrían a pista los animales más adultos, para deleite del juez y del público. Primo Betti, les invitó a que disfrutaran de
tregaron los premios al Mejor Criador y Mejor Rebaño de Cataluña FEFRIC-16, que recayeron en las ganaderías Cal Marquet (AFAUC), Mejor Criador y Mejor Rebaño y Can Soca (AFO) Segundo Mejor Criador y Segundo Mejor Rebaño.
Como Mejor Lote por Asociación el juez colocó al presentado por la Asociación Frisona de Osona (AFO), mejores patas, altura y ubres, por delante del lote de la Asociación Frisona del Alt Urgell i Cerdanya (AFAUC).

Para terminar, destacar el muy merecido homenaje que se rindió a la ganadería S.A.T. 708 Can Pol de Girona y a su vaca Coromines Dupley , calificada seis veces excelente.
A la Izquierda, la Alcaldesa de Vic Anna Erra y la Consellera de DARP, Meritxell Serret. Bejamì Dòniga, Tte. Alcalde de Vic con el juez y los propietarios de Can Soca.

Mejor Criador y Se-


 Duf Golf
Duf Golf
m/a 212 Frisona Española 11
Subcampeona
Marquet Favorita Knowlwdge. 1ª Vaca adulta lactación 5 años o más
Vaca










Jóvenes Manejadores ¡¡¡Bravo campeones!!!

Gina Eroles (Cal Marquet)
Carla Marí y Biel Quirze (Ramaderia Marí) Pol y Abril Sabrià (Can Pou)
Mercè Esquerrè (La Clota)
David Solè • Lleò Poch • Sergi Gosa
Sección 1. Terneras de 0 a 5 mesos
Pol Santana Aleluya Vaca Joven Subcampeona de Cataluña FEFRIC 2016.
Resultados del 19º Concurso Catalán FEFRIC 2016

1 Soca 212 Alex Can Soca (AFO)
2 DI.Kalia 432 MC Kayne Cal Diligent (AFAUC)
3 Pou Julia MC Kayne Can Pou (AFRIGI)
Sección 2. Terneras de 6 a 9 meses
1 Campgran Irlanda Delta EL Campgran (AFO)
2 Mari Lockerley Careta 230 Ramaderia Marí (AFTP)
3 Pou Lluna Blava Mccutchen Can Pou (AFRIGI)
Sección 3. Terneras de 10 a 12 meses
1 DI.Doly 391 Durbin Cal Diligent (AFAUC)
2 Pou Titi Mccutchen Can Pou (AFRIGI)
3 Campgran Diana Delta EL Campgran (AFO)
Sección 4. Terneras de 13 a 15 meses
1 Marquet Jayma Delta Cal Marquet (AFAUC)
2 Marquet Kisa Explode Cal Marquet (AFAUC)
3 DI.Bea 412 Liquid Gold Cal Diligent (AFAUC)
Sección 6. Novillas de 16 a 20 meses
1 Marquet Jaira Delete Cal Marquet (AFAUC)
2 Campgran Lisboa Mccutchen EL Campgran (AFO)
3 Galabert Meridian 3232 ET Cal Galabert (AFAUC)
Sección 7. Novillas de 21 a 26 meses
Clota Atwood 3 Sirena Novilla Subcampeona de Cataluña FEFRIC 2016.

1 Campgran Rosanna Atwood EL Campgran (AFO)
2 Clota atwood 3 Sirena La Clota (AFAUC)
3 Campgran Dublin Brady EL Campgran (AFO)
Sección 10. Vaca joven lact. hsata 30 meses
1 Comas Novas Adrirose Goldsun Cal Marquet (AFAUC)
2 Pol Santana Aleluya Can Pol (AFRIGI)
3 Txel-Palou Macaralleta ATW Mas Palou (Caramatxel)AFO
Sección 13. Vacas en lactación 3 años
1 Soca 118 Sid Can Soca (AFO)
2 Marquet Hilaria Goldsun Cal Marquet (AFAUC)
3 Soca 185 Yorick Can Soca (AFO)
Sección 14. Vaca en lactación 4 años
1 Duf Golf Can Soca (AFO)
2 Soca 121 Goldsun Can Soca (AFO)
3 La Borda Xacobeo 148-196 La Borda (AFAUC)
Sección 15. Vaca adulta lactación 5 años o más
1 Marquet Favorita Knowledge Cal Marquet (AFAUC)
2 Mijaqui Dorisa Pronto ET Cal Marquet (AFAUC)
3 Regalao Goldwyn Isabel Ramaderia Marí (AFTP)
II Curso de Podología


Curso de dos días de duración destinado a profesionales de la podología

Candás (Asturias) 22 y 23 de septiembre de 2016
El programa de recogida de información de salud podal para la prevención y el control de cojeras en las ganaderías de vacuno de leche (I-SAP) cumple cinco años. En la actualidad tenemos información sobre salud podal de más del 35% de las vacas en control lechero. Más de 1.500 ganaderos tienen toda la información registrada de las actuaciones de sus podólogos de referencia en sus granjas y todo el historial de salud podal de sus vacas disponible para cualquier consulta.
Un éxito rotundo que se debe en gran parte al compromiso incondicional de todos los podólogos adheridos al programa, liderados por ANKA y SERAGRO.
En estrecha colaboración con ANKA, SERAGRO y la Facultad de Veterinaria de la Universidad Complutense de Madrid, CONAFE organiza el próximo otoño el II Curso de Podología y la V Unificación de Criterios entre Podólogos. Para ello, con el patrocinio de ZOETIS, hemos invitado al Dr. Johann Kofler, del Hospital Clínico de la Facultad de Veterinaria de la Universidad de Viena, especialista de reconocido prestigio internacional en salud podal bovina y miembro muy activo en el grupo de trabajo de ICAR sobre salud podal.
El objetivo de esta edición del curso de podología es combinar el aprendizaje y la unificación de criterios entre los profesionales que se dedican a la podología. Por ello, las metas son:
• Una aproximación a la podología a nivel internacional.
• La unificación de criterios a través de la formación y el reciclaje de los podólogos participantes en la recogida de información de salud podal.
•La introducción de nuevos profesionales al programa.


Precio de inscripción:







* Comprende: Curso, alojamiento 2 días en habitación doble, almuerzos y cenas.
- Alojamiento en habitación individual, suplemento de 14 €.
- Días adicionales de hotel, consultar precios y disponibilidad en CONAFE.
Plazas limitadas Información e inscripciones en CONAFE Tlf.: 91 895 24 12 conafe@conafe.com

Subasta de Chantada
Remitido.- En la edición de este año de la subasta de ganado frisón de Chantada (Lugo) se alcanzó un volumen total de ventas superior a los 26.000 euros.
En esta subasta se presentaron quince animales, de los que trece eran vacas paridas, lo que motivó que los precios tuvieran un cierto repunte respecto de la subasta anterior, donde predominaron las novillas próximas al parto.
El precio medio fue de 2.031 €, con un volumen total de ventas de 26.400 €. Tan solo dos animales quedaron sin vender.
La buena climatología y la coincidencia de esta subasta con la Feria del Vino de Chantada favoreció la asistencia de mucho público. Los compradores procedían de Pontevedra, Asturias y Lugo.
El animal que alcanzó el precio más alto fue la primeriza que presentó la ganadería Josmar, de Baralla, que llegó a los 2.650 €. Se trata de una hija de Epic, con madre Xacobeo, parida de enero. Tiene una calificación de 82 puntos y un ICO de 2.911, lo que hace que esté considerada como una vaca de alto valor genético.
30º Concurso morfológico de ganado vacuno frisón de Menorca
Como ya sucediera en la edición de 2015, Algendar Goldwyn Jara, que fuera también Vaca Gran Campeona Nacional de Primavera CONAFE’15, fue la Vaca Gran Campeona del treinta concurso morfológico de ganado frisón de Menorca.
Javier Freije, Juez de CONAFE, designado para juzgar dicho concurso lo tuvo claro ante la estructura lechera, capacidad y sistema mamario de esta vaca adulta propiedad de la ganadería Algendar D’en Gomila de Mahón.
Pero vayamos a las primeras secciones del concurso donde la ternera
Los días 19 y 20 de marzo se celebró en Alaior (Menorca) el 30º Concurso de ganado vacuno frisón de Menorca, juzgado por el Juez de CONAFE, Francisco Javier Freije
juzgaron a continuación resultó finalmente campeona la novilla de la ganadería Alcaidus Den Fabregas de Alaior, Alcai Outbound Ruleta, por delante de Son Quart Delete Jeyn de la ganadería Son Cuart de Ciutadella. La Ruleta, sería elegida por el juez como Novilla Gran Campeona del concurso.

El primer campeonato de las vacas de leche, el de Vaca Joven CampeBinillubet Atwood Trave, de la ganadería Binillobet de Es Mercadal. Como subcampona quedó
la vaca de la ganadería Binisegui Vell, Binisegui Vell Crack Gracia, también de Es Mercadal.
En el campeonato de Vacas Intermedias Lactación, se cambiaron las tornas y Binisegui Vell con su animal Binisegui Vell Shottle Eva, quedó está vez por delante Binillubet, llevándose el campeonato. Binillubet Goldwyn Dora fue la Vaca Intermedia Subcampeona.
En vacas adultas Jara fue la campeona por delante de Binisegui Vell Bolton Crack
En cuanto a grupos Algendar D’en Golima fue el Mejor Rebaño, mientras
 Algendar Goldwyn Jara, Vaca Gran Campeona y Alcai Outbound Ruleta, Novilla Gran Campeona de Menorca 2016
Algendar Goldwyn Jara, Vaca Gran Campeona y Alcai Outbound Ruleta, Novilla Gran Campeona de Menorca 2016
oncursoexposiciones
oncursoexposicio
Subasta de uno de los lotes de la subasta
subastasferiasconcursoexposicionessubastasferiasc
14 Frisona Española 212 m/a
30º Concurso de ganado frisón de Moexmu
El día 2 de abril se celebró en Muimenta (Cospeito) Lugo, el 30º Concurso de ganado frisón de Moexmu, juzgado por el Juez de CONAFE, Pol Collell
Remitido.-En estaedición el Concurso de Moexmu tuvo mucha participación, con ganaderías de Lugo, Pontevedra y A Coruña. De igual forma, los premios estuvieron muy repartidos, donde 6 de las 18 ganaderías participantes obtuvieron un primer premio de sección.
En las secciones de terneras, dominó la ganadería Carro, con la campeona y subcampeona. En ambos casos fueron claras ganadoras de sus respectivas secciones, por su mayor fortaleza y mejor unidas en todas sus partes. En el campeonato se impuso la Aikman sobre la McCutchen por sus mejores patas.
En novillas, la campeona y subcampeona compitieron en la misma sección, imponiéndose la Doorman de Pozo sobre la Atwood de Rey de Miñotelo, por ser un animal más estiloso, más largo y con mejor lomo.
El gran campeonato fue para el animal más joven, imponiéndose la ternera de Carro principalmente por sus mejores patas.
En la sesión de tarde, hubo unas secciones espectaculares de vacas, con una preparación exquisita, notándose la presencia en el concurso de


547 Sonrrisa CId, Vaca Gran Campeona
años consecutivos como mejor vaca del concurso, no siendo frecuente que una vaca esté en forma tres años seguidos, lo que dice mucho de su criador, con tres jueces distintos y que no se presente otra vaca que la supere.
De la vaca joven campeona, el juez, Pol Collel, resaltó que representa lo que se busca en una vaca joven.
Así, Pozo Atwood Tamara, destacó por su sistema mamario y carácter lechero.
Cid, Mejor Rebaño y Mejor Criador
Las ganaderías Manteiga, Pozo, Cid y Rey de Miñotelo fueron las que consiguieron llegar a los campeonatos. Rey Sonrisa Sid, a pesar de estar pa-

En intermedias, la Sid de Miñotelo se impuso claramente a la Sid de Pozo, por su tremenda estructura lechera, a pesar del buen sistema mamario de la de Pozo.
En adultas, la ganadería Cid no tuvo rival, obteniendo el campeonato y subcampeonato, destacando la Goldwyn por su calidad de hueso y estructura.
El mejor Criador y Mejor Rebaño fue para Gandeiria Cid, con un grupo de vacas adultas muy homogéneo. El premio a la mejor ganadería de nueva participación fue para la ganadería A Campa, de Curtis.
Subasta Moexmu
En la subasta Moexmu 2016 participaron trece animales, de los que se vendieron once, con un precio medio de venta de 1.780€.
El animal que alcanzó el precio más alto fue para una hija de Larson presentada por la ganadería Josmar, de Baralla. Una primeriza, parida de febrero, con madre Landoi, muy productora, con más de 99.000 quilos de leche producidos en 6 lactaciones, que se vendió en 2.150 €.
Incluyendo los animales presentados por la Granxa Gayoso Castro, el volumen de ventas total alcanzó los 16.150€. Los compradores vinieron de Lugo, Pontevedra y Asturias.
oncursoexposicionessubastasferias oncursoexposicio
Casa-Nova Vanesa Aikman ET, Gran Campeona de Novillas con el Juez
Rey
m/a 212 Frisona Española 15

Pebi Green de Can Pol y la subcampeona 282 Raset Anita Richman de la ganadería Can Raset.
La Green de Can Pol fue finalmente distinguida por Jordi Juanola como Vaca Gran Campeona Campllong 2016,
El premio al mejor sistema mamario recayó en la vaca 282 Raset Anita Richman de Can Raset.
Mejores Criadores del concurso fueron las ganaderías SAT Can Pol y Can Raset, respectivamente.
Francés Raset y Abril Sabrià, fueron los mejores manejadores adulto y joven respectivamente.
Subasta de Boimorto
3ª Subasta de Novillas de Raza Frisona de Boimorto (A Coruña)
Concurso celebrado el día 3 de abril en Campllong (Girona), juzgado por el juez de Conafe, Jordi Juanola
En la Carpa de Ganadería de la Fira de Primavera de Campllong, se celebró el día 3 de abril el 34º Concurso Morfológico de la Raza Frisona actuando como juez de CONAFE Jordi Juanola.
El concurso está organizado por Comisión de Ferias del Ayuntamiento de Campllong, contando con la colaboración del DARA, y las organizaciones ganaderas Semega, Afrigi, Avagi, Aftp y Afv
Empezando por los animales más
jóvenes destacar a las dos terneras campeonas: Pou Lluna Blava McCutchen de Can Pou (Campeona) y Feli Manifold 103 de Can Feliu (Subcampeona). La ternera de Quim Sabriá sería elegida por Juanola como Gran Campeona de Terneras y Novillas, compitiendo con Batllori 817 Maserati, de Mas Batllori, que fue la Novilla Campeona. Pol Es Mandalay Natza de Can Pol sería la Novilla Subcampeona.
Antes del juzgamiento de las vacas en lactación, salieron a pista trece futuros ganaderos, niños y niñas de distintas edades y ganaderías participantes en el concurso.
Siguiendo con el concurso, el primer campeonato de vacas jóvenes fue para Gel 791 Doorman Lomana de la ganadería Can Gel por delante de Pol Santana Aleluya de Can Pol.
Remitido.- La tercera edición de la Subasta de Novillas de Raza Frisona de Boimorto, se celebró el pasado 20 de marzo coincidiendo con MAGRECO, una feria que acoge varias actividades entre las que destacan la exposición de maquinaria agrícola y forestal.
Este año, la maquinaria estuvo acompañada de un stand con exposición de productos lácteos, que esperemos que sirva para promocionar un sector que debido a los bajos precios de la leche, atraviesa por una delicada situación.
Participaron en la subasta 7 novillas; siendo vendidas todas ellas a un precio medio de 1.993 €. Una media de 254 € menos, que la celebrada en este recinto en 2015. El total de ventas de la subasta alcanzó los 13.959 €.
En vacas adultas la campeona fue


oncursoexposicionessubastasferiasconcursoexposicionessubastasferiasconcursoexposicio
Pebi Green, Gran Campeona del concurso
Pou Lluna Blava McCutchen, Gran Campeona (Terneras y Novillas)Ferreiro Torrel 6873
16 Frisona Española 212 m/a

Los Huertos de Aldeanueva, en Aldeanueva de Barbarroya (Toledo), entró en CONAFE hace más de quince años, con José Manuel Fernández al frente. Hoy, puede estar doblemente satisfecho por la explotación que ha conseguido y, sobre todo, porque tiene asegurada la continuidad con sus hijos Alberto, que se incorporó en 2007, y Daniel, que lo hizo hace cinco años.
Los tres nos cuentan cómo ha sido y cómo es su explotación.

Los Huertos de Aldeanueva
Ser
Aunque la ganadería entró en Africama y CONAFE en 1999, José Manuel y su familia han estado toda la vida con vacas. “Antes, recuerda, teníamos las vacas en las casas; luego con mi madre y otros dos hermanos hicimos una vaquería. Posteriormente aquello lo repartimos entre los tres hermanos. Yo empecé edificar aquí en 1984 más o menos y seguí yo solo hasta que se incorporaron mis hijos”.
Estos son los inicios de Los Huertos de Aldeanueva, muy parecidos a los de muchísimos ganaderos que comenzaron con veinte o treinta vacas y hoy día ordeñan, con José Manuel y sus hijos, más de 160.
“Al principio eran unas 30, luego, después de comprar la parte de un

eficiente y hacer leche
hermano, unas 50 o 60. En 2006 hicimos un vacío sanitario por tuberculina y luego ya pudimos arrancar para ir creciendo poco a poco. Ahora en ordeño hay 160 y 170 entre recría y vacas secas”
¿Habéis puesto tope para crecer? No, de momento el tope es el mercado. La verdad que en el ultimo año hemos crecido bastante; y ahora mismo hay bastante recría y el crecimiento será mayor. Cuando pase el verano nos vamos a poner en unas 200 en ordeño. Ahora estamos haciendo casi 6.000 litros diarios.
Con este aumento de la producción ¿estáis teniendo problemas para colocar la leche?
Por ahora no. Entregamos a Schreiber Foods España. Estamos cobrando 31 céntimos de precio base; pero tenemos el precio indexado (índice A). Esto significa que tenemos un precio base y cada tres meses se va ajustando por arriba o por abajo, con un contrato indefinido a título individual.
¿Qué os hizo dar el paso de entrar en la asociación?
Por tener las vacas en control lechero, tener registros de las células, etc. Antes solo teníamos datos de las inseminaciones y los partos. También se hacen los acoplamientos, con el programa de Aberekin.
También hay un programa de calidad de leche, aunque nosotros no estamos en él.
de
18 Frisona Española 212 m/a

calidad. Es lo que queda.
¿Tenéis que pagar el control lechero?
Sí, 12 euros por vaca y año. Aunque hay trimestres que con los beneficios de los servicios que presta Africama, como la venta de semen, se repercute en el ganadero y no tenemos que pagar.
¿Habéis hecho transferencia de embriones?
Sí, una vez hicimos y salió bien, pero solo quedó una vaca muy buena que tenemos “Los Huertos Windbrook Lautinia ET” MB-86 en primer parto y que fue número 3 en IGT en la evaluación de julio de 2015. Lo hicimos con el programa que tenía Africama, pero luego no hemos vuelto a hacer.
Son Alberto y Daniel quienes eligen los
toros ¿cuáles estáis utilizando? Diego Jerónimo de Africama nos ayuda muchísimo en el asesoramiento y selección de toros, confiamos mucho en él... sabe muchísimo de genética.
Los nacimientos de 2015 han sido con Mccutchen, Meridian, Gifian, Saloon, Super y Dorcy. Los nacimientos y gestaciones de 2016 son de Mccutchen, Meridian, Envious, Monterrey, Beemer (sexado), Kingboy, Capital Gain, Atwood y Let it Snow.
Con Beemer tenemos preñadas unas 20 novillas. El semen sexado merece la pena pese al precio; lo usamos con las novillas, que son las que mejor genética tienen y con las que más se progresa, además que la fertilidad es mejor.
En general, afirman, usamos toros


buenos, aunque en verano usamos alguno más barato porque preñan peor, baja mucho la fertilidad… Este año a ver qué tal va, con los nuevos ventiladores y los difusores de agua.
¿Habéis genotipado novillas? Sí, hemos genotipado la que hemos mencionado del trasplante de embrio-
• m/a 212 Frisona Española 19
José Manuel Fernández y sus hijos Daniel y Aldeanueva de Barbarroya
Toledo

Vacas

Días a 1ª IA.................................82
Fertilidad a 1ª IA......................37%
Fertilidad general....................31%
Fertilidad 1º parto...................38%
Fertilidad 1ª IA primíparas......49%
Tasa de preñez 21 días...........16%
% gestantes.............................53%
Intervalo parto-fecundación..191
Nº IA por preñez......................2,92


nes y una hija suya con Doorman. ¿Genotipar más? Pues no sabemos… Yo creo que al final todas tendrán que ser así, nos dice Alberto.
El futuro parece que va muy encaminado a la genómica, teniendo todos los animales de la granja genotipados la selección y la evolución genética será mucho mayor. Y a la hora de decidir con qué animales usar sexado y de qué animales no dejar descendencia, será fundamental. La genómica es interesante.
La ampliación de instalaciones ¿la hicisteis al entrar vosotros?
No, hemos ido ampliando según nos hacía falta. Yo me incorporé, cuenta Alberto, cuando compramos las vacas después del vacío sanitario. Antes las vacas estaban en cama caliente y entonces empezamos a adaptar algunas naves a cubículos.
empresa Alpavet; reproducción, alimentación, clínica, diseño de las naves, manejo de las terneras… todo!! es un crack. Y tiene un equipo muy bueno y profesional.
La ganadería cambió un montón cuando entro él de veterinario; cambiamos totalmente como ganadería y como ganaderos. Hay un antes y un despué desde que trabajamos con él; se preocupa mucho de las cosas y hace que nos involucremos mucho en todo.
La revisión de podología la hacemos con un podólogo de la zona, Fernando, cuando hay vacas que la necesiten.
Tasa de eliminación...............13%
Tasa de reposición..................34%
Media prod. vitalicia, kg.....34.740
Media calificación.....................81
Media ICO (nov.’15)............+2198 (Castilla-La Mancha: +1963; Estatal: +1891)
Medias producción



Ahora tenemos todas las vacas con cubículos y cama de arena. Las vacas en producción están separadas en primíparas y multíparas; preparto está aparte con cama caliente y cubículos de arena; secas y novillas preñadas de 7 meses, también también en cubículos con arena. Luego, las novillas y terneras están todas en lotes por edades con cama caliente todas.
¿Quién lleva el control reproductivo, clínica, nutrición…?
Lo lleva todo Juan José Vizuete, de la
¿Ha subido mucho la producción de las vacas con Juan José Vizuete? Sí subió mucho, pero no solo la producción sino todo, fertilidad, mejoró mucho la salud, se redujeron mucho las bajas…
Pero ya llevamos bastantes años con él y todo a cambiado muchísimo. Ya no son las vacas que eran cuando él entró, ni el manejo, ni instalaciones...
¿Tenéis terreno para cultivo?
La Ración




Ración vacas en lactación:
Silo maíz: 28 kg
Silo raigrás: 13 kg
Heno de avena: 1,2 kg
Melaza de remolacha: 1,4 kg
Pienso: 9,9 kg

¿Cuál es la ración base para las vacas

Producción 2015 kg................36,9 Nº vacas ordeño.....................152 Nº vacas presentes.................173 % vacas secas......................12,1% Nº partos medios......................2,3 DEL............................................194 % grasa....................................3,66 % proteína................................3,30 CCS...........................................132 Bacteriología..............................21
20 Frisona Española 212 m/a



Silo de raigrás, silo de maíz, pienso, melaza y heno. La ración normalmente es igual todo el año; puede variar algo de invierno a verano, dependiendo de cómo tengamos los silos, pero sin cambios drásticos.
¿Y para secas y novillas?
Las terneras están en las casetas individuales hasta que se destetan comiendo 1,5 kg de starter. Luego pasan a una caseta colectiva, donde están un mes más o menos hasta que tienen tres meses y medio comiendo el mismo pienso starter y heno. De ahí pasan a las naves y siguen comiendo lo mismo hasta que tienen 5 meses y pasan a comer comida de las vacas de producción y heno y a los 9 meses se quedan con heno a discreción y 2,5 kg de soja con corrector. Luego pasan a heno, paja y 2,5 kg del mismo pienso hasta que los 7 meses de gestación que pasan con las vacas secas.
¿Cuántas veces se distribuye la rción? A las vacas secas, preparto y vacas de ordeño, les damos la ración una vez al día, que se hace con el carro. A las terneras sí que se las echa de comer dos veces al día. Se prepara un carro para

Meses a 1ª IA..........................


Novillas



15,5 Edad a IA fecundante...........16,2
Fertilidad
73% Fertilidad general....................64% % gestantes.............................33% Nº IA por preñez........................1,5 Abortos......................................3% IA semen sexado....................45% IA semen convencional.........66% Fertilidad semen sexado...........80 Fertilidad s. convencional......63%
Edad prevista al parto............25,2
a 1ª IA......................
m/a 212 Frisona Española 21
Sala de ordeño Alfa-Laval de 2 x 8
las novillas primerizas y otro para las vacas, pero porque no entra toda la ración en el carro unifeed, no es por otra cosa, porque es la misma ración. Y otra ración se prepara para las vacas secas y preparto.
¿Participáis en concursos?
Sí, participamos en el de Talavera, en el Open del año pasado, y conseguimos cuatro banderines con cinco animales que llevamos. También ese año llevamos una vaca al nacional a Gijón.
¿Os gustan los concursos?
¿Le dais importancia a la morfología?
Sí, por lo que hablamos. Que nos gustan las vacas buenas, grandes y con buenas patas y ubres... Eso sí, siempre sin descuidar la producción.
¿Cuántos partos tenéis de media?
Estaremos en dos partos y medio.
¿Consideráis que es buena?

es por infertilidad y algún accidente ya




Daniel y Alberto trabajan en la ganadería por vocación. “Y para mí, reconoce José Manuel, eso es una satisfacción enorme”
22 Frisona Española 212 m/a
En estos momentos, con el exceso de de leche en el mercado, hay explotaciones en las que han dejado de recoger la leche y otras a las que han pedido que reduzcan la producción.
¿Os han dicho algo en este sentido,
con calidad, para poder competir, ofrecer algo para que quieran tu leche. Nosotros estamos en un programa de granjas certificadas y bueno, aparte del poquito que cobras más, pues das un producto con una
¿Qué opináis de la finalización del sistema de cuotas? ¿era necesario, conveniente?
¿Os penalizan si bajáis de los unos índi-


Tenía sus pros y sus contras como por ejemplo, que había muchísima especulación con el tema de compraventa y alquileres, lo que es una pena es la pérdida tan grande de patrimonio que sufrimos al eliminar las cuotas.
En realidad las cuotas siguen igual, aunque ahora en lugar del ministerio te la marcan las industrias o la situación del mercado. No sabemos qué es mejor, igual es mejor ésto… el tiempo lo dirá.
Nosotros ahora tenemos más del doble de leche que teníamos con el sistema de cuotas. El último año del sistema tuvimos que alquilar un montón de litros, porque nos pasábamos mucho ya.
¿Ahora estáis produciendo esta cantidad?


Sí, las previsiones son de más de dos millones de litros para este año. Si se puede y el mercado nos lo permite queremos crecer todavía otro poco.
La idea es crecer un poco más en numero de vacas y hacer tres ordeños. Pero todo poco a poco, que según está la situación ahora hay que tener mucho cuidado.
¿Cuántas ganaderías estáis produciendo leche en el pueblo?
En estos momentos recogen leche a siete ganaderías, de las cuales cuatro estamos en CONAFE.
De cara al futuro ¿qué herramienta tiene el ganadero para seguir en la actividad?
Sobre todo ser eficientes y hacer leche de muchísima calidad. Leche con solidos que le es muy interesante a la industria y no ser problemáticos con bacterias, células, inhibridores…
Y aparte, no parar de invertir y de mejorar, porque si te paras no avanzas y cuando te das cuenta no eres capaz de volver a reengancharte.
¿Sois optimistas de cara al futuro?
Yo creo que siempre ha habido sus altas y sus bajas, afirma José Manuel.
Las cosas van saliendo, lo que hay que hacer es estar, aguantar y trabajar mucho. La vaca de leche es muy esclava, pero si te gusta trabajar con ellas te dan muchas satisfacciones y alegrías.
De las cosas complicadas es de las puedes sacar algo, porque las fáciles lo son para todo el mundo.
De todas formas, en esta crisis láctea habrá una criba importante.
m/a 212 Frisona Española 23



La empresa Bayer organizó el 31 de marzo una jornada de debate en la que reunió a representantes de los eslabones de la cadena del sector lácteo –desde el productor al consumidor–con un objetivo: conocer cómo se ve el futuro de la producción de leche de vaca desde distintos



Retos de futuro del sector del vacuno de leche en España



cialistas en economía agraria, representantes de cooperativas y de consumidores, sindicatos, administración... todos estuvieron presentes, al un lado u otro de la mesa, en esta jornada organizada por Bayer dentro de su campaña “Ganaderos y veterinarios: especialización, innovación y vocación para una mejor calidad de la leche”, que arrancó con esta cita en el Real Jardín Botánico de Madrid.
Partiendo de la premisa del esfuerzo económico realizado por las explotaciones españolas de vacuno lechero para mejorar tanto en instalaciones como en eficiencia productiva, Montserrat Tarancón, Directora Técnica Veterinaria de Bayer y responsable de Marketing de la Unidad
primera de las cuales se dedicó al “análisis del sector y retos de futuro”, con la participación de Antonio Casas, gerente de Alba Ganaderos Sociedad Cooperativa Andaluza; Manuel Carlón, subdirector de La Serrana Zarzalejo Sociedad Cooperativa; Jorge Santiso, profesor del Área de Economía de la Universidad de Santiago de Compostela; y Fernando Fernández, miembro de la ejecutiva y portavoz en la Comunidad de Galicia de la Organización de Productores de Leche (OPL).
La ronda de opiniones comenzó con la pregunta de cuáles son los elementos que definen al sector y hacia dónde se dirige. El primero en intervenir fue Antonio Casas, quien indicó que en Andalucía hay pocas vacas, pero muchas ganas de permanecer activos. En su opinión, el productor de leche es uno de los sectores con mayor desestructuración, aunque hasta ahora, reconoció, han tenido suerte porque han producido leche, se la han recogido y se la han pagado. La cuestión, finalizó, es que se ha gastado mucho dinero de puertas adentro, pero no se ha invertido de puertas afuera.
El segundo en responder a esta primera cuestión fue


Participaron en la primera sesión, de izquierda a derecha, Antonio Casas, Manuel Carlón, Jorge Santiso y Fernando Fernández
24 Frisona Española 212 m/a
Manuel Carlón, quien de forma vehemente manifestó que a partir del 1 de abril vendría lo peor, con ganaderos a los que ya no se les está recogiendo la leche. El subdirector de La Serrana Zarzalejo habló sobre el problema de los precios que perciben los productores, en un abanico que va desde los más “privilegiados” con precios entre 0,33 a 0,29 €, como los ganaderos de cooperativas como Covap o los que entregan a Pascual o Lactalis, hasta los ganaderos que están fuera de este circuito, ya sea en Galicia o en Madrid, y que están cobrando 17 céntimos de euros y que, en su opinión, no tienen ningún futuro. Carlón finalizó su intervención asegurando la necesidad de conocer bien la realidad del sector, desestructurado, con exceso de burocracia y sin un mercado competitivo. “Lactalis, afirmó, tiene objetivos; nosotros no y vamos a eliminar animales en beneficio de Francia”.
A continuación, Jorge Santiso tomó la palabra para indicar que el precio de la leche, con la continua tendencia a la baja, es un problema, pero también lo son el desequilibrio del mercado y la falta de recursos para seguir en activo. Sobre el sector afirmó que “no hay herramientas para gestionar la oferta y derivar leche a productos industriales; hay mala relación entre productores, industria y distribución; y, por último, soporta un importante déficit productivo e industrial respecto a los vecinos del norte”. En su opinión, el ganadero español ha hecho un gran esfuerzo para mejorar la alimentación, el manejo, la genética de su rebaño, pero se ha despreocupado sobre qué
sostenibles” por la de “leche de explotaciones españolas” para intentar recuperar al consumidor.
Para Jorge Santiso, es necesario que la Unión Europea se replantee una política agraria más activa y específica para el sector europeo. En su opinión, se han adoptado sistemas que pueden ser válidos para Nueva Zelanda, pero no para España, donde la producción se dirige al consumo interno y no al mercado internacional. Europa ha aumentado la producción en un 5%, pero no el consumo, y ese excedente se ha destinado a leche en polvo y mantequilla, bajando el precio en origen. Santiso finalizó indicando que los ganaderos deberían asumir su responsabilidad en esta situación, que deberían haber hecho –y hacer–algo en vez de pensar que es la Administración, junto con la industria y la distribución, la que debe resolver los problemas.
Cerró esta mesa la intervención de Fernando Fernández, quien reconoció estar de acuerdo con lo dicho anteriormente, aunque planteó la cuestión de hasta qué punto los ganaderos tiene poder para mejor su situación, sobre todo en cuanto a precios se refiere.
Bienestar animal y calidad de la leche

El tema de la segunda mesa fue la relación entre el bienestar animal y la calidad de la leche y contó con la participación del Dr. Luis Miguel Cebrián, presidente de la Asociación Nacional de Especialistas en Medicina Bovina de España (ANEMBE); el Dr. Pol Llonch, investigador del

Los componentes de la mesa de la segunda sesión. De izquierda a derecha, Luis Miguel
sucedía luego con su producto, cómo y en qué mercados se colocaba la leche de sus vacas, y “se tendría que haber ocupado también de ésto”.
El último en intervenir en esta primera ronda fue Fernando Fernández, quien comenzó reconociendo que los ganaderos han ganado mucho dinero, pero que lo van a tener que vender todo. En su opinión, todavía hay cuota de mercado, pero es necesario un plan estratégico apoyado por la Administración. Fernández finalizó indicando que los ganaderos tienen que trabajar con la industria y la distribución para revalorizar la leche y conseguir mejores precios.
Las claves para la eficacia y supervivencia de las explotaciones fue el segundo tema planteado en esta mesa, sobre el que el representante de Andalucía indicó que es imprescindible la unión del sector productor para abrir nuevas vías; en Andalucía, indicó, el 88% de la leche está cooperativizado, aunque reconoció que esta unión no se da en todas las CCAA.
Por su parte Manuel Carlón insistió en la necesidad de marcar objetivos e implantar planes estratégicos, aunque el problema, reconoció, es ver quién los paga. “La distribución es la que manda, los acuerdos no se cumplen, la cadena de valor no tiene valor y nos teníamos que haber preocupado más por el mercado”. Así las cosas, uno de los cambios que propuso fue sustituir la leyenda “lácteos
Departamento de Ciencia Animal y de los Alimentos de la Facultad de Veterinaria de la Universidad Autónoma de Barcelona; Francisco Sesto, veterinario especialista en calidad de leche de Seragro; y el Dr. Raúl Vázquez, responsable global del Servicio Técnico de Vacuno de Bayer.
El primero en intervenir fue Luis Miguel Cebrián, quien habló del papel del veterinario en las ganaderías, afirmando que el colectivo que representa y los servicios que prestan han evolucionado junto a las explotaciones de vacuno lechero, adaptándose a las nuevas necesidades de éstas. Cebrián dibujó el escenario de un sector con mayor número de animales, mayores producciones, un buen número de veterinarios, pero también excesiva legislación, un aspecto en el que los veterinarios deberían tener un papel más importante para hacer más racional la normativa. Indicó que ahora “el paciente es la explotación, no la vaca”; en este sentido dijo que el veterinario debe formarse como gestor de la salud del rebaño: instalaciones, bienestar animal, gestión de recursos humanos... Debe entender, en definitiva, que su rentabilidad radica en la rentabilidad de la explotación ganadera y que su futuro depende de la eficiencia de la ganadería: hacer más con menos. En cuanto a los ganaderos indicó que deben entender el valor de unos servicios de calidad e invertir en el veterinario.
A continuación Pol Llonch dio su opinión sobre la fi-
Cebrián, Pol Llonch, Francisco Sesto y Raúl Vázquez
m/a 212 Frisona Española 25


De izquierda a derecha, Fernando de Antonio, Ana Isabel Ceballo y Emilio de León, que participaron en la tercera y última sesión de la jornada
gura del veterinario, que ha cambiado de clínico a agente que pone en contacto al ganadero con el exterior. En este sentido, el veterinario tiene ahora más competencias y responsabilidades; es el garante de la integridad de la explotación en una realidad de consumidores cada día más exigentes respecto a la calidad alimentaria, el respeto por el medio ambiente y el bienestar animal. Para Llonch, los principales problemas a los que se enfrenta la profesión veterinaria en estos momentos son el bienestar de los animales, el efecto del clima cambiante y cómo puede interferir en el rebaño, y la intensificación de la producción ganadera.
En tercer lugar intervino Francisco Sesto, quien afirmó que para mirar al futuro es necesario mirar hacia atrás. Así, hizo un breve repaso a la evolución del sector lechero en las últimas décadas. Un sector que ha pasado del ordeño a mano, al robot de ordeño; que ha importado animales, que ha aprendido a producir leche y de forma eficiente; que ha evolucionado en reproducción, alimentación, costes de producción; que ha implantado programas de calidad de leche, con protocolos de ordeño; que dispone de mucha información que hay que saber gestionar. Y para llegar al punto actual, finalizó, ha sido y es fundamental el trabajo entre el ganadero, el veterinario y la universidad.
Cerró esta ronda de intervenciones Raúl Vázquez y lo hizo desde el optimismo: todos los sectores relacionados con la producción animal, afirmó, ven un futuro positivo para el lechero porque en 2050 habrá más de dos mil millones de personas que necesitarán leche y alimentos. Es un futuro con menos ganaderías, pero con rebaños más grandes y con vacas más eficientes. Para Vázquez, el veterinario está entre las instituciones y el consumidor, en una situación injusta porque no participa en la toma de decisiones y está sometido a una presión que cada vez será mayor. Por otro lado, las vacas han aumentado su producción, pero no han mejorado su sistema inmune y es ahí donde el veterinario debe trabajar.
Finalizada esta presentación, se planteó a los integrantes de la mesa qué acciones emprender el bienestar animal. Cebrián fue el primero en responder, afirmando que son necesarios parámetros científicos para valorar el bienestar. Para él, las vacas deben estar limpias, secas y confortables, esa es la base, y a partir de ahí, trabajar siempre para satisfacer las necesidades del consumidor.
Para Llonch, el bienestar animal también afecta a la aceptación del producto por parte del consumidor, es un valor añadido. Y también está relacionado, apuntó, con la adaptación de los animales al cambio climático, en cómo afecta a su salud, lo que se relaciona directamente con el uso de medicamentos.
Sesto intervino afirmado que el bienestar animal es fundamental y que el sector ha invertido mucho en mejorar el confort de las vacas, lo que ha llevado a una mayor
rentabilidad favorecida por un menor gasto en medicamentos y menor leche descartada. El objetivo debe ser, finalizó, trabajar mejor para tener menos patologías.
Raúl Vázquez finalizó haciendo hincapié en la importancia de todo lo que se está haciendo, pero también en necesidad de transmitir al consumidor el mensaje de que el ganadero y el veterinario invierten y trabajan para mejorar la salud y e confort animal.
Los productos lácteos y el consumidor
En la última mesa de la jornada participaron Fernando de Antonio Jiménez, director del Departamento de Ganadería de Cooperativas Agro-alimentarias de España; Ana Isabel Ceballo, presidenta de la Asociación General de Consumidores; y Emilio de León y Ponce de León, director de Alimentación Animal y Agricultura de la Sociedad Cooperativa Andaluza Ganadera del Valle de los Pedroches (COVAP).
Para Fernando de Antonio, ni el sector productor ni el transformador informan bien al consumidor sobre lo que hacen y el problema, que afecta a todos, es que el consumo de leche líquida es cada día menor. Para él, “lo mismo que sabemos producir bien, hay que saber promover bien”.
Ana Isabel Ceballo coincidió en la desinformación de consumidor, afirmando también que éste debe estar junto al productor frente a la distribución. En su opinión, el consumidor actual reclama productos que favorezcan el desarrollo territorial y garanticen la seguridad alimentaria y el bienestar animal. “El 60% de los consumidores, afirmó, estaría dispuesto a pagar más por un producto si sabe lo que hay detrás de él”.
Por su parte Emilio de León coincidió en lo expuesto por su compañeros de mesa, añadiendo tres puntos fundamentales en este debate: hay que dejar bien claro que ni la leche es un veneno ni se trata mal a las vacas; hay que adaptarse al consumidor actual y producir lo que se vende, no vender lo que se produce; y por último, pero no menos importante, no olvidar en esta travesía la figura del agricultor.
Pero ¿cómo orientar la producción de leche para satisfacer las demandas del consumidor? Para de Antonio y para Ceballos, es imprescindible la información, utilizando entre otras la figura de INLAC. Emilio de León, suscribió lo anterior, afirmando que el modelo de Covap es el del ganadero con la industria y la distribución pensando siempre en el consumidor, lo que busca y lo que compra. Pero, afirmó, existe un consumidor con pocos recursos que busca el precio más económico, no la calidad o el bienestar del animal. Esa es la realidad, insistió, para finalizar diciendo que “el consumidor nos da la vida o la muerte por dos céntimos”.
26 Frisona Española 212 m/a



Las novillas son el futuro rebaño
La sanidad durante la recría es una de las piezas claves para la rentabilidad de las explotaciones de vacuno de leche. Consciente de esto, Zoetis organizó el pasado mes de noviembre el Foro de Farmacoeconomía en Vacuno de Leche donde reunió a reconocidos expertos en el manejo de la recría.
A continuación, cuatro de estos especialistas, líderes de opinión en la materia, nos acercan a través de cinco breves preguntas los aspectos fundamentales a tener cuenta para las novillas y su crecimiento, en beneficio del buen funcionamiento de la explotación: Alex Bach (IRTA), Joaquim Baucells (Centre Veterinari Tona), Ernesto Reyes (Agri benchmark); y Sergio Casalmiglia (UAB). Todos ellos coinciden en un aspecto: “la novilla es la base del futuro de la explotación”.

“ hay muchos beneficios económicos asociados a una reducción efectiva de la edad al primer parto”
“Los primeros seis meses determinan la rentabilidad de una explotación de vacuno lechero”. ¿En qué se basa dicha afirmación?
Que la recría es el futuro de las explotaciones es un tópico por todos conocido. Sin embargo, lo que a menudo no se tiene en cuenta es que el modo en que las terneras
se han criado afecta su capacidad productiva, su reproducción, y su longevidad. Cerca del 20% de las vacas de primera lactación no alcanzan la segunda lactación. Esto demuestra que hay mucho camino por recorrer para mejorar la calidad de la recría. Los primeros 6 meses, y en especial los primeros 60 días, son muy importantes para que el animal pueda expresar su potencial genético en el futuro.
¿Qué objetivo fundamental hay que tener presente para obtener el máximo partido en la vida productiva del animal?
Lamentablemente no existe un único objetivo. Hay que hacer las cosas bien en todos los sentidos: nutrición, manejo, limpieza, salud, etc.
¿Cómo de clave es un buen manejo sanitario en el crecimiento de las novillas y en la edad al primer parto?
En Europa muchas veces se confunde alta productividad e intensificación con falta de bienestar y salud. Y es todo lo contrario, una vaca que produzca 70 kg de leche al día sólo lo puede hacer si está sana y estuvo sana durante la recría. Del mismo modo, terneras que enferman son animales menos productivos, que crecen peor, paren
Suponen un 15-20% del costo global de la producción lechera
28 Frisona Española 212 m/a
Alex Bach. Instituto de Investigación y Tecnología Agroalimentarias (IRTA)
más tarde (cuestan más dinero), y luego suelen producir menos que las terneras que no enfermaron. Esto es especialmente importante si la enfermedad que padecieron era respiratoria.
menor de días. En cifras, una explotación de 100 vacas que reduzca la edad media al primer parto 4 meses podría generar un beneficio neto anual de más de 8.000 euros.
¿Cómo de influyente es la edad al primer parto en la rentabilidad de la explotación?
Agradezco la pregunta, pues creo que hay muchos beneficios económicos asociados a una reducción efectiva (es decir, asociada a un buen crecimiento del animal) de la edad al primer parto. Por un lado se requieren menos terneras y, por otro, se las alimenta un número

“
Son los animales destinados a mantener o acrecentar el efectivo de una explotación lechera”
Joaquim Baucells. Centre Veterinari Tona, S.L.
Joaquim, bajo su punto de vista, ¿cuál es el papel que adquiere la novilla en la explotación?
Es la base del futuro de la explotación. Son los animales destinados a mantener o acrecentar el efectivo de una explotación lechera contribuyendo, si cabe, a la mejora de la calidad y la productividad del rebaño.
¿Considera que España tiene margen de mejora en este aspecto?
La recría ha ocupado un segundo plano en la producción de leche. Se han logrado muchísimas mejoras en las vacas de lactación, y ahora el sector, no sólo en España, se ha dado cuenta que para seguir mejorando, hace falta centrarse en la recría. •••
¿Qué aspectos son claves en la recría de novillas
La correcta elección de la genética, reducir las bajas y eliminaciones, favorecer crecimientos adecuados en cada fase, y minimizar la edad a primer parto con un crecimiento adecuado, y a un coste mínimo.
¿Cuál es el coste aproximado de producir una novilla y qué valor adquiere en el mismo la sanidad?
Actualmente una novilla puede costar entre 1.400 y 2.600 euros, dependiendo de muchos y variados factores. El gasto en sanidad representaría del 2% al 5%: se trata de un dispendio imprescindible, pero menor, y una inversión con retorno.

¿Qué repercusión económica en la explotación puede conllevar el no seguir un programa sanitario adecuado?
Dependiendo de la patología, los efectos económicos serán más o menos importantes según afecten a retrasos de crecimiento, la mortalidad de los animales o a la eficiencia reproductiva (infertilidad, abortos, etc.), con repercusiones evidentes en un incremento de costes finales.
¿Cómo de influyente es la edad al primer parto de una novilla en el futuro de la granja?
Asumiendo que los crecimientos son óptimos para asegurar una adecuada productividad futura, con los partos a edades más tempranas se reducen los costes en aproximadamente un 5% al mes.


“Una edad a primer parto de la reposición menor reduce significativamente el efectivo de recría necesario (5-8% por mes) para la reposición precisando, por ello, menos gasto, menos espacio en instalaciones, menos tiempo, etc.
•••
“mientras hagamos programas de medicina preventiva estaremos básicamente asegurando el futuro de los rebaños”
En pocas palabras Ernesto, ¿cómo cree que será el futuro del sector vacuno de leche?
En el futuro manejaremos altas cantidades de riesgo en un escenario de volatilidad y con un tema de sostenibilidad como marcos preferenciales.
¿Cómo de relevante es la sanidad en el futuro del sector?
La sanidad tiene una directa implicación en los costes de producción, ya que mientras hagamos programas de medicina preventiva estaremos básicamente asegurando el futuro de los rebaños. Y ese futuro de los rebaños tiene una implicación muy clara en los aspectos de edad a primer parto, de intervalo entre partos, de días en leche, etc.,
¿Cuáles son los principales retos a los que el sector debe hacer frente?
Son básicamente los aspectos que mencioné en la primera pregunta. La volatilidad es el primer reto: tenemos que aprender a manejar márgenes inferiores de los que ya tenemos. El segundo sería la sostenibilidad: necesitamos producir muchísima más leche en un escenario a 25 años y los recursos para producir esa leche son muy escasos, básicamente recursos naturales. La sostenibilidad va a marcar la tendencia clara como uno de los retos específicos que vive el sector.
Y el tercer reto es la cooperación a lo largo de la cadena de valor de la leche. Si el productor, las industrias, los distribuidores, no trabajan más conjuntamente, es muy difícil hacer frente a estos retos.
En una perspectiva mundial, ¿cómo se sitúa el sector de vacuno de leche español?
Podríamos decir que el sector vacuno de leche español ha hecho los deberes en temas muy importantes como son la genética, la nutrición, inversiones, etc., pero claramente son sistemas de producción altamente dependientes de los alimentos concentrados y de las materias primas importadas, por lo tanto, la volatilidad será su principal reto.
Bajo su punto de vista, ¿qué aspectos debería mejorar el sector en España para ser más rentable y competitivo? Una sola frase: integración de la cadena de valor. •••
si no eres conocedor de la producción, la i ncidencia de enfermedades o la fertilidad, no puedes tomar una decisión con el objetivo de mejorar tu rentabilidad”
Sergio Calsamiglia. Facultad de Veterinaria de la UAB
Sergio, en su opinión, ¿qué pasos deben cumplirse para garantizar la rentabilidad de la explotación?
La ecuación es muy simple; consiste en incrementar el precio de la leche, producir mucha leche, y gastar poco. En esta ecuación el precio de la leche es muy difícil de controlar, porque es algo que viene establecido. Por lo tanto, las partes que podemos controlar son nuestra productividad –cuánta leche producimos–y a qué precio conseguimos esta productividad.
En la toma de decisiones, ¿qué aspectos fundamentales debe tener en cuenta el productor de vacuno de leche?
El factor más importante en cualquier decisión es que la decisión sea rentable. Por otro lado, la primera premisa que hay que tener en cuenta es resolver un aspecto que sea crítico para la rentabilidad de la explotación. Es decir, debemos analizar cuál es la magnitud económica del problema y si la respuesta que ofrece la alternativa para resolver ese problema es rentable. Realmente es algo de sentido común, pero no solemos hacerlo.
¿Cómo de importantes son los datos en una granja?
Para tomar decisiones los datos son imprescindibles. Es el punto de partida inexcusable. Si no sabes si tienes un problema no puedes resolverlo: si no eres conocedor de la producción, la incidencia de enfermedades o la fertilidad, no puedes tomar una decisión con el objetivo de mejorar tu rentabilidad. Porque no sabes la magnitud de tu problema, no sabes cuánto dinero pierdes por el mismo, y por lo tanto no puedes ponerlo en la balanza para saber cuánto dinero recuperar con la solución planteada.
¿Cómo de importante es el cuidado de la novilla?
Es indudable que la novilla es el futuro de la explotación. Es un proceso de inversión que mientras crece implica un gasto de dinero sin retorno, pero enfocado a que cuando comience a producir, se recupere la inversión.
Es cierto que hoy en día hay más conciencia de la novilla que hace diez años, pero todavía hay una oportunidad grande en mejorar el desarrollo de las novillas para conseguir unas buenas vacas en el futuro.
¿La prevención de enfermedades infecciosas es rentable?
Los análisis que he realizado de tipo económico muestran que el coste de vacunación es bajo, en el contexto de los costes de una explotación; y con prevalencias superiores a 10% estás recuperando tu inversión. Si hablamos de prevalencias de 25-30% el retorno es de 1 a 4.
Desde mi punto de vista la balanza entre el riesgo y el relativo bajo coste de un programa vacunal, a no ser que haya una contraindicación calculada (prevalencia cero), hace recomendable la vacunación.
Ernesto Reyes. Agri benchmark
30 Frisona Española 212 m/a

Conferencia y 14ª Asamblea de la Federación Mundial Holstein
Buenos Aires, del 28 de marzo al 3 de abril de 2016
“ I m a g i n e m o s e l f u t u r o ”

La ciudad argentina de Buenos Aires ha sido este año la sede de la 1
4ª Conferencia y Asamblea de la Federación Mundial de Holstein (WHFF)a la que han asistido más de 400 delegados procedentes de 37 países.
14ª Conferencia Mundial Holstein


La inauguración del Simposio, con el lema “Imaginemos el futuro”, corrió a cargo del presidente de la WHFF, Matthew Schaffer, y del presidente de la 14ª Conferencia, Máximo Russ, así como de un representante del gobierno de Argentina.
Alejandro Castillo de la Universidad de California fue el encargado de impartir la conferencia magistral en la que mostró que la sostenibilidad futura, tanto económica como ambiental y social, es responsabilidad de todo el sector lechero. Hay que afrontar los desafíos de la eficiencia, del bienestar animal y de la opinión pública.
La genómica
“La genómica ¿nos resuelve los problemas?” fue la cuestión sobre la que versó la primera sesión. Brian Van Doormaal (CDN, Canadá) apuntó a la necesidad de utilizar los programas de acoplamientos para reducir la consanguinidad, parámetro que ha aumentado desde 2009 en la población mundial de Holstein. Stephan Rensing (vit, Alemania) consideró que la población de referencia de hembras y la recogida de datos es hoy especialmente necesaria para mejorar genéticamente caracteres relacionados con la salud. Tom Lawlor (Holstein USA) confirmó que hay genética Holstein de sobra para mejorar caracteres secundarios, sin deprimir los productivos, ni tener que acudir a los cruzamientos con otras razas. Andrew Hunt (The Bullvine.com) nos hizo ver que deberíamos considerar que el vacuno puede llegar a mejorarse al estilo del porcino y de las aves y que es muy importante atender a la opinión pública, si queremos que los productos lácteos sean aceptados por las sociedades futuras.
El tipo funcional
Las vacas útiles fue el tema de la segunda sesión. De ello trataron Gerben de Jong (CRV, Holanda), Raffaella Finnochiaro (ANAFI, Italia, Gordon Atkins (Universidad de Calgary, Canada), Luis Calvinho (INIA, Argentina) y Mat-
thew Lucy (Universidad de Missouri, USA). Las conclusiones que se transmitieron fueron la necesidad de trabajar en caracteres de tipo funcionales, como la colocación de pezones posteriores, de investigar en la profundidad de talón, de asegurarse que la angulosidad es independiente de la condición corporal y de usar una combinación de colocación de isquiones y fortaleza de lomo para una correcta funcionalidad reproductiva y de locomoción.
Asimismo, para tener animales con bajo riesgo de contraer mamitis, se propuso seleccionar siguiendo patrones de recuento de células somáticas. En otro orden de cosas, se mostró que la inmunosupresión depende de muchos factores, pero hay que actuar minimizando deficiencias nutricionales y factores ambientales estresantes, así como seleccionar por caracteres de salud y eficiencia.
Ganadería y medio ambiente
La tercera sesión la inició la embajadora de Nueva Zelanda en Argentina que repasó la normativa ambiental mundial y mostró las soluciones que su país está implementando para atajar el exceso de Nitrógeno en el suelo. El resto de ponentes de la sesión se centraron en explicar cómo influye el medio ambiente y el bienestar animal en el negocio lechero. Así, Alejandro La Manna (INIA, Uruguay) expuso que existe una Huella del Agua: verde, que es el consumo de agua de lluvia; azul, el del agua superficial y subterránea y gris, la del agua necesaria para asimilar los contaminantes del sistema productivo. Noelia Silva del Río (Universidad de California, USA), mostró casos en los que con modificaciones sencillas en granjas es posible incrementar el bienestar de las vacas (sombra, acceso al alimento y al agua, etc). El abogado Ignacio Maglio (Universidad de Buenos Aires, Argentina) cerró esta sesión informando sobre los derechos de los animales, considerados como personas no humanas y, en concreto, sobre los aspectos críticos del derecho animal acerca del trato a las vacas de leche.
Eficiencia de las ganaderías
La cuarta sesión tuvo como leitmotiv la eficiencia de las ganaderías, con una orientación claramente de pastoreo, como lo mostraron Santiago Fariña (INIA; Uruguay) con los 10 mensajes para convertir el pasto en leche, que van desde el incremento de la producción forrajera por ha y la reducción de pérdidas, pasando por el incremento de la rentabilidad por vaca y el uso robots para el manejo. de por ha hasta la, Sergio García (Universidad de Sidney, Australia) y Nicolas Lyons (NSW, Australia), estos últimos certificando que las tecnologías han venido para
32 Frisona Española 212 m/a
quedarse y que no podemos prescindir de ellas si queremos continuidad en el negocio y que hay que reemplazar tareas manuales por mecánicas y analizar la información que nos proporcionan los instrumentos que capturan datos.
El futuro
Finalmente, el futuro del negocio lechero se analizó en la 5ª sesión. El futuro nos traerá nuevos retos, aparte de los tecnológicos; los cambios que surgen en los propios animales, más productivos y frágiles que en el pasado; las nuevas generaciones, que buscan identificar trabajo y placer y una simplificación de tareas que haga más fácil la organización del mismo. De todo ello hablaron Mario Olivares (Cooprinsem, Chile), Javier Baudracco (UNL, Argentina) Fernando Preumayr (Universidad Austral, Argentina) y Paula Molinari (Universidad di Tella, Argentina). La visión de la producción ecológica y de los animales que mejor se pueden adaptar a ésta, corrió a cargo de Guido Simon, ganadero alemán. Finalmente el Dr. Alberto Cormillot (IAAN, Argentina) habló de la leche como parte de una dieta completa y de su defensa frente a fanatismos alimentarios.
14ª Asamblea de la Federación Mundial
En la 14ª Asamblea de la Federación Mundial se informó a todas las Asociaciones miembro de las actividades desarrolladas desde la última Asamblea de Toronto en 2012. Se expusieron los resultados obtenidos por los grupos de trabajo de armonización de caracteres de tipo y de las iniciativas de consanguinidad, presentándose un informe sobre la evolución de ésta en distintos países; de la de Federaciones de criadores de raza pura de ICAR; de las normas internacionales de concursos y de la de fertilidad y salud.
Se aprobó asimismo lo siguiente:
•Nuevo consejo y cargos de la WHFF:
-Jos Buiting, Holanda, presidente
-Anne Louise Carson, Canadá, vicepresidente


La Vaca Gran Campeona del Concurso Nacional de Argentina, celebrado también durante estos días
-Giorgio Burchiellaro, Italia
-Egbert Federsen, Alemania
-Denis Bieri, Francia
-Peter Cole, USA
-Hironori Otomo, Japón
-Felipe Ruiz, México
-Cherlyn Watson, Nueva Zelanda
-Lászlo Bognar, Hungría
•Nueva Secretario General:
Suzanne Harding, Reino Unido
•Nuevo coordinador del grupo de trabajo de armonización de caracteres de tipo:
Gabriel Blanco del Campo, España.
•Aceptación de nuevos miembros: Brasil.
•Próxima país anfitrión de la 15ª Conferencia y Asamblea de la WHFF: Suiza en 2020.


Cada dos años el grupo de trabajo encargado por la WHFF para la armonización de la calificación en el mundo organiza la reunión mundial de calificadores, en la que se valoran las correlaciones de los rasgos del tipo entre países, se proponen nuevos caracteres del tipo para su estudio y posible implantación y se dan recomendaciones y pautas a seguir para mejorar la calidad de la información recogida y el control y monitoreo de los calificadores y las calificaciones a nivel mundial.
Este Comité es responsable de la mejora de las correlaciones genéticas de los rasgos de morfología entre países y hace posible que se puedan comparar las pruebas de sementales a nivel mundial. Hoy el ganadero necesita usar la mejor genética mundial disponible a su alcance para hacer mas rentables y eficientes sus ganaderías,
siendo importante que esa información que recibe, sobre el tipo en esta ocasión, sea altamente fiable, para lo cual los rasgos morfológicos deben ser calificados de la misma manera por todos los países del mundo.
Cuando un rasgo o carácter de tipo, como por ejemplo el Ángulo podal, no tiene una correlación aceptable con otros países, puede ser entre otros motivos, porque se está usando una escala de medición diferente; no se está siendo preciso al aplicarla en campo o porque no se usa la escala recomendada por la WHFF y por lo tanto, se debe trabajar para ir mejorando estas desviaciones.
En el encuentro de Argentina, que se celebró coincidiendo con la Conferencia y Asamblea Mundial, se reunieron 43 participantes procedentes de 23 países. La reunión comenzó con una charla de Vicente Argoitia,
R e u n i ó n M u n d i a l d e C a l i f i c a d o r e s
m/a 212 Frisona Española 33


jefe de calificadores de Argentina, sobre la historia, genética y ganadería del Holstein en este importante país criador de Holando que cuenta con más de dos millones de cabezas de las cuales unas 500.000 tienen registro de pedigrí.
Arie Hamoen, “chairman” de la reunión, presentó un resumen de todos los trabajos y objetivos alcanzados desde 1986 hasta nuestros días, incidiendo en las recomendaciones y resultados emanados de las dos últimas reuniones de USA y Dinamarca.
En diciembre del 2015, fueron 23 los países que participaron en las evaluaciones genéticas de Interbull y Gerben de Jong, genetista holandés, explicaba los resultados de las correlaciones obtenidas entre estos países: 7 rasgos de tipo tenían una correlación superior a 0,90 y 7 rasgos tenían una correlación inferior a 0,80. En algunos de estos casos la baja correlación era debida a que algún país no estaba usando las definiciones oficiales sobre ese carácter. Algunos países no están valorando todos los caracteres recomendados, tales como la movilidad, condición corporal, etc y se le insta a que incluyan en sus programas de calificación estos caracteres lo más pronto posible. A nivel general la correlación de algún carácter ha bajado algo y esto es también debido a que han entrado

Arriba, el grupo de calificadores que participaron en la reunión. Junto a estas líneas, Gabriel Blanco (segundo por la izquierda), nuevo Chairman del Grupo de Calificación Mundial
-Calificar la Angulosidad independientemente de la Condición Corporal del animal, lo que significa que la correlación entre los dos caracteres debería ser 0,0. No se debe relacionar una vaca gorda con una falta de carácter lechero; puede estar relacionado o no.
-Rasgos a mejorar en las correlaciones entre países y trabajar con ellos muy de cerca los próximos meses: Angulosidad, anchura de pecho, vista posterior de patas, movilidad, Inserción anterior y ligamento suspensor.
-Seguir organizando las reuniones mundiales de calificadores.
Las correlaciones medias de todos los caracteres del tipo, de un país con el resto de países varía de 0,76 para Estonia a 0,86 que es la más alta y que la tienen Alemania, Canadá y España. Este dato es importante ya que lo más cercano o próximo que estemos del 0,90 mejor información sobre el tipo tendremos entre esos países.
Desde la primera reunión en Cremona en 1990, pasando por la de Toledo en 1999 hasta Argentina 2016, se han obtenido logros importantísimos en cuanto a armonización de criterios y formas de trabajo entre países, consiguiendo que los caracteres morfológicos de la raza EEUU y valorándose este programa de trabajo como el más importante proyecto de la WHFF.
Las prácticas de calificación se realizaron en la Cabaña Campazu, una de las mejores ganaderías de Argentina con las mejores familias de vacas de Holando en sus instalaciones y donde se pudo trabajar con más de 30 primerizas y vacas adultas, armonizar criterios y discutir en un buen ambiente de trabajo sobre la morfología de la vaca Holstein.
Agradecemos desde aquí a los propietarios Nestor Porcel, Zulema Ibarbia de Porcel y Marcelo Porcel su
 Gabriel Blanco
Jornadas prácticas de calificación en Cabaña Campazu
Gabriel Blanco
Jornadas prácticas de calificación en Cabaña Campazu
34 Frisona Española 212 m/a

Proyecto1_Maquetación 2 19/04/16 15:05 Página 1

Gabriel Blanco, chairman del comité de calificación de la WHFF

Gabriel Blanco, Jefe del Departamento de Morfología de CONAFE, comenzó a trabajar en la extinta ANFE en el año 1979, dando sus primeros pasos en la calificación morfológica de la vaca frisona.
Desde siempre ha estado muy ligado a otras asociaciones europeas, americanas y canadieses, donde se formó , hasta llegar a formar parte del Comité Técnico de calificadores de la WHFF.
Finalmente, en el Taller Mundial de Califiación celebrado en Argentina en pasado més de marzo, fue nombrado Presidente del Comité de Calificación de la WHFF
¿Qué es el comité mundial para la armonización de la calificación y cuáles son sus objetivos?
La WHFF o la federación mundial de asociaciones de ganado Holstein o frisón, creó en 1986 un grupo de trabajo encargado de armonizar la calificación de las vacas entre todos los países del mundo, para ello era necesario empezar por identificar y conocer lo que cada país estaba haciendo en materia de calificación y unificar criterios entre todos: El objetivo principal era y es, el intercambio de información y la valoración de sementales entre países, con la finalidad de darle al ganadero la posibilidad de usar la mejor genética mundial para mejorar su explotación con niveles altos de fiabilidad. Gracias a este intercambio de información entre países es posible obtener información genética y genómica de cualquier semental o vaca.
El primer paso que se dio fue la de identificar aquellos rasgos o caracteres lineales del tipo que mejor definieran las particularidades de la vaca frisona.
Esos rasgos que se debían armonizar entre países debían de cumplir una serie de premisas, fueron los fundadores y en los que está fundamentado el sistema moderno y actual de calificación: Empezaba la era de la calificación lineal en el mundo.
• Los rasgos se valoraban individualmente
• Cubrían el rango biológico de la población
• Había variación entre los rasgos
• Eran heredables
• Tienen valor económico
¿Las decisiones que se adoptan son vinculantes para todos los países de la WHFF?
SÍ, las decisiones son vinculantes para todos los países aunque algunos tardan algo más de tiempo en adoptar las recomendaciones hechas por la WHFF, al tener que organizar entre otras cosas, sus programas y computadoras hacia la recogida o mejora de nueva información, lo cual es costoso y lleva algún tiempo. Todos los países colaboran y cumplen con las directrices emanadas del trabajo del grupo de trabajo
Interbull también esta muy interesado porque estas recomendaciones se cumplan lo antes posible y siguiendo las pautas técnicas de tratamiento de la información adecuadas.
¿Cuándo entraste en el comité?
En en año 1990 se celebró la primera reunión mundial de calificadores en Cremona (Italia) y a partir de entonces entre a formar parte de ese grupo de trabajo
¿Cuáles crees que han sido los logros más importantes?
Lo más importante ha sido la definición de los 18 rasgos principales morfológicos lineales, haberlos armonizado a nivel de todos los países del mundo, recordando que en el año 1986 cada país medía, valoraba o definía los rasgos morfológicos basándose en su idiosincrasia particular y lo que es más importante y por si hubiera dudas, se consiguió una correlación genética entre países para algunos caracteres del tipo superior al 0,95%, es decir a
36 Frisona Española 212 m/a
los mismos niveles de los rasgos de producción: Esto es muy significativo ya que los calificadores inspeccionan visualmente la vaca mientras que los rasgos de producción se pesan y se miden.
Han pasado 17 años desde que se celebró en Toledo el 5º Taller Mundial de Calificación en 1999. ¿Cuáles son los cambios más importantes desde entonces en cuanto a la morfología?(caracteres que han ganado o perdido importancia; cambio del concepto de vaca ideal, adaptación de la morfología a las nuevas tecnologías.
Desde el taller que celebramos en Toledo, hasta la celebración del último Taller Mundial celebrado en Buenos Aires (Argentina), los pasados 28-30 de marzo, los esfuerzos se han concentrado en mejorar aún más las correlaciones genéticas entre países, mejorar las definiciones de los rasgos morfológicos valorados, trabajar en la armonización de los últimos caracteres morfológicos aprobados después del taller de Toledo, como fueron: La vista lateral de patas, movilidad y condición corporal y seguir fielmente las recomendaciones dadas por el ICAR en todo lo que significa Control y Monitoreo de la calificación y los calificadores, valoración de defectos en las vacas y el futuro y el uso de nuevos instrumentos o tecnologías para automatizar la calificación de algunos caracteres del tipo (cámaras, robots, etc.)
Este comité también trabaja en la normativa, organización y desarrollo de los concursos ganaderos. ¿Qué nivel de armonización existe entre los certámenes que se celebran en cada país?
No, este comité solo se encarga de la armonización de la calificación a nivel mundial.
Existe otro comité en Europa bajo la dirección de la EHRF, del cual yo también formo parte desde su inauguración, que se encarga de la Armonización de todo lo relacionado con jueces y concursos.
Este grupo de trabajo o comité, empezó a funcionar en 1994 bajo la gestión de Mauro Carra y Enrico Dadati, pertenecientes a la asociación iitaliana ANAFI, ya que en aquellos años las mentalidades de los distintos jueces en Europa no eran iguales.
Los concursos, las secciones, los premios, etc., diferían de un país a otro y había que armonizar todo ese galimatías.
Hoy, casi 25 años después, las cosas han cambiado radicalmente, los jueces están armonizados bajo la “Armonización de Jueces Europeos”, formando un Panel de profesionales que aumenta de año en año, con los mismos objetivos de juzgamiento y formas de pensar muy similares, cosa impensable hace años. A su vez casi cualquier concurso en Europa se organiza actulamente bajo las mismas directrices.
Y en cuanto a los jueces ¿hay grandes diferencias entre países? ¿Entre Europa y Canadá o EEUU?
Si, la hubo hace 25 años y no hoy día, gracias al grupo de trabajo de los jueces de la EHRF. Las diferencias ahora no son entre países sino entre objetivos de selección, buscados por pequeñas pero importantes formas de pensar de los jueces a nivel mundial.
¿Hacia dónde crees que va la vaca del futuro (tamaño, etc.)?
Como decía en mi anterior pregunta y enlazo con ella, aquellos jueces más preparados técnica, morfológica y “ganaderamente”, están más comprometidos con buscar la vaca más rentable para todos y que a la vez por supuesto que no “rechine” en una pista de competición, como fuera de los estándares ganaderos de
rentabilidad, es decir, gracias a la sabiduría de muchos años del ganadero, los estudios de las asociaciones y técnicos, la inteligencia de los jueces y la capacidad de cambio y mejora de los expositores, la vaca de Hoy, la que estamos viendo ganar y la del futuro, no me cabe ninguna duda que es y será la vaca que tenga la morfología ideal para seguir siendo la Reina de las Razas
Como presidente del comité de califiación de la WHFF ¿cuáles son los proyectos futuros?
Seguir trabajando en la mejora de las correlaciones de los caracteres de tipo entre países, estudiar la posibilidad de integrar los defectos de las vacas en la armonización mundial de tipo, trabajar más de cerca con aquellos
Lo más importante ha sido la definición de los 18 rasgos principales morfológicos lineales, haberlos armonizado a nivel de todos los países del mundo.
países que más necesitan mejorar su información a Interbull, promocionar el sistema y ayudar a participar de él a nuevos países de América del Sur o Asia y trabajar estrechamente con ICAR en la búsqueda de nuevos instrumentos tecnológicos que ayuden a mejorar la toma de datos en el campo
¿Qué crees que supone para CONAFE tu nombramiento? ¿Y para ti personalmente?
Personalmente, todos aquellos nuevos conocimientos que yo adquiera serán para compartir con mis compañeros los calificadores de CONAFE y con los programas de selección que a la postre redundaran en los ganaderos al poseer herramientas nuevas o mejoradas que permitan a nuestros socios elegir mejor la genética más rentable y mejorar sus ganaderías.
Para mí es un reconocimiento por parte de la Federación Mundial de Asociaciones a un trabajo de armonización mundial en el que creí desde el primer día y al que dedique el 99% de mi vida y mi esfuerzo.

m/a 212 Frisona Española 37
Gabriel Blanco, es el promotor y Director de la Escuela de Preparadores de CONAFE que viene celebrándose, anualmente, desde el año 2005




Conafe
Acuerdos de Junta de Gobierno
En la reunión de la Junta de Gobierno de CONAFE del 17 de diciembre de 2015 se aprobaron, entre otros, los siguientes acuerdos.
1.Precios del genotipado de hembras en 2016
Se aprueba que los precios para 2016 sean los siguientes:
Socios No Socios
50k
EUROG10K
75,00 € 80,00 €
Básico + Recesivos y otros caracteres 45 € 60 €
Básico Recría Genómica* + Recesivos 41 €
* Precio a aplicar a ganaderías que genotipen toda la recría, a AA/FF autonómicas y Programas de testaje que gestionen más de 200 muestras al año.
2.Actividades 2016
En 2016, se aprueban las siguientes actividades y asistencia a foros específicos:
•Conferencia de la WHFF en Buenos Aires del 28 de marzo al 3 de abril de 2016.
•Escuela de jueces de AFB en Menorca del 20 al 23 de abril de 2016.
•Confrontación Europea en Colmar (Francia) del 17 al 19 de junio de 2016.
•Concurso Nacional en Gijón del 22 al 25 de septiembre de 2016.
•Otros:
-II Curso de podología y
-V Unificación de criterios entre podólogos ISAP.
3.Calendario previsto de evaluaciones genéticas/genómicas en 2016:
/
viernes,
22 de julio de
miércoles, 7 de septiembre de 2016
Genómica Noviembre 16 / Descendencia Noviembre 16
MACE Diciembre 16 / G-MACE Diciembre 16 viernes, 11 de noviembre de 2016
Información de las Asociaciones y Federaciones Autonomicas
Comunicado de la Federación Frisona Gallega - FEFRIGA
Ante ciertos rumores que de forma más o menos interesada y/o malintencionada circulan o han circulado en fechas recientes y a fin de defender y preservar la honorabilidad del interesado,
LA JUNTA DIRECTIVA DE LA FEDERACIÓN FRISONA GALEGA - FEFRIGA
Comunica:
Que la rescisión del contrato del Director-Gerente de la Federación, D. Françesc Xavier Grau i Navarro, obedece, única y exclusivamente, al proyecto de reestructuración en que estamos inmersos, en ningún caso a problemas éticos, laborales, profesionales, personales o de otra índole, imputables al trabajador.
Por ello y al tiempo que determinamos la situación, aprovechamos para dejar constancia y manifestar al Sr. Grau, nuestro sincero reconocimiento por el extraordinario trabajo que ha realizado como Director-Gerente de FEFRIGA a lo largo de más de 21 años.
En Santiago de Compostela a 11 de enero de 2016
Recepción de muestras Evaluación Nacional Publicación MACE GMACE Pruebas Publicadas
22
enero de 2016 14/03/2016 05/04/2016
de
Genómica Marzo 16
Descendencia Noviembre 15
16 miércoles, 9 de marzo de 2016 18/04/2016 Mensual viernes, 8
abril
2016 16/05/2016 Mensual
2016 20/06/2016
Junio
viernes, 17
junio de 2016 25/07/2016 09/08/2016 MACE
viernes,
2016 19/09/2016 Mensual
07/11/2016 06/12/2016
MACE Abril 16/GMACE Abril
de
de
jueves, 28 de abril de
Genómica
16 Descendencia Junio 16,
de
Agosto 16 GMACE Agosto 16
26/12/2016 Mensual
42 Frisona Española 212 m/a
Genotipado de terneras en Euskadi
El 26 de febrero se celebró en las instalaciones de Aberekin, en Derio, una jornada para presentar los resultados del proyecto de incentivación del genotipado de terneras de Euskadi, impulsado por EFRIFE. En la reunión, a las que asistieron los ganaderos que han participado en el proyecto, José Antonio Jiménez del Departamento Técnico de CONAFE presentó los resultados del mismo. Gracias a esta iniciativa, se han sacado las siguientes conclusiones…
-Se ha mejorado el registro de genealogía de la población
-Se han detectado hembras de alto valor genético y alta fiabilidad
-Se ha mejorado la fiabilidad de los futuros acoplamientos
-Se tiene una buena estimación de la presencia de los diferentes caracteres recesivos
-Se puede evitar la aparición de las enfermedades usando programas de acoplamiento
-Se puede comenzar a seleccionar por caracteres como leche A2 o el gen POLLED. Los ganaderos participantes destacaron la utilidad de esta herramienta, valorando sobre todo la inmediatez de los resultados y la facilidad de tomar decisiones sobre terneras a desechar antes de incurrir en el coste de recría, la ventaja para realizar acoplamientos con buena fiabilidad en novillas e incluso vacas de primer parto y también valoraron positivamente la información sobre genes recesivos para evitar la aparición de problemas.
Además en la charla también se debatió sobre otros aspectos del programa de mejora genética como la importancia cada vez mayor de mantener buenos sistemas de recogida de datos, la composición del ICO y cómo se obtiene este índice de selección o los cambios en el mercado desde la llegada de la genómica.
Nueva Junta de Gobierno de AFNA
Tras la celebración de la Junta General Ordinaria Universal, el pasado 22 de marzo de 2016, en la que se renovaron parcialmente los miembros de la Junta de Gobierno de la Asociación Frisona de Navarra y la celebración de la primera Junta de Gobierno con fecha de 14 de abril de 2016, la Junta de Gobierno queda formada por:
•Presidenta y representante en la Junta de Gobierno de CONAFE: Beni Irurita Loiarte
•Vicepresidente: Andrés Planillo Torres
•Secreatira: Raquel Moltó Sarasa
•Juan Macaya Zandio
•Miguel Joxe Ariztia Damboriena
Confrontación Europea Colmar 2016
Como venimos anunciando, Colmar será la sede oficial del Concurso Europeo de la raza Frisona, donde a mediados de junio se darán cita las mejores vacas blancas y rojas y blancas y negras de Europa y donde brillarán las campeonas de la raza, en el mejor ambiente ganadero de pedigrí del mundo, juzgándose las categorías de blancas y rojas el viernes 17 de junio y las blancas y negras el sábado 18.
España participará con 15 vacas que tendrán que cubrir las categorías de jóvenes, intermedias y adultas. Este año, debido a la Lengua Azul en Francia, los animales posibles participantes en el evento han tenido que ser vacunados dos meses antes de la elección final de los mismos, lo cual ha dificultado la inscripción de animales muy recién paridos. Es de agradecer a las ganaderías españolas que han colaborado en la preselección de nuestras vacas ya que hubo que vacunar de Lengua Azul a casi 50 animales, aunque finalmente sean 15 los que nos representen en Francia.
Los jueces oficiales serán en esta ocasión el alemán Marcus Mock para el Holstein blanco y negro y el español Jaume Serrabassa para las blancas y rojas, ambos pertenecientes al plantel de jueces oficiales europeos.


El viernes 17 tendrá lugar una Subasta Europea y la competición de los jóvenes ganaderos, los cuales habrán estado preparándose para mostrar sus habilidades de manejadores y peladores durante los días anteriores al campeonato.
Ganaderías Colaboradoras:
Algendar den Gomila (Menorca)
Cal Marquet (Lleida)
Casa Flora (Asturias)
Cudaña (Cantabria)
Ganadería Badiola (Asturias)
Ganadería Cid (Lugo)
Ganadería Quintana (Cantabria)
Granja Leonor (León)
Granja Perejil El Macho (Cantabria)
Empresas patrocinadoras
La Flor (Cantabria)
La Marina de Retortillo (Cantabria)
Llera Her (Cantabria)
Ponderosa Holstein (Lleida)
Rey de Miñotelo (Lugo)
Rona (Ávila)
SAT CeceñoCantabria)
SAT Teserna (Cantabria)
S.C. Kataburu (Navarra),

Aberekin, Ascol, Boehringer Ingelheim
España, S.A.Embriovet/Embriomarket, Semex España, World Wide Sires España y Xenética Fontao
m/a 212 Frisona Española 43
Conafe
Reciclaje de jueces de CONAFE



Sobre estas líneas, José Manuel Paz Conde y Gabriel Blanco.
Arriba, todas las vacas que formaron las secciones del reciclaje y detalle de una de estas secciones.
Abajo, el panel de jueces de CONAFE junto a Germán de la Vega, Presidente de la Confederación, y Sofía Alday, Directora Gerente de la misma


CONAFE organizó el 11 de marzo en la ganadería La Marina de Retortillo (Rioturbio, Cantabria) el reciclaje de jueces de 2016, uno de los programas importantes de la Confederación que cada vez se nutre más de los conocimientos y recomendaciones del grupo de trabajo de jueces de la Federación Europea de asociaciones, la cual también trabaja para armonizar normas y criterios de juzgamiento con las asociaciones tanto de América del Norte como del Sur.
En esta reunión de jueces, además del juzgamiento de las cuatro secciones prácticas –fantásticamente presentadas por José Manuel Paz y sobre las que pudimos discutir en positivo–se habló de un aspecto muy importante dentro de los concursos de ganado: el bienestar animal, un tema que acapara cada vez más el interés del público y del consumidor, muy sensibilidados con estas cuestiones.
Los jueces de CONAFE son conscientes de esto y están a favor de que los concursos de ganado, además de ser una herramienta profesional de aprendizaje para los ganaderos visitantes, sean un encuentro entre ganaderos y consumidores, siendo cada vez más importante la imagen que damos de nuestro sector al público visitante.
bería servir no solo para resaltar y premiar a las




campeonas, sino también para agradecer y valorar el trabajo y calidad de los animales del resto de participantes y mostrar a la audiencia lo importante y necesaria que son la ganadería y los ganaderos para la sociedad.
¿Cómo van evolucionando las vacas?
La pregunta del millón. Hace ya años que se está viendo en la mayoría de los concursos que no ganan las vacas grandes, sino las buenas. Y la vaca, para ser buena, no debería ser muy grande, pero sí muy ancha y con fantásticas ubres, patas, grupa y estructura lechera.
Esta manera de trabajo de los jueces, que está calando últimamente más rápido entre los ganaderos, está fundamentada en los datos de longevidad, vida productiva y morfología que demuestran la importancia de valorar en la pista a los animales que reflejen la morfología de la edad que se está juzgando, sin dar más importancia de


44 Frisona Española 212 m/a

Pasión por el Rojo
El censo de hembras rojas registradas supera ligeramente las 11.000 cabezas, suponen actualmente un 1,14% del total de hembras registradas en CONAFE, a pesar de su bajo censo relativo, ¡cuántas razas tienen menos! Muchos ganaderos están interesados en mantener en sus explotaciones algunos animales rojos. La mayoría de estos animales son descendientes de vacas y toros portadores del que históricamente se ha conocido como Factor Rojo, controlado por el gen MC1R o “Receptor de la melanocortina 1” que se encuentra en el cromosoma 18. Este gen presenta en Holstein un total de cuatro alelos:
•El negro dominante (Ed)
•El negro/rojo o Telstar (EB/R) los toros que lo difundieron fueron Hanover-Hill Triple Thread-Red (USAM0001629391) con un total de 2.553 hijas registradas en España y su padre Roybrook Telstar (CANM0000288790) que dio nombre al factor. O más recientemente Maughlin Storm (CANM0005457798) y Emerald-ACR-SA T-Baxter (USAM0132973942), con más de 4.000 hijas registradas cada uno en nuestra población.
•El alelo salvaje rojo (E+) con algún portador conocido como Aggravation Lawn Boy P-Red (USAM0133080890) (Lawlor et al., 2014), que tiene actualmente 121 descendientes registrados en nuestra población.
•El recesivo rojo (e).
Entre estos alelos el orden de dominancia es Ed> EB/R> E+>e, de tal forma que todo animal que


color hacia el negro, normalmente entre los 3 y 6 meses. En la tabla 1 se presenta el genotipo (combinación de alelos), fenotipo (color de la capa) y los alelos que transmite un animal en función de las distintas combinaciones en este gen.
Con el chip de genotipado actual siguen existiendo dudas para poder distinguir los animales EB/R de los E+ No obstante se continúa trabajando para poder determinar los tres alelos por separado en el futuro.
Por lo que de momento aquellos animales genotipados con el chip Eurg10K se codifican todos como:
•HH_RDF, si están libres de cualquiera de los tres alelos rojos
•HH_RDC, si llevan una copia de alguno de ellos
•HH_R&W, si llevan dos copias.
A todos ellos se les une una nueva variante que afecta al color de la capa pero que se encuentra en otra posición del genoma completamente distinta, se trata del conocido como Variante Roja, Rosabel o Rojo Dominante, localizado en el cromosoma 3, en el gen denominado gen COPA y que actúa como dominante sobre el gen MC1R, es decir, que todos los animales que tienen al menos un alelo de esta variante serán rojos con independencia de los alelos que porten para el MC1R. El origen de esta mutación se encontró en la vaca Surinam Sheik Rosabel-Red nacida en 1980 (Dorshorst et al., 2015).
La última versión del chip de genotipado que se ha comenzado a utilizar a principios de este año incluye un marcador asociado a esta variante por lo que es posible identificar aquellos animales portadores de una o dos copias del mismo:
•Los animales que no presentan ninguna copia se identifican con el código HH_VRF
•Los portadores de una copia con el código HH_VRC
•Aquellos animales Rojos con un padre portador del gen Rosabel y cuyos padres no son ambos portadores de Factor Rojo se pueden determinar como Rojos por genealogía con el código VRR según la última actualización de Enero de 2016 de la Federación Mundial de Holstein Friesian (www.whff.info).
Gracias a la correcta identificación de estos animales está siendo posible mejorar la determinación de la presencia del factor rojo recesivo, y solventar la problemática que se planteaba con los distintos Alelos del MC1R.
Pero sin duda, la gran aportación de esta variante roja es el notable incremento en el nivel genético de los animales de capa roja. Hasta ahora, tener animales rojos suponía una limitación importante en cuanto al progreso genético, ya que la proporción de animales negros en la parte alta del ranking es muy superior.
Actualmente, el ranking de hembras genómicas rojas está encabezado por Campa Mcc Spe-
Genética
José Antonio Jiménez. Dpto. Técnico de CONAFE
46 Frisona Española 212 m/a
Bos Rubens Antia Roja ET
Capa Blanca y Negra
Capa Negra/Roja (nacen rojos y se vuelven negros)
Capa Roja

ED/ED Este animal no transmite el color rojo
ED/EB/R Este animal transmite el negro/rojo o Telstar
ED/E+ Este animal transmite el alelo rojo salvaje
ED/e Este animal transmite el alelo rojo recesivo
EB/R/EB/R Este animal no transmite el factor rojo sólo el negro/rojo
EB/R/E+ Este animal transmite también el alelo rojo salvaje
EB/R/e Este animal transmite el alelo rojo recesivo
E+/E+ Este animal sólo transmite el alelo Rojo salvaje
E+/e Este animal transmite el Rojo salvaje y el recesivo e/e Capa Roja. Este animal sólo transmite este alelo
cial Fiv Roja una novilla nacida en noviembre de 2014 que tras la valoración completa de marzo alcanza los 3805 puntos de ICO con una valoración muy compensada: 891 Kilos de Leche, 65 en Grasa 37 de Proteína, 2,16 en IPP, 2,77 en ICU y en Funcionales: 114 en Recuento, 111 en Dias Abiertos y 130 en Longevidad. Además, al ser hija de un toro probado y de una vaca genómica, la fiabilidad de la prueba es de las más altas para un animal sin datos propios, llegando a 78 en Producción y 77 en Tipo. El color rojo procede de la Variante Roja o gen Rosabel heredada de su madre SpezI 1144 ET Roja, ya que su padre De-Su BKM McCutchen 1174 ET, es un toro negro no portador de factor rojo. Obviamente, la gran ventaja de la variante Rosabel es que al ser un gen dominante es posible obtener descendencia roja a partir de los toros negros no portadores de mayor nivel genético. Buena muestra de ello es que las diez mejores hembras genómicas rojas de la población son portadoras de esta variante y no de alguno de los factores rojos del cromosoma 18. Siendo otras cinco medio hermanas maternas de la primera con los distintos acoplamientos que se realizaron sobre sus óvulos mediante fertilización in vitro. Merece atención especial la vaca colocada en la tercera posición Campa Barman Special FIV Roja ET, por dos motivos:
•En primer lugar es la mejor hembra roja hija de un toro nacional, una nueva muestra de que el nivel genético de nuestros sementales logra producir hembras que ocupan los primeros puestos de los rankings junto a las hijas de los toros de mayor reconocimiento internacional, en este caso esta Barman se encuentra entre las hijas de McCutchen, Kingboy, Defender o Megasire.
•La segunda razón para destacar a esta vaca, es por ser la madre de la actual mejor hembra genómica con edad inferior a 18 meses Campa Quixote Special, aunque en el óvulo que dio lugar a este acoplamiento no se encontraba la Variante Rosabel y por tanto la ternera es negra y tampoco transmitirá ninguna variante que pueda dar lugar a capa distinta de la negra.
Volviendo a las rojas, la propia Spezi, abuela de Campa Quixote Special se encuentra en el puesto 9 del ranking. Tras ella, volvemos a encontrarnos otras dos hijas más en los puestos 12 y 14. La otra vaca con la variante roja que aporta tres hijas entre las 10 mejores es De Volmer Epic Red Gold Roja, ocupando su mejor hija, Jacinto Kingboy Chanel Roja, el segundo puesto con 3696 puntos de ICO, en este caso con muy buena valo-


ración en producción 1039 en Kilos de Leche, 24 en Grasa y 32 en Proteina, también buena en tipo funcional con 1,64 en IPP y 2,45 en ICU y de nuevo positiva en los tres caracteres funcionales 110 en Recuento, 116 en Días Abiertos y 137 en Longevidad.
Dentro de las vacas con Factor Rojo, es decir sin el Rojo Dominante, la primera la encontramos en el puesto 11 con ICO 3157, se trata de Mono Ferreiro Radiante Roja ET, hija de dos animales negros pero portadores del factor rojo. En el puesto 13 tenemos la primera hija de un toro Rojo portador del Factor Rojo recesivo, se trata de SielmaChupa Secret Virginia con 3002 de ICO, por último la primera ternera con padre y madre rojos que no son portadores de la variante dominante es Xercas Cav Librada Prince Roja en el puesto 17 con ICO 2929.
m/a 212 Frisona Española 47
Tabla 1. Genotipo, fenotipo y factores que se transmiten a la descendencia en función de las distintas combinaciones de Alelos del gen MC1R en ganado Holstein
Campa Barman Special FIV Roja ET
Vacas rojas
Ranking de hembras genómicas rojas

Incluye
Evaluación genómica
Filiación con progenitores genotipados


*



Determinación de Genes Recesivos (BLAD, DUMPS, CVM, Citrulinemia, Mulefoot...)
Determinación de Haplotipos (HH1, HH2, HH3, HH4, HH4 HDC)
Factor Rojo
Infertilidad (Free Martin)
Polled
Proteínas (Beta Caseína, Kappa caseína, y Beta-Lactaglobulina)
Integración de esta información en el programa de Acoplamientos

48 Frisona Española 212 m/a Número Nombre ICO F.nac Factor Rojo Variante Roja Madre / Padre Capa Factor Rojo Variante Roja 1 ESPH1504152805 Campa Mcc Special Fiv Roja ET 3805 27/11/14 HH_RDF VRR Spezi 1144 ET Roja B/R HH_RDF VRR DE-SU Bkm Mccutchen 1174 ET B/N 2 ESPH3304179958 Jacinto Kingboy Chanel Roja ET 3696 27/03/15 HH_RDF HH_VRC De Volmer Epic Red Gold Roja B/R No genotipada VRR Morningview Mcc Kingboy ET B/N 3 ESPH1504050161 Campa Barman Special F Roja ET 3634 15/07/14 HH_RDF VRR Spezi 1144 ET Roja B/R HH_RDF VRR Casa de Lola XF Snow Barman ET B/N 4 ESPH3304179959 Jacinto Kingboy Cartierroja ET 3534 29/03/15 HH_RDF HH_VRC De Volmer Epic Red Gold Roja B/R No genotipada VRR Morningview Mcc Kingboy ET B/N 5 ESPH1504135959 Campa Meg. Special Fiv Roja ET 3508 01/01/15 HH_RDF VRR Spezi 1144 ET Roja B/R HH_RDF VRR Butz-Hill Megasire ET B/N 6 ESPH1504095901 Campa Defender Special Roja 3476 17/10/14 HH_RDF VRR Spezi 1144 ET Roja B/R HH_RDF VRR S-S-I Mogul Defender ET B/N 7 ESPH1504099634 Campa LG Special Red 1 Roja ET 3439 28/05/14 HH_RDF VRR Spezi 1144 ET Roja B/R HH_RDF VRR Genervations Liquid Gold ET B/N 8 ESPH1504099635 Campa LG Special Red 3 Roja ET 3401 29/05/14 HH_RDF VRR Spezi 1144 ET Roja B/R HH_RDF VRR Genervations Liquid Gold ET B/N 9 ESPH1503894133 Spezi 1144 ET Roja 3242 12/08/12 HH_RDF VRR Morsan Lis Fools-Special Redet B/R No genotipada VRC Genervations Epic ET B/N
ESPH3304079601 Jacinto B.B. Antonela Roja ET 3197 06/02/15 HH_RDF HH_VRC De Volmer Epic Red Gold Roja B/R No genotipada VRR Richmond-Fd El Bombero ET B/N RDF 11 ESPH3304182615 Mono Ferreiro Radiante Roja ET 3157 05/11/15 HH_R&W HH_VRF Tec Ferreiro Radium Redburs ET B/N No genotipada Willsbro Artwork ET B/N RDC 12 ESPH1504152800 Campa 5G Special 2 Fiv Roja ET 3031 15/10/14 HH_RDF VRR Spezi 1144 ET Roja B/R HH_RDF VRR MR Lookout Perce Alta5g ET B/N 13 ESPH4903966315 Sielma - Chupa Secret Virginia 3002 26/03/14 HH_R&W Sielma Chupa Secret Chigryns B/N No genotipada Tiger-Lily Ladd P-Red ET TL TV B/R 14 ESPH1504099637 Campa LG Special Red 2 Roja ET 2995 28/05/14 HH_RDF VRR Spezi 1144 ET Roja B/R HH_RDF VRR Genervations Liquid Gold ET B/N 15 ESPH1504258478 Campa Olympian Secret Roja 2990 13/09/15 HH_R&W HH_VRF Campa Bkw Secret Carmen ET B/N HH_RDC Ladys-Manor Olympian B/N RDC 16 ESPH2504128991 Puig Mokabi Roja 2967 17/08/15 VRR Puig Surf 55 Gregoria B/N No genotipada Mokabi Red ET B/R VRC
ESPH2704092317 Xercas Cav Librada Prince Roja 2929 11/11/14 HH_R&W Xercas Cav Libra Debutant Roja B/R No genotipada Blumenfeld De Prince Red ET B/R
10
17
Nuevos PRECIOS
Las muestras se cobrarán todas a 45 € y al finalizar el año se abonará la diferencia a los ganaderos que genotiparon toda la recría.

¿Realmente puedes dejar pasar un toro irrepetible?
Nº 1 NVI 398 10% Salud 12% Eficiencia 1.241 Kg. Leche Kappa Caseína BB Persistencia 110 Ubres 110 Patas 107 Tipo 110 Nº 1 - Top Mundial Longevidad 1.147 días Excelente Fácil parto 108 Salud ubre 113 Recuento células 113 CRV GENETICS ESPAÑA, S.L. Oro, 32 - nave 14 - Pol. Ind. Sur • 28770 Colmenar Viejo (Madrid) T 91 803 42 79 E crvinfo@crv4all.es W www.crv4all.es • www.global.crv4all.com Bouw Finder UN TORO ÚNICO
Bouw Finder Balisto x Epic
G e n é t i c a Familias de vacas españolas
Ania
La familia de vacas Rojas que mejoran con los par tos
En esta edición que estamos dedicando a las vacas Rojas, no podía faltar una familia de vacas españolas como la de Ania, una vaca que ha dejado más de veinte hijos registrados
Bos Rubens Antia Roja
El 2 de junio del 2000 nace en la Unidad de Transferencia Embrionaria de Bos una preciosa y estilosa ter nera roja procedente de un embrión de una de la donadoras allí presentes, Bos Factor Antia RC Et Esta ter nera se llama Antia
Antia procede de una de las más famosas familias de vacas rojas en EEUU en aquel momento, la familia Scarlette Red Su madre, procedente de un embrión importado de EEUU Bos Factor Antiga Rc ET MB-87 de primer parto, posee el gen que le aporta la capacidad de transmitir la capa roja a su descendencia y es cruzada con el toro también factor rojo que más destacaba en aquel momento, STBVQ Rubens RC y de ese cruce nace Antia
Por detrás de Antiga podemos encontrar a las vacas americanas SFL Aerostar Letti RC MB-87 2 años; S-F-L Enhancer Scar lette-Red MB-89 2* GMD DOM; Stookey Fagn Scar let-Red ET EX 3E; Continental Scar let-Red EX95-3E GMD y Wood Echo Designed For Duty BB-82 2* Estas vacas se encuentran

 José Antonio Jiménez. Dpto. Técnico de CONAFE
José Antonio Jiménez. Dpto. Técnico de CONAFE
en los orígenes de varios toros de inseminación rojos, por ejemplo una de las mejores hembras rojas y polled por GTPI como Verghagens Bos Candelight P-Red
Crece muy bien y lleva un gran desarrollo para su edad, con mucha calidad y buen tamaño, nos comenta Javier Álvarez Lastra que trabajaba en Bos en el momento en que nació Antia y a quien agradecemos su colaboración en este artículo.
Antia es calificada MB-87 en el primer parto; MB-89 en el segundo y Excelente en el tercero Destacaba en capacidad con 94 puntos, 94 en Estructura y capacidad, 90 en Estructura Lechera, 90 en grupa, 88 en Patas y Pies y 89 en Sistema Mamario En sus tres lactaciones logró una producción total de 49.803 Kilos de leche. Actualmente tendría una valoración por ICO de 1955 puntos, que es el nivel medio de las vacas nacidas entre los años 2011 y 2012, es decir más de una década después
No era una muy buena donadora, por lo que no tiene mucha descendencia directa; si no ha tenido muchas hijas sí cuenta con un número importante de nietas. De sus doce descendientes sólo tres serían hembras, destacando Bos Talent Ania Roja
Bos Talent Ania Roja
Nacida en 2006 y dada de baja hace ahora un año, Ania es, sin duda, la vaca clave de esta familia En cuanto a su mor fología fue calificada MB-87 puntos con 89 puntos en Estructura y Capacidad; 85 en Estructura Lechera; 85 en Grupa, 86 en Patas y Pies y 86 en Sistema Mamario
En cuanto a su producción, esta se vio afectada al convertirse en donante de embriones, por lo que sólo completó tres lactaciones
Tras la evaluación de Noviembre de 2015 su valor ICO era de 1986 destacando en ICU con 1 95 Su valor radica en la gran cantidad de descendientes que ha dejado; en total se han registrado 23 hijos suyos: 11 machos y 12 hembras De estas comentaremos las cuatro que han dejado mejores descendientes Bos Rampage Red Ancora Roja, Bos Xercas Cav Law Roja, Bos Agror tegal Ani Roja y Bos Teixeiro M Bur ns Lorena, que han producido en cuatro ganaderías distintas
Bos Rampage Red Ancora Roja TL TV TD
Esta hija de Ania también fue donante de embriones, dejando un total de seis productos regis-
50
212 m/a
Bos Talent Ania Roja
Frisona Española
trados en la ganadería lucense Quintián, S.C.
Su calificación final fue de BB-81 y su producción vitalicia de 24 969 kilos de leche Su valor ICO actual de 1955, similar por tanto al de sus antecesoras Entre sus descendientes que mantienen la capa roja tenemos a tres hijas, cada una de ellas también con sus descendientes rojas
La mejor descendencia de Ancora por nivel genético la for man su hija Quintian Baxter Ancora II Roja –con ICO 2472, mejorando notablemente sus valores en producción y manteniendo un 1,58 en IGT– y sus nietas Quintian Leon Rojo Lea 8915, con ICO 2631, y Quintian Colt P-Red Rosa Roja, con más de 11 000 kilos en primera lactación, 86 puntos en calificación total y 2745 puntos de ICO Rosa además ya tiene una hija –Quintian Lado P-Red Laka Roja– que a partir del índice de pedigrí mantiene el nivel de su madre.
Bos Xercas Cav Ana Law Roja ET
Esta hija de Ania, nacida en Cavadas S A T Xuga 941 en 2010, alcanzó la calificación final de MB-86, con 88 puntos en Estructura y Capacidad; 86 en Estructura Lechera y 85 en Grupa Patas y Pies y Sistema Mamario, mejorando notablemente en su segundo parto. Lleva producidos 42.557 kilos de leche en tres lactaciones y tiene un valor ICO de 2209 De las tres descendientes de Ana, todas ellas rojas, destacan su hija Xercas Cav Anita Jotan Roja y su nieta Xercas Cav Anima One Red Roja, que por su índice de pedigrí tendría un valor genético en ICO de 2544 La otra hija activa es Xercaspor ta Anuska Roja, nacida en 2014.
Bos Agror tegal Ani Roja ET
Ani, la tercera hija destacada de Ania, nació en 2010 y también mejoró su calificación en segundo parto –lo que parece ser un sello de esta familia– llegando a los 85 puntos Su producción vitalicia actual se encuentra en los 41 353 kilos de leche, tras 71 días en su cuarta lactación. En cuanto a valores genéticos, tiene 2383 puntos de ICO con 1,55 en IPP; 1,4 en ICU; 930 kilos de Leche y 30 de Proteína
Ya ha dejado dos hijas en Granxa Vidueira, su explotación de nacimiento La primera de ellas, Agror tegal Ania Roja Duka, es una vaca genómica con un valor ICO de 2226 que ya tiene tres descendientes mediante transferencia de embriones, de ellos dos hembras: Agror tegal Aina R. Ladd P Roja, con ICO genómico 2315, y Agror tegal Antiga Kanu Roja, también genotipada, que con 2495 de ICO tras la valoración de Marzo de 2016, se convierte en la hembra de mayor potencial genético de la familia
La segunda hija de Ani –Agror tegal Antigua Ar temi Roja– nació en 2015 también dentro del programa genómico de la ganadería, y tiene un valor ICO de 2310 puntos
Bos Teixeiro M Bur ns Lorena ET TL TV TD
La cuarta hija de Ania que comentamos, nació en S A T Teixeiro en 2008, y aunque es portadora del Factor Rojo no es roja Lorena ha mantenido el nivel mor fológico de sus predecesoras alcanzado una calificación final de MB-87 puntos, de nuevo mejorando en segundo parto
Su producción ya va por 71 290 kilos tras cinco lactaciones finalizadas y 142 días de la quinta Su valor genético la sitúa en 2590 puntos de ICO con un extraordinario 2,2 en IPP También se ha utilizado como donante de embriones por lo que ya tiene un total de 11 descendientes genotipados
Animales más destacados de...

Bos Factor Antiga ET

Familia ANIA

Bos Rubens ANTIA Roja ET ESPH1501692932
Bos Talent ANIA Roja


ESPH1502706752


Bos Rampage Red ANCORA Roja
ESPH1503047681

Quintian Infrar Anyi Roja ET
Quintian Ladd P-Red Lassy Rojo
Quintian Infrar Chispa Roja ET

Quintian Ladd Lapia 8906 Roja

Quintian Leon Rojo Lea 8915
Quintian Colt P-Red Rosa Roja
Quintian Lado P-Red Laka Roja

Bos Xercas Cav ANA LAW Roja ET

Xercas Cav Anita Jotan Roja
Xercasporta Anuska Roja ET
ESPH2703274893

Xercas Cav Anima One Red Roja


Bos Agror tegal ANI Roja ET
Agrortegal Ania Roja Duka Roja
Agrortegal Antiga Kanu Roja ET
Agrortegal Aina R Ladd P Roja
Agrortegal Antigua Artemi Roja

Bos Teixeiro M Bur ns LORENA ET
Teixeiro Mccutchen Luna Fiv ET
Teixeiro Mccutchen Lora Fiv ET
Teixeiro Bar man Atenea
ESPH1503266163


ESPH2703020929

incluyendo el toro de inseminación Rey Loro que sí es homocigoto para el Factor Rojo
Entre las hijas de Lorena, que como hemos dicho están todas genotipadas, destacan Teixeiro Bar man Atenea con 2767 de ICO-G y las her manas completas Teixeiro Mccutchen Luna (ICO 2906) y Teixeiro McCutchen Lora (ICO 2908), que son los animales de mayor nivel de la familia Tras su genotipado, también sabemos que Lora es portadora del Factor Rojo, por lo que podrá continuar la saga de vacas Rojas de esta familia
Quintian Baxter Ancora II Roja
Bos Factor Antiga ET


m/a 212 Frisona Española 51
Genómico
¿Podemos genotipar a buenos precios?
CONAFE como Federación de Asociaciones de Ganaderos debe ofrecer a sus socios herramientas que les permitan aprovechar las ventajas que los avances técnicos y científicos aportan al sector al menor coste posible.
En el siguiente cuadro se comparan la información suministrada y el precio públicado en las web de CONAFE
http://www.conafe.com/genomica.aspx y Holstein USA http://www.holsteinusa.com/programs_services/genomics.html
A la vista de esta tabla creemos que el ganadero aso-
Servicios
ciado tiene a este respecto una situación muy ventajosa ya que dispone de acceso a la información más completa que se puede tener en la actualidad, a un precio altamente competitivo y con un servicio integrado en su programa de mejora.

En esta sección tratamos de dar respuesta a las preguntas que van surgiendo en relación con la selección genómica. Os animamos a enviar vuestras preguntas a: conafe@conafe.com referencia “Consultorio Genómico”
Recría Genómica CONAFE
Valoración Genómica
(Fiab. ≈ 70% con más de 25,000 toros probados como Población de Referencia)
Verificación de Parentesco
Arreglo de genealogías
Misma escala que el resto de animales
Mejora de la fiabilidad de los índices de pedigrí de la descendencia
Integración en SINBAD y CONAFEMAT
Posibilidad de descarga de datos genómicos y tradicionales para programas de acoplamiento externos
Citrulinemia
Brachyspina***
Holstein USA Cliente Internacional
41€ 45€ (Muestra suelta) 68$ (60€)**
Incluido* +48$ (42.37€)**
Incluido No
Incluido No
Mejora de la fiabilidad de las valoraciones genómicas por el uso de los datos de la granja Incluido No
Incluido No
Incluido No
Incluido No
Incluido No
Incluido +30$ (26.48€)**
CVM Incluido +40$ (35.31€)**
Polled
Beta Caseina
Presencia de genes de macho (Infertilidad)
BLAD, DUMPS, PIE DE MULA
Incluido +40$ (35.31€)**
Incluido +20$ (17.66€)**
Incluido ¿?
Haplotipos I,II,III,IV,V,HDC Incluido ¿?
Incluido Incluido
Color (Rojo dominante y recesivo) Incluido Incluido
Beta lactoglobulina y Kappa caseína

Incluido Incluido
TOTAL 41€ 45€ (Muestra suelta) 246$ (217.13€)**
(*) Cuando los padres están genotipados. (**) Cambio Euro/Dólar a 30 de Marzo de 2016. (***) Los resultados para Brachyspina han sido suministrados por Xenética Fontao, S.A. (Laboratorio de Genética Molecular) Bajo licencia (Copyright © Université de Liége/University of Copenhaguen).
Recogida de datos de facilidad de parto
Los datos de facilidad de parto procedentes del control lechero actuales sufren un fuerte proceso de depuración, perdiéndose una buena parte de la información. Para homogeneizar el criterio de clasificación del tipo de parto, se ha reali-
zado una tabla con el consenso de las Asociaciones autonómicas con el fin de que la toma del dato por los ganaderos y técnicos sea más clara y estandarizada que el actual, independientemente de dónde se tome el dato.

Clasificación de los datos de facilidad de parto en 5 categorías en función del tipo de parto producido
Tipo Categoría Clase Definición Características
Partos eutócicos Fácil 1 Parto sin ayuda
Partos distócicos Ligera dificultad 2 Ligera ayuda
Difíciles

3 Tracción fuerte
4 Cesárea o fetotomía con presentación normal.
5
Presentación anormal del ternero
•La vaca ha parido sola sin ayuda ni problemas.
•Partos no observados:
-la vaca ha parido en ausencia del ganadero. -el ternero y la madre están sanos.
•Hay una pequeña ayuda para que el ternero nazca.
•El ternero hubiera nacido sin intervención humana.
•Se necesita una ayuda prolongada en el tiempo, a veces con intervención de más de una persona.
•Se puede necesitar tracción mecánica para ayudar al feto a salir.
•Para que el ternero o la vaca puedan sobrevivir hay que operar.
•Presentación anormal del ternero que puede originar cualquiera de las intervenciones anteriores.
Consultorio


Introducción
La evaluación genómica de Marzo incluía la evaluación de todos los genotipos disponibles con

El listado de hembras genómicas menores de 18 meses tras la evaluación mensual de Marzo 2016 (Tabla 1) presenta hasta siete novedades: •En primer lugar tenemos que resaltar a, A Campa Quixote Special ET, con un ICO genómico de 4355 a partir de un valor genómico directo de 4468 y un extraordinario índice de pedigrí de 4077. Debemos destacar que esta ternera líder del ranking es producto de un gran trabajo aplicando las tecnologías que tenemos disponibles en mejora genética. Su madre ya fue un producto de fertilización in vitro en un acoplamiento con BARMAN uno de los primeros toros genómicos españoles nacido en 2012. De aquí nació en julio de 2014, Campa Barman Special F Roja ET que a su vez se convirtió en donante de embriones en un acoplamiento con otro toro del programa nacional Quixote, que se ha mantenido en el número uno del ranking durante varias evaluaciones. De hecho este ha sido el producto de la primera dosis utilizada de este toro también nacido en 2014. Un ejemplo claro de cómo la genómica está permitiendo acelerar

Nº Número Nombre Año nac. I. Pedigrí ICO VGD ICO ICO Ganadería 1 ESPH1504263641 Campa Quixote Special ET 2016 4077 4468 4355 S.A.T. A Campa 2 ESPH1704121723 Gener Bluba Bomero 1389 ET 2015 3576 4608 4332 Mas Gener S.C.P. 3 ESPH3304182693 Facio Silver Leonela 2015 3828 4439 4259 Ganaderia Facio Holstein 4 ESPH1704121719 Gener Touchdown Blisa 1377 ET 2015 3384 4438 4234 Mas Gener S.C.P. 5 ESPH1504256582 San-Rian Jenna Silver 2015 3711 4341 4166 San Rian Sdad.Coop.Galega 6 ESPH1704028866 Gener Tuchdown Bulma 1367 ET 2014 3384 4378 4159 Mas Gener S.C.P. 7 ESPH2704202105 Cochero Mccutchen Carola ET 2015 3769 4307 4155 Casa Cochero 8 ESPH1704127686 Gener Touchdiwn Blusa 1376 ET 2014 3384 4301 4127 Mas Gener S.C.P. 9 ESPH2704210409 Lodos Halogen Merche 2015 2953 4380 4083 S.A.T. Lodos E Pérez N.940 Xuga 10 ESPH1504101253 San-Rian Sandy Lancome ET 2015 3160 4315 4078 San Rian Sdad.Coop.Galega 11 ESPH1504101223 San-Rian Senda Mccutchen 2015 3349 4271 4076 San Rian Sdad.Coop.Galega 12 ESPH0804028141 Cavalleria Mogul Medula 2014 2936 4472 4070 Mas La Cavalleria 13 ESPH0804230593 De-Su Tri Georgie ET 2014 3673 4128 4048 Ramaderia Can Thos, S.L. 14 ESPH0804232471 Cavalleria Wickam Nyicla 2015 3821 4119 4043 Mas La Cavalleria 15 ESPH0804129868 Cavalleria Bombero Gruna 2015 3652 4177 4042 Mas La Cavalleria 16 ESPH2704202289 Cochero Elude Karina 2015 3765 4118 4033 Casa Cochero 17 ESPH0804233964 Cavalleria Wickham Vira 2015 3569 4146 3996 Mas La Cavalleria 18 ESPH2704205576 Xercas Cav Elvi Montros 2015 3848 4022 3961 Cavadas S.A.T. Xuga 941 19 ESPH1504103892 Lscg 121 Mccutchen 2015 3604 4117 3958 Landeira Sdad.Coop.Galega 20 ESPH2704221458 Cochero Pure Puri ET 2015 3654 4029 3939 Casa Cochero Valoración genómica: Evaluaciones de las mejores novillas genómicas con edad inferior a 18 meses Nuevas pruebas y nuevas novillas Genética Departamento Técnico de CONAFE 54 Frisona Española 212 m/a Tabla 1. Listado de las 20 mejores novillas genómicas españolas de menos de 18 meses según su ICO tras la evaluación de Marzo 2016 Campa Quixote Special ET
el progreso genético acortando dramáticamente el intervalo generacional, todos los abuelos y abuelas de Special, tienen hoy menos de cuatro años. Además es una nueva prueba de que la genética española es muy competitiva ya que estas pruebas genómicas evalúan con la misma escala y metodología a las hijas de todos los toros independientemente de su origen. Además se ha dado la casualidad de que los orígenes de Special son vacas Rojas con el gen Dominante o Rosabel, cuya determinación está disponible junto a las evaluaciones genómicas desde enero de 2016. •La siguiente entrada la tenemos en el puesto 5º, San-Rian Jenna Silver, con un valor GICO 4166. El resto de incorporaciones también pertenecen a algunas de las ganaderías habituales en este listado como son: Cavallería Wickam Nyicla, Cavallería Bombero Gruna y Cavalleria Wickham Vira, en los puestos 14, 15 y 17, Xercas Cav Elvi Montros en el 18 y Cochero Pure Puri ET en el 20.
TOP 5 en Kilos de Leche
El ranking por kilos de leche sigue encabezado de manera destacada por BLISA con 2583 tras ella también se mantiene Xercas Cav Elvi Montross




Número Nombre Año Nac. GICO Kg. Gras. ESPH0504086520 HS Mccutchen Diam 2015 3506 99 ESPH2404272035 Hnos.Fuertes Agata Silver 2015 3689 95 ESPH1504145906 San-Rian North Megasire 2015 3612 93 ESPH2404272034 Hnos.Fuertes Juncal Silver 2015 3524 91 ESPH1704127250 Ray Silver Prudence 426 ET 2015 3684 90 Número Nombre Año Nac. GICO Kg. Prot. Número Nombre Año Nac. GICO Kg. Leche ESPH1704121719 Gener Touchdow Blisa 1377 ET 2015 4234 2583 ESPH2704205576 Xercas Cav Elvi Montros 2015 3961 2269 ESPH2504128891 Parra Littleton 837-963 2015 3758 2140 ESPH1704028866 Gener Tuchdown Bulma 1367 ET 2014 4159 2096 ESPH1704230927 Gener Bifo Kingboy 1428 2015 3874 2080
18
Tabla 3. 5 mejores novillas genómicas españolas de menos de
meses por Kilos de Grasa tras la evaluación de Marzo
2016
Tabla 4. 5 mejores novillas genómicas españolas de menos de 18 meses por Kilos de Proteína tras la evaluación de Marzo 2016
Tabla 2. 5 mejores novillas genómicas españolas de menos de 18 meses por Kilos de Leche tras la evaluación de Marzo 2016
... mejores novillas genómicas con edad inferior a 18 meses
Agata Silver con 95 Kilos en el cuarto Hnos Fuertes Juncal Silver (Tabla 3).
TOP 5 en Kilos de Proteína
La tabla de proteína sigue encabezada por Noray, y la única entrada la tenemos en el puesto 5º, Cundins XF Beauty Balisto (Tabla 4).
Tabla 5. 5 mejores novillas genómicas españolas de menos de 18 meses por IPP tras la evaluación de Marzo 2016






TTOP 5 en IPP
En Patas tras la nueva evaluación se mantiene Bidarte B Gold Chip con 2.82 sube al segundo puesto Cavalleria Salnes Poltra y entran Anibal Silver Limbo y Arenas Siberia Mccutchen (Tabla 5).
TOP 5 en ICU
El listado ICU, la nueva ternera que lo lidera es GEL 892 Commander Sarah ET y como nueva entrada tenemos a Manolero Doorman Zendra en el quinto puesto (Tabla 6).
TOP 5 en RCS
A pesar de la nueva valoración el ranking por recuento mantiene a las mismas cinco terneras encabezadas por Campo 0248 Caviar ET (Tabla 7).
TOP 5 en LONGEVIDAD
En el listado por longevidad se intercambian posiciones las dos terneras de LODOS y tras la nueva evaluación Copa con 146 encabeza la lista. La nueva incorporación es Gener Jacey Ariadna 1361 en el cuarto puesto (Tabla 8)..
TOP 5 en DIAS ABIERTOS
Copa también lidera el listado por Dias abiertos en el que entran Campa Olympian SecretRoja y Lodos Halogen Merche (Tabla 9).
TOP 5 en IGT
El listado por Índice general de Tipo también presenta novedades la nueva número uno es Campa Atwood Brenda con 3.65 seguida de Gel 892 Commander Sarah ET con 3.72 (Tabla 10).
Ganaderías con más novillas en el Top 200 por ICO tras el genotipado
Las 200 mejores novillas genómicas de menos de 18 meses tras la evaluación completa de marzo tienen un nivel medio para el valor genómico combinado de 3712, mientras que el nivel genómico en ICO para entrar en entre las 200 mejores terneras del Ranking está en 3514, por encima de este nivel un selecto grupo de catorce ganaderías logran colocar al menos cuatro terneras, por encima de este nivel tenemos también 93 hembras de más de 18 meses.
En esta ocasión Mas Gener S.C.P. encabeza la lista con 19 hembras y un ICO medio de 3792, con ese mismo número de terneras se mantiene Ramaderia Can Thos S.L. Respecto al listado anterior entran Casa de Baixo, Cooperativa Behi-Alde y S.A.T. Arenas Nº 39119 con 4 terneras cada una.
Tabla

Número Nombre Año Nac. GICO ICU ESPH0804233983 Gel 892 Commander Sarah ET 2015 3546 3,71 ESPH3304175201 Venturo Mccutchen Romina 2015 3629 3,70 ESPH1504051821 C.A.P. 3510 San-Rian Alta5g ET 2014 3915 3,65 ESPH2704150185 Xercas Cav Hopela Doorman ET 2015 3666 3,60 ESPH3304079919 Manolero Doorman Zendra 2015 3530 3,52 Número Nombre Año Nac. GICO RCS ESPH1504208678 Campo 0248 Caviar ET 2015 3895 136 ESPH1504216110 Grille Doorman Quintana 728 ET 2015 3259 134 ESPH3904063935 Somalera Katy Doorman 2014 3027 133 ESPH0103983704 Behi-Alde Doorman 6611 2014 3429 132 ESPH3904163093 Llera Doorman Belsita 2015 3177 132 Número Nombre Año Nac. GICO Lon. ESPH2704210403 Lodos Halogen Copa 2015 3126 146 ESPH2704210409 Lodos Halogen Merche 2015 4083 144 ESPH0504191534 HS Plabelma Melani ET 2015 3644 144 ESPH1704028888 Gener Jacey Ariadna 1361 2014 3607 143 ESPH2704259587 Neerduist Abella 2014 3622 142 Número Nombre Año Nac. GICO Días Abie. ESPH2704210403 Lodos Halogen Copa 2015 3126 131 ESPH1404116094 Cafpal Golan 987 2014 2757 130 ESPH1504258478 Campa Olympian Secret Roja 2015 2990 127 ESPH2704210409 Lodos Halogen Merche 2015 4083 126 ESPH3404190633 Senadas DN Duncan 2015 2845 125 Número Nombre Año Nac. GICO IGT ESPH1504257421 Campa Atwood Brenda ET 2015 2734 3,65 ESPH0804233983 Gel 892 Commander Sarah ET 2015 3546 3,62 ESPH2704150185 Xercas Cav Hopela Doorman ET 2015 3666 3,58 ESPH3304175201 Venturo Mccutchen Romina 2015 3629 3,53 ESPH2704252113 Baixo Dempsey Matrix 2015 2751 3,47
5 mejores novillas genómicas españolas de menos de 18 meses por ICU tras la evaluación de Marzo 2016
Tabla 6.
mejores
genómicas españolas
menos
18
Tabla 7. 5
novillas
de
de
meses
por
RCS
tras la evaluación de Marzo 2016
Tabla 8. 5 mejores novillas genómicas españolas de menos de 18 meses por Longevidad tras la evaluación de Marzo 2016
genómicas
meses por Días Abiertos tras la evaluación
Tabla 9. 5
mejores novillas
españolas de menos de 18
de Marzo 2016
Ganadería ICO Medio Novillas TOP 200 Mas Gener S.C.P. 3793 19 Ramaderia Can Thos, S.L. 3683 19 Mas La Cavalleria 3784 12 San Rian Sdad.Coop.Galega 3756 12 Landeira Sdad.Coop.Galega 3685 10 Casa Cochero 3881 7 S.A.T. A Campa 3765 7 Cunordam, S.C. 3642 6 S.A.T. Etxalde 3668 5 S.A.T. Lodos E Perez N.940 Xuga 3672 5 Casa de Baixo 3586 4 Cooperativa Behi-Alde 3684 4 S.A.T. Arenas Nº 39119 3625 4 S.A.T. Candesa 3760 4
Tabla 10. 5 mejores novillas genómicas españolas de menos de 18 meses por IGT tras la evaluación de Febrero 2016
Número Nombre Año Nac. GICO IPP ESPH2004228502 Bidarte B Gold Chip 6777 2015 2761 2,82 ESPH0804031756 Cavalleria Salnes Poltra 2015 3136 2,62 ESPH2504126707 Anibal Silver Limbo 2015 3679 2,57 ESPH1504056847 San-Rian Jerdy Mccutch Fiv ET 2014 3626 2,55 ESPH3904060728 Arenas Siberia Mccutchen ET 2014 2874 2,50
11. Ganaderías con 4 o más terneras entre las 200 mejores tras la
evaluación de Noviembre de 2015
56 Frisona Española 212 m/a
insiderH2e mogul x freddie x toystory

« MORFOLOGIA CON FUNCIONALES »
+2489 gTPI
Patas +3,28 gFLC
Ubre +2,21

Dairy, Beef and Biotechnologies
JetsetH2e doormaN x ermesH2e x asHlar

«
inputH2e supersire x Niagra x roumare

+776 gNM$
+58 Prot y +87 Fat
Fertilidad +1,9 DPR
eloane, madre de iNsiderH2e
galaway, madre de iNputH2e en segunda lactación
EL ÉXITO EUROPEO DE UNA FAMILIA DE VACAS FRANCESA »
EVOLUTION IBERICA Maragatos, 75 - 49600 Benavente +34 980 63 04 97 sersia@sersia.net
« ¡EXCELENTE! »
206 gISU 37 gntM 310 gnvI 153 gPFI 159 gRZG 4576 gICO
Hougane, madre de JetsetH2e
Nuevos toros en reparto
A continuación aparecen –ordenados alfabéticamente por su nombre corto–los nuevos toros puestos en reparto facilitados por los centros de Inseminación Artificial españoles propietarios de los mismos.
La información de cada animal es la registrada en el Libro Genealógico de CONAFE.
En la primera línea aparecen el nombre completo del toro y los caracteres recesivos; la fecha de nacimiento; el código de IA y el número genealógico.
En la segunda y tercera línea, se muestran los índices genéticos correspondientes a las últimas

Claves de caracteres recesivos
BLAD Libre BLAD BLF
Portador BLAD BLC
BULLD Libre Bulldog BDF
Portador Bulldog BDC
CVM Libre CVM CVF
DUMPS
Brachyspina
Portador CVM CVC
Libre DUMPS DPF
Portador DUMPS DPC
Libre Brachyspina BYF





Genética
58 Frisona Española 212 m/a (pasa pág. 60) Chiffon JAGGER ET BLF CVF BYF 12/10/14 A11905 ESPM9204241094 Índices kg Leche kg Grasa kg Prot. IPP ICU RCS Long. DA GICO ESP-16/02 1170 41 49 1,83 2,23 117 130 109 3921 DE-SU ALTAJACKMAN ET USAM0070625846 FLEVO GENETICS SNOWMAN NLDM0388965513 LARCREST MS CHIFFON ET USAH0057187361 DE-SU 521 BOOKEM ET USAM0066636657 Importado Aberekin, S.A. Inicio reparto: enero 2016 Bailey BROOKLYN BLF CVF BYF 15/01/15 A11907 ESPM9204185760 Índices kg Leche kg Grasa kg Prot. IPP ICU RCS Long. DA GICO ESP-16/02 1094 30 41 1,69 2,43 125 127 107 3795 DE-SU 521 BOOKEM ET USAM0066636657 ENSENADA TABOO PLANET ET USAM0060597003 DE VOLMER BAILEY NLDH0535240977 MAPLE-DOWNS-I G W ATWOOD ET CANM0008956379 Importado Aberekin, S.A. Inicio reparto: enero 2016 FiMgueira Maneiro BOTON ROJO ET 29/12/14 1HO1288 ESPM2704057941 Índices kg Leche kg Grasa kg Prot. IPP ICU RCS Long. DA GICO ESP-16/02 872 69 28 0,49 1,79 123 127 93 3137 MANEIRO XF AIMAN SNOWMAN ET ESPM1503783284 FLEVO GENETICS SNOWMAN NLDM0388965513 FIGUEIRA INFRAR. DISI ROJA ET ESPH2703796412 MICHERET INFRAROUGE RED ET CANM0103366695 S.C. Figueira Xenética Fontao, S.A. Inicio reparto: 1ª tanda 2016 Ochenta Defender DEMAX ET 16/02/15 1HO1291 ESPM1404115546 Índices kg Leche kg Grasa kg Prot. IPP ICU RCS Long. DA GICO ESP-16/02 1206 44 46 0,97 2,69 119 123 98 3684 S-S-I MOGUL DEFENDER ET 840M3009554569 MOUNTFIELD SSI DCY MOGUL ET 840M3006972816 OCHENTA MASCALESE DECANA ET ESPH1403769273 ZANI BOLTON MASCALESE ET ITAM7990516801 Huerta El Ochenta Xenética Fontao, S.A. Inicio reparto: 1ª tanda 2016

MILLENNIUM McCutchen x Hero x Outside 3 Único toro disponible de la raza, superior a +3,50 tipo y +1500 leche DISTRIGEN HOLSTEIN S.L. Ansoain (Navarra) distrigen@distrigen.es Tel. 649 466 728 / 689 233 030 www.tag-by-st.com / www.tagspain.es Madre: Ronelee Hero Donalynn MB-86 Spain
Nuevos Toros en reparto









Thos President DORIO ET 18/02/15 1HO1293 ESPM0804120381 Índices kg Leche kg Grasa kg Prot. IPP ICU RCS Long. DA GICO ESP-16/02 1291 45 34 0,62 2,42 102 132 111 3526 L-L-M-DAIRY PRESIDENT ET USAM0071640112 AMIGHETTI NUMERO UNO ET ITAM7990915143 GREEN-VALLEY K-L MO DORIA ESPH0803849727 MOUNTFIELD SSI DCY MOGUL ET 840M3006972816 Ramaderia Can Thos, S.L. Xenética Fontao, S.A. Inicio reparto: 1ª tanda 2016 Campa Special FIVE ROJO ET 27/10/14 1HO1277 ESPM1504057900 Índices kg Leche kg Grasa kg Prot. IPP ICU RCS Long. DA GICO ESP-16/02 438 26 25 1,55 2,78 112 130 103 3183 MR LOOKOUT PERCE ALTA5G ET USAM0071302858 HAMMER-CREEK ALTAKOOL ET USAM0066760497 SPEZI 1144 ET ROJA ESPH1503894133 GENERVATIONS EPIC ET CANM0011104016
Can Thos, S.L. Xenética Fontao, S.A. Inicio reparto: 1ª tanda 2016 JBToullec JALLET 02/09/14 1HO1272 ESPM9204208983 Índices kg Leche kg Grasa kg Prot. IPP ICU RCS Long. DA GICO ESP-16/02 592 44 31 0,87 4,19 124 135 97 3691 MR LOOKOUT PERCE ALTA5G ET USAM0071302858 HAMMER-CREEK ALTAKOOL ET USAM0066760497
Ramaderia
FRAH2934544317 LIRR DREW DEMPSEY USAM0061083609 Importado Xenética Fontao, S.A. Inicio reparto: 1ª tanda 2016 Campa JASAN ROJO ET 30/06/14 1HO1263 ESPM1503999956 Índices kg Leche kg Grasa kg Prot. IPP ICU RCS Long. DA GICO ESP-16/02 592 44 31 0,87 4,19 124 135 97 3691 COYNE-FARMS JABIR ET USAM0070801850 MARBRI FACEBOOK ET CANM0010847042 SPEZI 1144 ET ROJA ESPH1503894133 GENERVATIONS EPIC ET CANM0011104016 S.A.T. A Campa Xenética Fontao, S.A. Inicio reparto: 1ª tanda 2016 KOMBO ET BLF CVF 29/10/14 1HO1278 ESPM9204108003 Índices kg Leche kg Grasa kg Prot. IPP ICU RCS Long. DA GICO ESP-16/02 1574 41 62 0,81 2,44 116 125 88 3887 ROCKING-P GRAF LOTTIE DA ET USAM0071360373 LADYS-MANOR RD GRAFETTI ET USAM0068988032 BRITNEY DEUH0355600688 MOUNTFIELD SSI DCY MOGUL ET 840M3006972816 Importado Xenética Fontao, S.A. Inicio reparto: 1ª tanda 2016 Thos Kanu MAG P 31/01/15 1HO1290 ESPM0804031087 Índices kg Leche kg Grasa kg Prot. IPP ICU RCS Long. DA GICO ESP-16/02 1790 15 43 1,04 2,46 104 123 93 3571 WILDER KANU P RED ET TL TV DEUM0537116129 SANDY-VALLEY COLT P-RED USAM0068731810 THOS MERIDIAN MARIANA ESPH0803764806 SULLY HART MERIDIAN ET USAM0069951907 Ramaderia Can Thos, S.L. Xenética Fontao, S.A. Inicio reparto: 1ª tanda 2016 MARK 1182 Farrapa 5G Fiv ET 09/02/15 1HO1295 ESPM1504057961 Índices kg Leche kg Grasa kg Prot. IPP ICU RCS Long. DA GICO ESP-16/02 460 40 25 1,2 3,77 125 141 116 3801 MR LOOKOUT PERCE ALTA5G ET USAM0071302858 HAMMER-CREEK ALTAKOOL ET USAM0066760497 HUIJBEN DG UNOALX 7569 ESPH1503992244 AMIGHETTI NUMERO UNO ET ITAM7990915143 S.A.T. A Farrapa Xenética Fontao, S.A. Inicio reparto: 1ª tanda 2016 MONCELOS BLF CVF 22/12/14 1HO1286 ESPM9204208985 Índices kg Leche kg Grasa kg Prot. IPP ICU RCS Long. DA GICO ESP-16/02 1531 57 50 0,95 2,28 118 134 106 4049 MOLOTOV DEUM0666188939 MOUNTFIELD SSI DCY MOGUL ET 840M3006972816 WEU AMELI DEUH0355483228 GENERVATIONS EPIC ET CANM0011104016 Importado Xenética Fontao, S.A. Inicio reparto: 1ª tanda 2016 PB XF NEIPIN ET 12/09/14 1HO1273 ESPM2704057916 Índices kg Leche kg Grasa kg Prot. IPP ICU RCS Long. DA GICO ESP-16/02 1156 49 37 1,12 1,16 115 129 116 3499 PINE-TREE OHARE P ET USAM0071178706 CO-OP O-STYLE OMAN JUST ET USAM0137611441 VIVA DIVINIA NLDH0869250705 LADYS-MANOR PL SHAMROCK ET USAM0068977120 Portelo-Barbas, S.C. Xenética Fontao, S.A. Inicio reparto: 1ª tanda 2016 60 Frisona Española 212 m/a (pasa pág. 62)
DEMPSEY-CHERRYGIRL ET
BAJADA DE DEFENSAS EN EL PERIPARTO: LOS RIESGOS SON REALES

Durante el periparto casi todas las vacas experimentan una disminución profunda de su sistema natural de defensa frente a las infecciones1.
Los niveles y función de los neutrófilos, células inmunitarias que destruyen los patógenos, caen por debajo de la normalidad y esto hace que las vacas sean más vulnerables a la mastitis2, la metritis3 y la retención de la placenta4
Este hecho es un problema no solo por la caída de la producción de leche asociada a las enfermedades, sino porque también puede suponer una pérdida de tiempo y perjudicar la gestión diaria del trabajo en la explotación.
Consulta a tu veterinario las medidas que puedes aplicar para controlar las enfermedades e identificar los factores de riesgo que conducen a la inmunodepresión.
En Elanco tenemos el compromiso de ayudar a los veterinarios y ganaderos a hacer frente a los retos y oportunidades que surgen durante The Vital 90TM Days
Hoeben D. et al, 2000, Journ. Dairy Res. 67 (2) 249-259 - 2. Sordillo L.M., 2005, Livestock Prod. Sci., 98 89–99 3. Hammon D.S. et al, 2006, Vet. Immunology 113 21–29 - 4.
K. et al, 2002, Journ. Dairy. Sci., 85 (3) 544–550 Elanco, The Vital 90TM Days y la barra diagonal son marcas registradas propiedad de o autorizadas por Eli Lilly and Company y sus filiales. © 2015 Elanco Animal Health. ESDRYIRS00052
1.
Kimura
Nuevos









Toros
San Rian NORDÉS Balisto FivET 21/03/15 1HO1301 ESPM1504057975 Índices kg Leche kg Grasa kg Prot. IPP ICU RCS Long. DA GICO ESP-16/02 1684 80 70 1,34 1,84 115 121 90 4032 DE-SU 11236 BALISTO ET USAM0070625988 DE-SU 521 BOOKEM ET USAM0066636657 SAN-RIAN NORA GERARD ET ESPH1503480400 SCHILLVIEW OMAN GERARD ET USAM0052805723 San Rian Sdad. Coop. Galega Xenética Fontao, S.A. Inicio reparto: 1ª tanda 2016 OVE ET BLF CVF 09/11/14 1HO1279 ESPM9204202103 Índices kg Leche kg Grasa kg Prot. IPP ICU RCS Long. DA GICO ESP-16/02 1317 57 52 -0,06 1,69 118 141 108 4045 S-S-I TAPE OVERBAY ET 840M3009554422 PINE-TREE BRIANNE TAPE ET USAM0069169727 WEU MEYRA DEUH0355983920 ECOYNE ISY FRAM5008238457 Importado Xenética Fontao, S.A. Inicio reparto: 1ª tanda 2016 Thos President PERDUT ET 29/12/14 1HO1289 ESPM0804029842 Índices kg Leche kg Grasa kg Prot. IPP ICU RCS Long. DA GICO ESP-16/02 1664 55 50 0,72 1,89 111 122 103 3723 L-L-M-DAIRY PRESIDENT ET USAM0071640112 AMIGHETTI NUMERO UNO ET ITAM7990915143 THOS MOGUL BLAU ESPH0803763407 MOUNTFIELD SSI DCY MOGUL ET 840M3006972816 Importado Xenética Fontao, S.A. Inicio reparto: 1ª tanda 2016 Casagabino Doorman PORTELO 15/10/14 1HO1276 ESPM2704057912 Índices kg Leche kg Grasa kg Prot. IPP ICU RCS Long. DA GICO ESP-16/02 1522 41 48 1,7 2,39 116 123 101 3871 VAL-BISSON DOORMAN ET CANM0107281711 DE-SU 521 BOOKEM ET USAM0066636657 A GRANDELA DELETE 7785 IRINA ESPH2703529853 RIDGEFIELD DELETE ET ESPM9203016128 Casa Gabino Xenética Fontao, S.A. Inicio reparto: 1ª tanda 2016 Cochero Defender RECIMIL ET 29/12/14 1HO1287 ESPM2704057940 Índices kg Leche kg Grasa kg Prot. IPP ICU RCS Long. DA GICO ESP-16/02 1292 35 42 2,3 2,89 105 126 105 3810 S-S-I MOGUL DEFENDER ET 840M3009554569 MOUNTFIELD SSI DCY MOGUL ET 840M3006972816 BOS COCHERO XACOBEO JESSICA ET ESPH2703271029 MARIO XACOBEO ET ESPM9202311402 Casa Cochero Xenética Fontao, S.A. Inicio reparto: 1ª tanda 2016 Gvarela Salnes 2100 SALAZAR ET 14/03/15 1HO1299 ESPM3604057989 Índices kg Leche kg Grasa kg Prot. IPP ICU RCS Long. DA GICO ESP-16/02 1734 35 47 2,24 1,9 120 119 99 3872 HEIDENSKIPSTER SALNES ESPM9203745074 FLEVO GENETICS SNOWMAN NLDM0388965513 GVARELA ZELGADIS ZAIRA ESPH3603794202 CASCINA GIOBBI ZELGADIS ITAM4990278559 Varela de Montrigo Xenética Fontao, S.A. Inicio reparto: 1ª tanda 2016 Gvarela Salnes 2095 SALOMON 27/11/14 1HO1282 ESPM3604057930 Índices kg Leche kg Grasa kg Prot. IPP ICU RCS Long. DA GICO ESP-16/02 1413 14 34 2,85 2,86 108 125 98 3705 HEIDENSKIPSTER SALNES ESPM9203745074 FLEVO GENETICS SNOWMAN NLDM0388965513 GVARELA ZELGADIS SARAH ESPH3603794201 CASCINA GIOBBI ZELGADIS ITAM4990278559 Varela de Montrigo Xenética Fontao, S.A. Inicio reparto: 1ª tanda 2016 SUMMUM 21/06/14 1HO1262 ESPM9204137799 Índices kg Leche kg Grasa kg Prot. IPP ICU RCS Long. DA GICO ESP-16/02 1688 67 61 0,98 2,36 113 122 85 3867 SUNDANCE ET NLDM0882811556 VA-EARLY-DAWN SUDAN CRI ET USAM0062768990 WILLEMS HOEVE JAVINA 612 ET NLDH0948156126 COOKIECUTTER MOM HUNTER ET 840M3000540481 Importado Xenética Fontao, S.A. Inicio reparto: 1ª tanda 2016 Blanco V. 2379 VILLALBA ET 19/11/14 1HO1280 ESPM1504057923 Índices kg Leche kg Grasa kg Prot. IPP ICU RCS Long. DA GICO ESP-16/02 1162 57 51 1,64 2,73 110 119 103 3757 S-S-I MOGUL DEFENDER ET 840M3009554569 MOUNTFIELD SSI DCY MOGUL ET 840M3006972816 BOS GERARD SELENIA ET ESPH1503520752 SCHILLVIEW OMAN GERARD ET USAM0052805723 Blanco de Villalba, S.C. Xenética Fontao, S.A. Inicio reparto: 1ª tanda 2016 62 Frisona Española 212 m/a
en reparto





1, 2, 3... PAC
al domiciliar tu PAC en el Santander con la Cuenta 1l2l3
Al domiciliar tu PAC podrás acceder a:

ANTICIPO PAC1
TARJETA GASÓLEO BONIFICADO GRATIS2
FINANCIACIÓN DE SEGUROS AGRARIOS3


Y con la Cuenta 1l2l3 cumpliendo sus condiciones4 disfrutas de:









3% DE INTERÉS5 NOMINAL ANUAL PARA SALDOS DIARIOS DE MÁS DE 3.000€ Y HASTA 15.000€




















Y además, podrás llevarte esta linterna LED multiusos y la Guía de la PAC6



1. La concesión está sujeta a previa aprobación del banco. 2. El beneficiario de la tarjeta debe ser siempre persona física. Se emite únicamente como tarjeta principal y exclusivamente para adquirir gasóleo en península y Baleares al tipo reducido del Impuesto Especial de Hidrocarburos por almacenistas y detallistas inscritos en el registro especial correspondiente. Concesión de tarjeta sujeta a la aprobación del departamento de riesgos del banco. 3. Seguro mediado por Santander Mediación Operador de Banca-Seguros Vinculado, S.A. CIF A-28360311 a través de su Red de Distribución: Banco Santander, S.A. Operador inscrito en el Registro de la Dirección General de Seguros y Fondos de Pensiones con nº OV-0042. Responsabilidad Civil y Capacidad Financiera cubiertas según legislación vigente. Compañía Aseguradora: CASER, Caja de Seguros Reunidos, Compañía de Seguros y Reaseguros, S.A. 4. Condiciones: domiciliar en la Cuenta 1I2I3: 1) Nómina/prestación por desempleo/ingresos recurrentes (+ de 600€/mes) o pensión (+ 300€/mes) o REA/RETA (+ 175€/mes) o PAC (+ 3.000€); 2) 3 recibos pagados y no devueltos (importe mayor a 0€) de 3 emisores distintos en los 3 últimos meses; 3) 6 movimientos de Tarjetas Santander con cargo en la Cuenta 1I2I3 en los últimos 3 meses. La Cuenta 1I2I3 lleva asociados el contrato multicanal y la tarjeta de débito Oro. Comisión mantenimiento: 3€/mes cumpliendo condiciones. (Si no se cumplen durante 3 periodos de liquidación consecutivos: 8€). Más información en tu oficina y en www.bancosantander.es 5. TAE 2,67% calculada para el supuesto de un saldo diario de 10.000€ que se mantiene constante durante un año y con una comisión de mantenimiento de 36€/año (3€/mes). 6. Oferta válida hasta el 30/04/2016 o hasta agotar unidades disponibles (85.000 unidades).

1ª: Vaca A



2ª: Vaca B



3ª: Vaca D



4ª: Vaca C



Resultados Sección 73: Vacas adultas de 6 años o más
Observaciones previas:

Fantástica sección de vacas adultas con grandes estructuras lecheras y muy buenas ubres para vacas con ya, más de 4 partos.
Colocación Oficial: A - B - D - C

Explicación oficial:
Introducción:
Gana fácilmente la categoría una vaca con la mejor ubre, gran angulosidad y limpieza en general.
1ª sobre 2ª: Por unas mejores inserciones de ubre, tanto anterior como posterior, así como por tener un poco más de estilo y angulosidad en todo su tercio delantero.
2ª sobre 3ª: Dos vacas muy parecidas en valor absoluto pero hoy damos ventaja a la vaca más blanca por ese mejor arqueamiento y angulosidad del costillar anterior asií como por tener un poco más de anchura en su ubre posterior, valorando la correctísima ubre de nuestra vaca negra.
3ª sobre 4ª: Principalmente por esas mejores inserciones de ubre, tanto anteriores como posteriores, profundidad de la misma y colocación anterior de pezones sobre la tremenda estructura lechera de nuestra vaca colocada cuarta.
Ganador entre los acertantes con pleno:
Esteban Rios Crespo, estudiante.

Forcas - Laro (Silleda) Pontevedra

Resto de acertantes:
Geraldo Franco, empresario agrícola.
San Miguel de las Azores (Portugal)


Sección 74: Novillas 1er parto de 24 a 30 meses
Vaca A





EXPLICACIÓN DE LA COLOCACIÓN:
Introducción:
1ª sobre 2ª:
2ª sobre 3ª:
3ª sobre 4ª:
Conclusiones:






Es imprescindible razonar el orden elegido, hablando del conjunto de la sección, mencionando dos o tres características de cada posición y haciendo un comentario final (Consultar “Manual de juzgamiento” de Conafe). Solo se admitirá una respuesta por participante
SECCIÓN 74
Orden Vaca 1ª 2ª


Premio: Forro polar de CONAFE
Datos del concursante:
Nombre y apellidos:
Profesión:
Dirección: .......................................................................
Código postal, localidad y provincia:
Teléfono:
4ª
3ª
.......................................................................................................
.................................................................................... .......................................................................................................
............................................................................... .......................................................................................................
..........................................................................
Envíe este cupón a FRISONA ESPAÑOLA Apdo. de Correos 31 - 28340 Valdemoro (Madrid) antes del 4 de junio de 2016
Vaca B
Vaca C
Vaca D
Calificación
Animales calificados EX y MB
A continuación aparece la relación de animales (nombre y propietario) calificados durante los meses de ENERO y FEBRERO de 2016, que han obtenido las categorías de EX o MB.
En la web de Conafe www.conafe.com aparece esta misma relación junto con el número genealógico y el padre de cada ani-
Técnicos Calificadores
Gabriel Blanco del Campo (Jefe del Dpto. de Morfología)
Juan Manuel Fernández Ahedo (Coordinador de Calificadores)

Marcial Avelló Santiago Santiago Mato Montouto
Domingo Ces Ares Julián Montero García
Alejandro Glez. del Valle Mier Pedro Javier Peréz Pérez
Luis Mario López Vázquez Rafael Vierna Pita mal. También en esta web, a través de SinbadFree, se puede ampliar la información sobre genealogías, índices y producciones de estos animales.
MACHOS MB - 88 PUNTOS
BOS REY ARTES EVO ET/MARRONDIN - LUGO
CASTRO BLANCO DUDE ET/CASA CASTRO, S.C. - A CORUÑA
MACHOS MB - 86 PUNTOS
CAMPA BROKET ET/ABRITA, S.C. - LUGO
CAMPA MEGATOOD ET/CASA DO FERREIRO - LUGO
MACHOS MB - 85 PUNTOS
PREVISOR DOORM. MARCELO FIV ET/GANADERIA PREVISOR, S.C. - LUGO
XEPE HVEZDA ROMANO RC/PENA GUISANDE, S.C. - LUGO
HEMBRAS 4 VECES EXCELENTES
PACHO GOLDWYN TELVA/GAN.DIPLOMADA BADIOLA, S.L. - ASTURIAS
HEMBRAS 3 VECES EXCELENTES
BADIOLA TALENT MEGATILA/GAN.DIPLOMADA BADIOLA, S.L. - ASTURIAS
HEMBRAS EXCELENTES
AUGASANTAS LANDOI 353/AUGASANTAS S.A.T. Nº 1357 XUGA - A CORUÑA
BADIOLA ALEXANDER MERCHE/GAN.DIPLOMADA BADIOLA, S.L. - ASTURIAS
BADIOLA ATWOOD EDITH/GAN.DIPLOMADA BADIOLA, S.L. - ASTURIAS
BADIOLA ATWOOD TAREAS
BADIOLA DAMION LARA
BADIOLA DAMION MAGIA
BADIOLA DUPLEX CANDELA
BADIOLA FEVER EDURNE
BADIOLA MORDOC LARA

4 EX

BADIOLA SANCHEZ MEGATEA 4/GAN.DIPLOMADA BADIOLA, S.L. - ASTURIAS
BADIOLA SHOTTLE MEGADONNA ET/GAN.DIPL. BADIOLA, S.L. - ASTURIAS
CARLA 670 ET/FINCA LA ASUNCION - A CORUÑA
CASA-NOVA RIANA WILDMAN 812/GANADERIA CARRO, S.L. - A CORUÑA
CESARES GALEGA MILLION/CESARES HOLSTEIN, S.C. - A CORUÑA
GAULOISE/FINCA LA ASUNCION - A CORUÑA
GRANDIO LHEROS SABINA/CASA GRANDIO - LUGO
GRC 737 SEAVER/LANDEIRA SDAD.COOP.GALEGA - A CORUÑA
LOUREIROS NOA SHOTTLE/RIAL DE LOUREIROS - A CORUÑA
MARTINA DUPLEX DOLY/MARTINA - LUGO
MATIAS ALEXANDER 2008/CASA MATIAS - LUGO
OSLOUREIROS BELLA 463 BEHOBIA/GAN. OS LOUREIROS, S.C. - A CORUÑA
PENA LAUTHORITY AIRRAID/GANADERIA PENA - LUGO
POZOSAA BIDUIDO 1288 LISI/CASA POZO,S.C. - LUGO
SAN-RIAN DANNA LAUTHORITY ET/SAN RIAN S.COOP.GALEGA - A CORUÑA
TRESPANDIO DUPLEX SIMOLA/S.A.T. A DORNA - LUGO
HEMBRAS MB DE 1º PARTO - 89 PUNTOS
BADIOLA BRADNICK SISY/GAN.DIPLOMADA BADIOLA, S.L. - ASTURIAS
HEMBRAS MB DE 1º PARTO - 88 PUNTOS
BADIOLA ATWOOD INMA/GAN.DIPLOMADA BADIOLA, S.L. - ASTURIAS
BADIOLA ATWOOD KEDHIRA/GAN.DIPLOMADA BADIOLA, S.L. - ASTURIAS
BADIOLA BRAXTON MARISU/GAN.DIPLOMADA BADIOLA, S.L. - ASTURIAS
BADIOLA EPIC MIRANDA ET
BADIOLA LAUTHORITY CARLOTA
BADIOLA LAUTHORITY MORUCHA
BADIOLA YORICK MEGAMILA
CAMPA MASCALESE VALIOSA
OUTEIRO JORDAN BOLONIA

3 EX

66
Española 212 m/a
Frisona
Pacho Goldwyn Telva, (Ganadería Badiola y Casa Pacho, Asturias)
Badiola Talent Megatila, (Ganadería Badiola, Asturias)


HEMBRAS MB DE 1º PARTO - 87 PUNTOS
ANDURIÑA SHAKITROP ATWOOD/ANDURIÑA - A CORUÑA
BADIOLA AIRLIFT ELKA/GAN.DIPLOMADA BADIOLA, S.L. - ASTURIAS
BADIOLA AIRLIFT KENDA/GAN.DIPLOMADA BADIOLA, S.L. - ASTURIAS
BADIOLA ATWOOD KRISTEN/GAN.DIPLOMADA BADIOLA, S.L. - ASTURIAS
BADIOLA ATWOOD MELY/GAN.DIPLOMADA BADIOLA, S.L. - ASTURIAS
BADIOLA BRADNICK MEGAMAPY/GAN.DIPLO. BADIOLA, S.L. - ASTURIAS
BADIOLA GOLD CHIP KEKA/GAN.DIPLOMADA BADIOLA, S.L. - ASTURIAS
BADIOLA GOLD CHIP SILVERIA/GAN.DIPLOMADA BADIOLA, S.L. - ASTURIAS
BADIOLA GOLDSUN MOKA/GAN.DIPLOMADA BADIOLA, S.L. - ASTURIAS
BADIOLA GOLDSUN REME/GAN.DIPLOMADA BADIOLA, S.L. - ASTURIAS
BADIOLA WINDBROOK MEGACIPRI/GAN.DIPLO. BADIOLA, S.L. - ASTURIAS
BADIOLA YORICK MARCIA/GAN.DIPLOMADA BADIOLA, S.L. - ASTURIAS
BOURIO ANDREA DEMPSEY 35305/J.ANTONIO DE BOURIO,S.C. - ASTURIAS
BREA WINDBROOK 9687 MACA/BREA, S.C. - LUGO
CAMPA GOLD CHIP MEGATEA 4 ET/S.A.T. A CAMPA - A CORUÑA
CESARES SARELA DELETE/CESARES HOLSTEIN, S.C. - A CORUÑA
G.DUBRA.S.C. 383 ET/GANADERIA DUBRA, S.C. - A CORUÑA
OPICO ARTES ASIA/GANDERIA O PICO, S.C. - PONTEVEDRA
RISPEL/FINCA LA ASUNCION - A CORUÑA
ROXO MERIDIAN PETREL/CASA ROXO - ASTURIAS
VILA SHOTTLE ASIA 8916/GRANXA VILA - LUGO
HEMBRAS MB DE 1º PARTO - 86 PUNTOS
ANDURIÑA XANA ATWOOD/ANDURIÑA - A CORUÑA
ASUNCION ATWOOD ANJA/FINCA LA ASUNCION - A CORUÑA
ASUNCION BRADNICK LISA/FINCA LA ASUNCION - A CORUÑA
ASUNCION JORDAN CLARA/FINCA LA ASUNCION - A CORUÑA
ASUNCION SHADOW RUPERTA/FINCA LA ASUNCION - A CORUÑA
BADIOLA AIRLIFT BETTY/GAN.DIPLOMADA BADIOLA, S.L. - ASTURIAS
BADIOLA ATWOOD KAWA/GAN.DIPLOMADA BADIOLA, S.L. - ASTURIAS
BADIOLA BRADNICK CHILENA/GAN.DIPLOMADA BADIOLA, S.L. - ASTURIAS
BADIOLA EPIC MALALA ET/GAN.DIPLOMADA BADIOLA, S.L. - ASTURIAS
BADIOLA FEVER LUPE/GAN.DIPLOMADA BADIOLA, S.L. - ASTURIAS
BADIOLA GOLD CHIP MEDUSA/GAN.DIPLOMADA BADIOLA, S.L. - ASTURIAS
BADIOLA GOLDSUN PANCHINA/GAN.DIPLOMADA BADIOLA, S.L. - ASTURIAS
BADIOLA SHAMROCK PATRICIA/GAN.DIPLOMADA BADIOLA, S.L. - ASTURIAS
BADIOLA STANLEYCUP MARCELA/GAN.DIPLO. BADIOLA, S.L. - ASTURIAS
BADIOLA WINDBROOK CITA/GAN.DIPLOMADA BADIOLA, S.L. - ASTURIAS
BADIOLA WINDBROOK DALIA/GAN.DIPLOMADA BADIOLA, S.L. - ASTURIAS
BADIOLA WINDBROOK MELIBEA/GAN.DIPLOMADA BADIOLA, S.L. - ASTURIAS
BADIOLA WINDHAMMER MAIKA/GAN.DIPLOM. BADIOLA, S.L. - ASTURIAS
BADIOLA YORICK MILEMA/GAN.DIPLOMADA BADIOLA, S.L. - ASTURIAS
BERLAI BRAWLER 912/S.A.T. BERLAI - LUGO
CAMPA ATWOOD 9564/S.A.T. A CAMPA - A CORUÑA
CAMPA LET IT SNOW NAOMI ET/S.A.T. A CAMPA - A CORUÑA
CAMPA MCC LEONA FIV ET/S.A.T. A CAMPA - A CORUÑA
CANDENDO 324 ET/GANADERIA CANDENDO, S.C. - A CORUÑA
CANEDA NOSA MERIDIAN/S.A.T. CANDESA - A CORUÑA
CASA-NOVA DELIA FEVER 943/GANADERIA CARRO, S.L. - A CORUÑA
CASEIRODERNES MERIDIAN HOPE/CASEIRO DE ERNES S.A.T. - LUGO
CHOUPANEIRO 740 LAUTAMIC/SANTA LUCIA, S.C. - A CORUÑA
CONCHADOS BRADNICK SONIA/CONCHADOS, S.C. - LUGO
DEMETRIO 7795 SID/SAN MARTIÑO, S.A.T. - LUGO
DOROÑA WINDBROOK HEIDI 2331/S.A.T. DOROÑA 1094 XUGA - A CORUÑA
FONCUBERTA LADNER PELIGRO 7461/C.COM.DE FONCUBERTA - OURENSE
ITALIA 4371/CARLOS GARCIA FDEZ - ASTURIAS
LOUREIROS SONIA DELETE/RIAL DE LOUREIROS - A CORUÑA
MATIAS LAUTAMIC 5302/S.A.T. REVOLTA - LUGO
NAVE ALEXANDER KEN 5021/LA NAVE, S.C. - LUGO
O COTO LUCERA TOYSTORY/O COTO - A CORUÑA
PENA BRAXTON DAMION/GANADERIA PENA - LUGO
SAA LAVANGUARD 6929/CASA DA SAA, S.C. - LUGO

m/a 212 Frisona Española 67
EX
Badiola Shottle Megadonna, (Ganadería Badiola, Asturias)
SAN-RIAN DANISH NUMERO UNO ET/SAN RIAN S.C.GALEGA - A CORUÑA
SAN-RIAN SHOWGAL ZELGADIS/SAN RIAN S.C.GALEGA - A CORUÑA
SAT FERNANDO 1013 ALICIA BETAN/CASA FERNANDO SAT.1122 XUGA-A CORUÑA
SOBRADO CELA LAUTAMIC 9610/GAN. SOBRADO CELA,S.C. - LUGO
SOLA DELETE 3988/JAVIER MARCOS MARCOS - ASTURIAS
TASIL SPIRTE FLORIDA/SILVA - PONTEVEDRA
TEIXEIRO FEVER FADA/CASA GABINO - LUGO
VEIGAR R. XACOBEO MORADA/CASA DA VEIGA - PONTEVEDRA
VILA 942 DELETE/S.A.T. GANADERIA VILA DE SANTAIA - A CORUÑA
XACINTO DELETE DEMY/XACINTO, S.C. - LUGO
XERCAS CAV LEDI SUPERSIRE ET/CAVADAS S.A.T. XUGA 941 - LUGO
XERCASPORTA XACOBEO XIRIA/PORTALOUSA - LUGO
HEMBRAS MB DE 1º PARTO - 85 PUNTOS
023 ALBAÑIL DEMPSEY 2990/CASA DO ALBAÑIL - LUGO
154 PALOMA JORDAN/AVELINO CASTRO - A CORUÑA
2592 PINTA XACOBEO/TUBIO BUSTO, S.C. - A CORUÑA
4976 FARRAPA MERIDIAN/S.A.T. A FARRAPA - A CORUÑA
5005 FARRAPA ATWOOD/S.A.T. A FARRAPA - A CORUÑA
5028 FARRAPA SUPER/S.A.T. A FARRAPA - A CORUÑA
5063 FARRAPA MERIDIAN ET/S.A.T. A FARRAPA - A CORUÑA
5068 FARRAPA N UNO/S.A.T. A FARRAPA - A CORUÑA
626/S.A.T. LAVANDEIRA 950 XUGA - A CORUÑA
649/S.A.T. LAVANDEIRA 950 XUGA - A CORUÑA
6983 FARRAPA MERIDIAN/S.A.T. A FARRAPA - A CORUÑA
6990 FARRAPA JETT AIR/S.A.T. A FARRAPA - A CORUÑA
717 CALZADA MERLOCHA DELETE/S.A.T. ISIDRO - A CORUÑA
9403/CASA SANCHEZ - A CORUÑA
A ESTIVADA BRADNICK ARCEA/A ESTIVADA S.C.GALEGA - A CORUÑA
A ESTIVADA SANCHEZ ANTALAHA/A ESTIVADA S.C.GALEGA - A CORUÑA
AGROSALGADO 458 MAGREBI/AGRO SALGADO, S.C. - A CORUÑA
ALGRABUSAN ARTES 534-1987/S.A.T. ALGRABUSAN - LUGO
ALMUIÑA DELETE 5007 TOURA/ALMUIÑA, S.C. - LUGO
ANDURIÑA TELA ATWOOD/ANDURIÑA - A CORUÑA
ANILA DELETE JACINTA/CASA DO REI,S.C. - PONTEVEDRA
ANTELANA JERRICK SEPTEM. 14283/C.ANTELANA,S.C.GALEGA - OURENSE
ANTELANA LAUTAMIC IGNITER/C.ANTELANA,S.C.GALEGA - OURENSE
ANTELANA LAVANGUARD MAGOT/C.ANTELANA,S.C.GALEGA - OURENSE
ARMUCELA ALTAIOTA GRAND/GANDEIRIA ARMUCELA, S.C. - A CORUÑA
ARTISTA DE AOUBEL ARTES/GANADERIA OUBEL, S.L. - A CORUÑA
AS PANDAS DELETE 509/S.A.T. AS PANDAS - LUGO
AS REGAS ROSS 3340/S.A.T. AS REGAS N.924 XUGA - A CORUÑA
ASUNCION BRADNICK SHEILA/FINCA LA ASUNCION - A CORUÑA
AUGASANTAS TRUENO ROJO 644/AUGASANTAS SAT. Nº 1357 XUGA-A CORUÑA
BACORELLE XACOBEO BARAKA/BACORELLE, S.C. - LUGO
BADIOLA ATWOOD KAROLA/GAN.DIPLOMADA BADIOLA, S.L. - ASTURIAS
BADIOLA BIG TIME LILY/GAN.DIPLOMADA BADIOLA, S.L. - ASTURIAS
BADIOLA BIG TIME PALOMA/GAN.DIPLOMADA BADIOLA, S.L. - ASTURIAS
BADIOLA BRAXTON KARUBU/GAN.DIPLOMADA BADIOLA, S.L. - ASTURIAS
BADIOLA DEMPSEY MEGACHELY/GAN.DIPLOMADA BADIOLA, S.L. - ASTURIAS
BADIOLA MEGAGENIO SIMONA/GAN.DIPLOMADA BADIOLA, S.L. - ASTURIAS
BADIOLA MORGAN BAMBINA/GAN.DIPLOMADA BADIOLA, S.L. - ASTURIAS
BADIOLA WINDBROOK ELY/GAN.DIPLOMADA BADIOLA, S.L. - ASTURIAS
BADIOLA WINDBROOK MEGANELA/GAN.DIPL. BADIOLA, S.L. - ASTURIAS
BARONCELLE MEGAMAGIC SELAYA/RATO, S.C. - PONTEVEDRA
BARREIRO 9939 DELETE/BARREIRO LODEIROS, S.C. - A CORUÑA
BARRIOSC LAUTAMIC 37/BARRIO, S.C. - LUGO
BAXO BRADNICK TAPIA/GANADERIA BAXO, S.C. - ASTURIAS
BELLO 234 GOSPELL/BELLO - A CORUÑA
BERLAI SUPER 918/S.A.T. BERLAI - LUGO
BERTALO WINDBROOK LANDA/GRANJA SARA - LUGO
BOS POZOSAA SANCHEZ LUSA ET/CASA POZO,S.C. - LUGO
BOTANA BETY DELETE/BOTANA - A CORUÑA
BOURIO LENCA IOTA/JOSE ANTONIO DE BOURIO,S.C. - ASTURIAS
BOURIO RUFA ARTHUR/JOSE ANTONIO DE BOURIO,S.C. - ASTURIAS
BRAIS XACOBEO 4230 PACHECA/CASA DO BRAIS, S.C. - LUGO
BREA ARTES 1280 POMBA/BREA, S.C. - LUGO
BREA ARTES 1282 SENA/BREA, S.C. - LUGO
BREA FEVER 1300 PIRULETA/BREA, S.C. - LUGO
BREA FEVER 9606 PATOCHA/BREA, S.C. - LUGO
BUSTO-CORZON 797 LAUTHORITY ET/S.A.T. BUSTO-CORZON - A CORUÑA
CABANAS CHENOA AFTERSHOCK/CABANAS - A CORUÑA
CABANAS PLANETA PLANET/CABANAS - A CORUÑA
CABANAS TARA WINDBROOK ET/CABANAS - A CORUÑA
CABO LITO 7530/CASA CABO - LUGO
CAMPA CH GOLDCHIP MEGATEA 2 ET/S.A.T. A CAMPA - A CORUÑA
CAMPA MARS YORICK MEGADEA I ET/S.A.T. A CAMPA - A CORUÑA
CAMPO GERARD NOVILLA/CASA DO CAMPO - PONTEVEDRA
CANDENDO LANA 318/GANADERIA CANDENDO, S.C. - A CORUÑA
CANDENDO SPECTRUM MISS ET/GANADERIA CANDENDO, S.C. - A CORUÑA
CAPJ IVANE/CASA DE BOGA - A CORUÑA
CARAMUÑA LAUTAMIC NIEVE/CARAMUÑA - LUGO
CASA DE LOLA ARDILLA DELETE/CASA DE LOLA - A CORUÑA
CASAGABINO WINDBROOK LAURICA/CASA GABINO - LUGO
CASA-NOVA GREGORIA ATHLETE 958/GANAD. CARRO, S.L. - A CORUÑA
CASA-NOVA MONA FEVER 961/GANADERIA CARRO, S.L. - A CORUÑA
CASA-NOVA TOÑITA ATWOOD 951/GANAD. CARRO, S.L. - A CORUÑA
CASEIRODERNES MONREAL NADIA/CASEIRO DE ERNES S.A.T. - LUGO
CASTELO STEADY 7223/GANADERIA O CASTELO, S.C. - LUGO
CEBRA/S.A.T. BERNALDO - A CORUÑA
CESARES TURIA XACOBEO/CESARES HOLSTEIN, S.C. - A CORUÑA
CONCHADOS BRAXTON XARDA/CONCHADOS, S.C. - LUGO
CONCHADOS DANCER RUADA/CONCHADOS, S.C. - LUGO
COREN ELSAR O 6687/ODILO BORRAJO E HIJOS, S.C. - OURENSE
COREN LAMBO ROJO O 4509/ODILO BORRAJO E HIJOS, S.C. - OURENSE
COUQUIÑO-S.C. 604 ARTES/COUQUIÑO, S.C. - A CORUÑA
CUNDINS CRISANTEMA BRADNICK ET/CASA EIRAS, S.C. - A CORUÑA
CURRILLOS DELETE 166/SANCHEZ BOO S.C. - A CORUÑA
DINA 52/VIRGEN DEL CAMINO, S.C. - A CORUÑA
DUBRA 2960 BAXTER/CASA DUBRA, S.C. - A CORUÑA
EDRADA DELANO NATI/S.A.T. EDRADA 1113 XUGA - LUGO
EDRADA PLAYMATE TANIA/S.A.T. EDRADA 1113 XUGA - LUGO
EIRAS ARIANA ATWOOD/CASA EIRAS, S.C. - A CORUÑA
EL PUMAR LORENA SUPER/EL PUMAR - A CORUÑA
FIGUEIRA DELETE 3041 SANDY/S.C. FIGUEIRA - LUGO
FINCAVIQUEIRA LUPE LOPEZ/SAT REGUEIRO BRANCO 1390 XUGA-A CORUÑA
FM 0601 DELANO 7924/S.A.T. FAMILIA MARTINEZ - A CORUÑA
FM 3226 Nº1 7920/S.A.T. FAMILIA MARTINEZ - A CORUÑA
FONDAL MISTICA GERARDO/S.A.T. 913 XUGA O FONDAL ABOI - A CORUÑA
FOUZ END-STORY 2842/GANADERIA LAGO - LUGO
FRUXINDE DAKOTA 5133/FRUXINDE, S.C. - LUGO
FRUXINDE ELEGANT 5145/FRUXINDE, S.C. - LUGO
FULLEIRO JAY 1909/GANADERIA FULLEIRO - A CORUÑA
G.DUBRA.S.C. 384/GANADERIA DUBRA, S.C. - A CORUÑA
G.PEREIRA TEJERO FLECHA/GANADERIA PEREIRA,S.C. - PONTEVEDRA
G.SAR ESTAI STANLEYCUP 7330/GANDERIA SAR, S.L. - A CORUÑA
G.SAR SELLA DEMPSEY 9343/GANDERIA SAR, S.L. - A CORUÑA
GEAN PIRAÑA SIRIUS/LEITEIRA GEAN, S.C. - A CORUÑA
HOULEN 84 416/GANDERIA AS RIAS, S.A.T. - A CORUÑA
IGREXA ALTATOYOTA YARIS 551/GANADERIA CELTIGOS, S.L. - A CORUÑA
IVANKA 62/GANADERIA CARRO, S.L. - A CORUÑA
IYAKA/GANADERIA LA PUMAREGA, S.C. - ASTURIAS
JOSMAR MONREAL NOVA 3504/JOSMAR GANADERIA, S.C. - LUGO
LARA KATANA/EL ARROYO - VIZCAYA
LISTE 1082 AVALON/GANDERIA LISTE, S.C. - A CORUÑA
LOUREIROS EVA BUCKEYE/RIAL DE LOUREIROS - A CORUÑA
LOUREIROS IRINA DUPLEX/RIAL DE LOUREIROS - A CORUÑA
LSCG 862 KRUSADER/LANDEIRA SDAD.COOP.GALEGA - A CORUÑA
LSCG 897 GOSPELL/LANDEIRA SDAD.COOP.GALEGA - A CORUÑA
LSCG 942 GOSPELL/LANDEIRA SDAD.COOP.GALEGA - A CORUÑA
LUCHANA WYMAN 2305/CASA LUCHANA - LUGO
MACARIA DE OUBEL BRAXTON/GANADERIA OUBEL, S.L. - A CORUÑA
MADARRO GASTTOF 7141/MADARRO - LUGO
MANEIRO 2841 ATLAS/MANEIRO - A CORUÑA
MANEIRO 2873 BRAWLER/MANEIRO - A CORUÑA
MARTINA ARTES TERESA/MARTINA - LUGO
MIKA ARTES CHINA/GANADERIA FORCAO - LUGO
NAVE ARTES DANIELA 9318/LA NAVE, S.C. - LUGO
NAVE CADI LETI 9320/LA NAVE, S.C. - LUGO
NAVE DEMPSEY ALEXIA 5448/LA NAVE, S.C. - LUGO
NAVE DEMPSEY CARMIÑA 9338/LA NAVE, S.C. - LUGO
NAVE SID KAT 9305/LA NAVE, S.C. - LUGO
NAVE SID MARGA 9322/LA NAVE, S.C. - LUGO
NODI JAIME ATLAS 517 NOA ET/S.A.T. EMILIO DO JAIME - LUGO
NOVELLE ALERTA LOREAL/GANADERIA NOVELLE, S.C. - LUGO
NOVELLE ATLAS LINUX/GANADERIA NOVELLE, S.C. - LUGO
NUVEIRA MARTA STOP/NUVEIRA - A CORUÑA
O CASAL LUA 6757 PLANET/O CASAL VILAR S.A.T. 921 XUGA - A CORUÑA
O COTO DISELA ARDENT/O COTO - A CORUÑA
O SEIXO BONITA GIPSIO/GANDEIRIA O SEIXO - A CORUÑA
OCHAMOR ARTES SUSANA/GANADERIA O CHAMOR - PONTEVEDRA
OSCASEIROS OMAR CHABELI/OS CASEIROS - PONTEVEDRA
OUTEIRO TORREL FURIA/SC GANADERIA OUTEIRO - LUGO
PAINZA XACOBEO 3157 SABRINA/CASA PAINZA - LUGO
PANTALEON HEIDY TRIANGLE/PANTALEON - A CORUÑA
PEDREIRA 7073/S.A.T. CASA PEDREIRA - A CORUÑA
PEDROLAS ARTES 9323/S.A.T. PEDROLAS - LUGO
PEDROLAS BETANZOS 9324/S.A.T. PEDROLAS - LUGO
PENA 198 POTUL/S.A.T. AS REGAS N.924 XUGA - A CORUÑA
PENA ATWOOD DAMION/GANADERIA PENA - LUGO
PENA ATWOOD DAMION/GANADERIA PENA - LUGO
PENA LAUTHORITY SPIRTE/GANADERIA PENA - LUGO
PENA SANCHEZ DUPLEX/GANADERIA PENA - LUGO
PENA WINDBROOK DAMION 2/GANADERIA PENA - LUGO
PENAGUISANDE LAUTAMIC 5325/PENA GUISANDE, S.C. - LUGO
PEREZ FEVER 102/PEREZ, S.C. - LUGO
PEREZ WINDBROOK 100/PEREZ, S.C. - LUGO
PEREZ WINDBROOK 77/PEREZ, S.C. - LUGO
POZOSAA ATWOOD 7128 TAMARA/CASA POZO,S.C. - LUGO
PUMA/GRANXA RIVEIRO, S.C. - A CORUÑA
PUMARIÑO LEIRE/S.A.T. PUMARIÑO - A CORUÑA
QUINTIAN ARTES ARIAZNA/QUINTIAN, S.C. - LUGO
REY DELETE OCA/PIÑEIRO REY, S.C. - LUGO
RIALO 5066 LAVANGUARD/GANADERIA RIALO - A CORUÑA
RIVAS LANDOI LULA/RIVAS ARES, S.C. - LUGO
ROXELO DELETE BOHEMIA/GANADERIA ROXELO,S.C. - PONTEVEDRA
ROXELO XACOBEO KITTI/GANADERIA ROXELO,S.C. - PONTEVEDRA
ROXO DELANO LUNA/CASA ROXO - ASTURIAS
ROXO EMMETT TEKILA/CASA ROXO - ASTURIAS
ROXO MOGUL DUQUESA/CASA ROXO - ASTURIAS
ROXO MOGUL ELECTRA/CASA ROXO - ASTURIAS 68
Frisona Española 212 m/a (pasa pág. 70)

ROXY ARTES TANIA/GANADERIA FORCAO - LUGO
S.C.REGUEIRO 336 AMSTERDAM/DAMIAN REGUEIRO, S.C. - A CORUÑA
SAN MARTIN 3708 DELETE/S.A.T.SAN MARTIN DE ARMENDAL - A CORUÑA
SAN VICENTE LAUTH. SILVIA 1223/CASTRO NOYA,S.C. - A CORUÑA
SANCHEZ NOEMI JORDAN/GANADERIA SANCHEZ - A CORUÑA
SAN-RIAN DONATELLA MAYFIELD/SAN RIAN S.C.GALEGA - A CORUÑA
SAN-RIAN SEVILLA DELETE/SAN RIAN SDAD.COOP.GALEGA - A CORUÑA
SANTA MARIA DELETE 470-2800/STA.MARIA DE LOXO S.A.T. 1153 - A CORUÑA
SANTANA TRAILER 268/EL ARROYO - VIZCAYA
SC TOXEIRO TORREL PARRA/TOXEIRO, S.C. - LUGO
SEOANE JERRICK CIGOÑA 311/GANDEIRIA SEOANE,S C. - A CORUÑA
SIDRO DUNHILL DIA/ISIDRO, S.C. - ASTURIAS
SOBRADO CELA LAUTAMIC 9618/GANADERIA SOBRADO CELA,S.C. - LUGO
SOLA WONDER 6099/JAVIER MARCOS MARCOS - ASTURIAS
TARREO BETANZOS 615-4571/FINCA TARREO,S.A. - A CORUÑA
TASIL DEMPSEY FANTASIA/SILVA - PONTEVEDRA
TENDEIRO ARTES 7138/TENDEIRO,S.C. - LUGO
VARELA DANCER 2864/VARELA - LUGO
VIDAL SARA WINDBROOK/VIDAL DE MEREDO - ASTURIAS
VIEITES CORA FEVER/VIEITES - A CORUÑA
VILA 885 ATWOOD/S.A.T. GANADERIA VILA DE SANTAIA - A CORUÑA
VILA 895 DELETE/S.A.T. GANADERIA VILA DE SANTAIA - A CORUÑA
VILA WINDBROOK MARTA 8930/GRANXA VILA - LUGO
VILARIÑO DOM HERMIDA 803/GRA. VILARIÑO, S A T. 985 XUGA - A CORUÑA
VILARIÑO DOM XUNCA 818/GRA VILARIÑO, S.A.T. 985 XUGA - A CORUÑA
VILARIÑO STANLEYCUP MONA 761/G. VILARIÑO, S.A.T. 985 XUGA - A CORUÑA
VILARIÑO TRIANGLE NUCHA 826/G. VILARIÑO, S.A.T. 985 XUGA - A CORUÑA
XERCAS CAV ARI LATIMER/CAVADAS S.A.T. XUGA 941 - LUGO
XERCAS CAV SALOU LAUTAMIC/CAVADAS S.A.T. XUGA 941 - LUGO
XERCAS CAV VALIOSA DELETE/CAVADAS S.A.T. XUGA 941 - LUGO
XERCAS VALIOSA MERIDIAN/GANADERIA PERNAS, S.C. - LUGO
XERCAS XESTA DELETE/GANADERIA PERNAS, S.C. - LUGO
XERCASPORTA STANLEYCUP SOLA/PORTALOUSA - LUGO
XERCASPORTA STOP LAVA/PORTALOUSA - LUGO
XUANA FEVER FIONA 6487/GANADERIA XUANA,S.C. - LUGO
HEMBRAS MB DE 2º O MAS PARTOS - 89 PUNTOS
8904 ROXA FARRAPA TALENT ROJA/S.A.T. A FARRAPA - A CORUÑA
ANTELANA ELEGANT GOLDWYN 13761/C.ANTELANA,S.C.GALEGA - OURENSE
ASUNCION JORDAN RANIA/FINCA LA ASUNCION - A CORUÑA
BINISSUES PISCULICHI COL/BINISUES - BALEARES
CANEDA SIRIA BOWSER/S.A.T. A CAMPA - A CORUÑA
CESARES AREAL MINISTER/CESARES HOLSTEIN, S.C. - A CORUÑA
CHOUPANEIRO 618 XACOBEO/SANTA LUCIA, S.C. - A CORUÑA
GRC 647 XACOBEO/LANDEIRA SDAD.COOP.GALEGA - A CORUÑA
MARY/FINCA LA ASUNCION - A CORUÑA
NAVE LHEROS ELY 1105/LA NAVE, S.C. - LUGO
VAZQUEZ SHOTTLE TILA 2408/VAZQUEZ - LUGO
HEMBRAS MB DE 2º O MAS PARTOS - 88 PUNTOS
ASUNCION JORDAN KANSA 4/FINCA LA ASUNCION - A CORUÑA
BADIOLA ATWOOD MEGACHELY/GAN.DIPLOMADA BADIOLA, S.L. - ASTURIAS
BADIOLA ATWOOD MEGANDROID/GAN.DIPLOM. BADIOLA, S.L. - ASTURIAS
BOS ANDURIÑA JENY SANCHEZ ET/ANDURIÑA - A CORUÑA
CASEIRODERNES SID DORA/CASEIRO DE ERNES S.A.T. - LUGO
CESARES BARBOSA XACOBEO/CESARES HOLSTEIN, S.C. - A CORUÑA
CESARES SELMA SHOTTLE/CESARES HOLSTEIN, S.C. - A CORUÑA
CESARES VIÑAO MINISTER/CESARES HOLSTEIN, S.C. - A CORUÑA
DOCAMPO MAGREBI MAGRA/DO CAMPO - LUGO
GRACOZA TUNNO GASPAR/LAR DE GRACOZA, S.C. - LUGO
GRC 653 SHOTTLE/LANDEIRA SDAD.COOP.GALEGA - A CORUÑA
HONFLEUR 1400 DANA/GANADERIA ROXELO,S.C. - PONTEVEDRA
LINDI/FINCA LA ASUNCION - A CORUÑA
MARGARITA/CASA EL NENO - ASTURIAS
PALLON BRANDY 5180/GANDEIRIA PALLON, S.C. - PONTEVEDRA
PAMELA/GANADERIA CIMA, S.C. - ASTURIAS
PANTALEON CLAUDINA GARDIMAN/PANTALEON - A CORUÑA
POUSADA AMOR 7986/RATO, S.C. - PONTEVEDRA
SABINE/FINCA LA ASUNCION - A CORUÑA
SALGUEIROS INFA SHOTTLE/SALGUEIROS - A CORUÑA
SANDA 17 BOLIVIA/SANDA - A CORUÑA
TORIBIA/SANTA CRISTINA, S.C. - A CORUÑA
VILARIÑO BAXTER ANGOLINA 563/G. VILARIÑO, SAT. 985 XUGA - A CORUÑA
VILARIÑO TALENT COLADA 570/G. VILARIÑO, S.A.T. 985 XUGA - A CORUÑA
XERCAS CAV AREA GOLDWYN/CAVADAS S.A.T. XUGA 941 - LUGO
ZOQUEIRO ELEGANT CEREIXA/CASA DE ZOQUEIRO - LUGO
670 CALZADA PATRICIA PLANETE/S.A.T. ISIDRO - A CORUÑA
HEMBRAS MB DE 2º O MAS PARTOS - 87 PUNTOS
A ESTIVADA ATWOOD ARAXIA/A ESTIVADA S.COOP.GALEGA - A CORUÑA
AGRODAFONTE 461 TALENT/AGRO DAFONTE, S.C. - A CORUÑA
AGRUÑEIRAS XACOBEO 5481/FINCA AGRUÑEIROS - LUGO
ANTELANA KINGLY FINAL CUT/COOP.ANTELANA,S.C.GALEGA - OURENSE
ANXEL DO CURA TEXAS 1623 ROJA/CASA ANXEL DO CURA - LUGO
ARGOLLA 0555 EMIR/CASA PAINZA - LUGO
BADIOLA DEMPSEY LORNA/GAN.DIPLOMADA BADIOLA, S.L. - ASTURIAS
BADIOLA SID RUSA/GAN.DIPLOMADA BADIOLA, S.L. - ASTURIAS
BADIOLA STANLEYCUP MASCARA/GAN.DIPLOM BADIOLA, S.L. - ASTURIAS
BENITO MAGREBI 3835/GANADERIA BENITO - LUGO
CABANAS NEREA SANCHEZ/CABANAS - A CORUÑA
CANDENDO 233/GANADERIA CANDENDO, S.C. - A CORUÑA
CARBOEIRO PAROCAS 7183/S.A.T. O CARBOEIRO - LUGO
CASA-NOVA ELEGANTE II ATWOO ET/GANADERIA CARRO, S.L. - A CORUÑA
CASANOVA JORDAN 2652/CASANOVA - LUGO
CASANOVA XACOBEO XACOBA/CASA NOVA, S.C. - LUGO
CASAVELLA ANDREA ACME/CASAVELLA - ASTURIAS
CASTRO TRIANA MADAGASCAR/CASA CASTRO, S.C. - A CORUÑA
CERRACIN 388 COTORRA BOLIVIA/CERRACIN - LUGO
CIUCENDE XACOBEO 9874/AGROCIOCENDE, S.C. - A CORUÑA
CONCHADOS LAUTHORITY RUA/CONCHADOS, S.C. - LUGO
COVA NEGRA/GANADERIA COVA - A CORUÑA
EL.HAYA STANLEYCU LENA/EL HAYA MATIENZO, C.B. - VIZCAYA
FERREIRIÑO SID PINTOSA/CASA FERREIRIÑO - PONTEVEDRA
FRUXINDE BOLIVIA 2552/FRUXINDE, S.C. - LUGO
G.DUBRA.S.C. 235/GANADERIA DUBRA, S.C. - A CORUÑA
G.DUBRA.S.C. 273/GANADERIA DUBRA, S.C. - A CORUÑA
G.DUBRA.S.C. 329 ET/GANADERIA DUBRA, S.C. - A CORUÑA
GARIGUETTE/SAT REGUEIRO BRANCO 1390 XUGA - A CORUÑA
GOMELLE BRIZEN 9725 DINA/S.A.T. GOMELLE 494 - LUGO
GRACOZA SID VIRXINIA 723/CHAO IGLESIA S.A.T. 1207 XUGA - LUGO
GRANDIO DUPLEX ESMERALDA/CASA GRANDIO - LUGO
GRANDIO XACOBEO BETSY/CASA GRANDIO - LUGO
HELICIA/FINCA LA ASUNCION - A CORUÑA
ILMA 059 XACOBEO/S.A.T. 828 ILMA-XUGA - A CORUÑA
JOFRAN 5826 CINZANO ROJA/ASTANDE - A CORUÑA
LISTE 849 XACOBEO/GANDERIA LISTE, S.C. - A CORUÑA
LOUREIROS UXIA XACOBEO/RIAL DE LOUREIROS - A CORUÑA
LSCG 747 JORDAN/LANDEIRA SDAD.COOP.GALEGA - A CORUÑA
MARIELA 293 TRIBUTE/FINCA LATA - A CORUÑA
MENOR BRONCO CHATA/S.A.T. CASA MENOR 1017 XUGA - A CORUÑA
NOVELLE LAURIN INDRA/GANADERIA NOVELLE, S.C. - LUGO
NUVEIRA GALLEGA BUCKEYE/NUVEIRA - A CORUÑA
NUVEIRA LOLA DANCER/NUVEIRA - A CORUÑA
O-BATALLA TARTA BLITZ/GANADERIA BATALLA, S.C. - A CORUÑA
OPORTO ELEGANT CLAUDIA/PORTO - PONTEVEDRA
OSLOUREIROS MONICA 558 ALTAIOT/G. OS LOUREIROS, S.C. - A CORUÑA
PACA XACOBEO RITA 806/PACA, S.C. - LUGO
PANTOJA/GRANXA RIVEIRO, S.C. - A CORUÑA
POZOSAA TALENT 9622 TITA/CASA POZO,S.C. - LUGO
QUINTIAN AMSTERDAM AMERICANA/QUINTIAN, S.C. - LUGO
R.C..C. MELANI WILDMAN/EL ARROYO - VIZCAYA
RAMIL TOYSTORY LUCERA/RAMIL DE FRIOLFE,S.C. - LUGO
SAN XULIAN 2792 JORDAN/S.A.T. SAN JULIAN - A CORUÑA
SANDA 27 DUPLEX/SANDA - A CORUÑA
SC EMILIANO XACOBEO 8448/CASA EMILIANO,S.C. - LUGO
SILVELA DIVINA TOYSTORY/CASA SILVELA, S.C. - ASTURIAS
TAROLO XACOBEO LUNA 4414 CAROL/SIDORIO - LUGO
TASIL LAUTHORITY DORA/SILVA - PONTEVEDRA
TASIL WINDBROOK ESPERANZA-12/SILVA - PONTEVEDRA
VANHOLLAND GEPKE 64/GANADERIA FULLEIRO - A CORUÑA
VEIGA WINDBROOK 3342/S.C. VEIGA - LUGO
VILA 909 TOYSTORY/S.A.T. GANADERIA VILA DE SANTAIA - A CORUÑA
XERCASPORTA SANCHEZ BUENA/PORTALOUSA - LUGO
0407/CASA SANCHEZ - A CORUÑA
0734 FARRAPA DELETE/S.A.T. A FARRAPA - A CORUÑA
8199 FARRAPA JORDAN/S.A.T. A FARRAPA - A CORUÑA
HEMBRAS MB DE 2º O MAS PARTOS - 86 PUNTOS
A ESTIVADA ATWOOD ANFORA/A ESTIVADA S.COOP.GALEGA - A CORUÑA
A PEDRA XACOBEO 481/A PEDRA S.A.T. Nº 1188 XUGA - A CORUÑA
A.PENIÑA XACOBEO RULA/GANDEIRIA S.A.T. PENIÑA 1043 - PONTEVEDRA
ALGRABUSAN SID 404-5544/S.A.T. ALGRABUSAN - LUGO
ALGRABUSAN XACOBEO 292-1526/S.A.T. ALGRABUSAN - LUGO
ALMA VIDALA DANCER/ALMA - A CORUÑA
ALMOZARA 861 TALENT/GANADERIA CELTIGOS, S.L. - A CORUÑA
ANDURIÑA DENA SID ET/ANDURIÑA - A CORUÑA
ANTELANA MAGREBI DANCER 14183/C.ANTELANA,S.C.GALEGA - OURENSE
AS REGAS MILLION 8362/S.A.T. AS REGAS N.924 XUGA - A CORUÑA
AUGASANTAS LEOPARD 549/AUGASANTAS S.A.T. Nº 1357 XUGA - A CORUÑA
AVELINO 2297 DANCER/CASTRO NOYA,S.C. - A CORUÑA
BALADO ANTONIA XACOBEO/BALADO - A CORUÑA
BARANGUEIRA LAUTAMIC LATA/CASA BARANGUEIRA - LUGO
BASADRE SID 5220/GANADERIA BASADRE - LUGO
BELLO 211 EXPLODE/BELLO - A CORUÑA
BERLAI DANCER 542/S.A.T. BERLAI - LUGO
BERLAI HOWIE 396/S.A.T. BERLAI - LUGO
BERTALO XACOBEO VALERIA/GRANJA SARA - LUGO
BOS EIRAS ESTRELLA WINDBR. ET/CASA EIRAS, S.C. - A CORUÑA
BOURIO CHENOA ALEXANDER/JOSE ANTONIO DE BOURIO,S.C. - ASTURIAS
BOURIO CORONA JORDAN/JOSE ANTONIO DE BOURIO,S.C. - ASTURIAS
CABADO SACHO CHINA/CASA GIL, S.C. - LUGO
CABO DOLMAN MODELO/CASA DO CABO - LUGO
CAMANZO SHOTTLE SHOTA/CAMANZO - PONTEVEDRA
CAMPA GOLD CHIP 1210/S.A.T. A CAMPA - A CORUÑA
CANDENDO 293/GANADERIA CANDENDO, S.C. - A CORUÑA
CANDENDO ATWOOD MARIA/GANADERIA CANDENDO, S.C. - A CORUÑA
CANEDA SANA GABOR/S.A.T. CANDESA - A CORUÑA
CARBOEIRO DELETE 7158/S.A.T. O CARBOEIRO - LUGO
CASA DE LOLA GOLONDRINA XACOBE/CASA DE LOLA - A CORUÑA
CASACURRO PIRATA XACOBEO/CASA CURRO - A CORUÑA
CASEIRODERNES WINDBROOK LAUHAN/CASEIRO DE ERNES S.A.T. - LUGO
70 Frisona Española 212 m/a
CESARES BELELLE JAYZ/CESARES HOLSTEIN, S.C. - A CORUÑA
CESARES BERNESCA RUSH/CESARES HOLSTEIN, S.C. - A CORUÑA
CHAO IGLESIA LOLO 2883/CHAO IGLESIA S.A.T. 1207 XUGA - LUGO
CIVES XACOBEO 1663/CARREIRA DE CIVES, S.C. - A CORUÑA
COREN STEADY O 1375/ODILO BORRAJO E HIJOS, S.C. - OURENSE
COUQUIÑO-S.C. 513 WINDBROOK/COUQUIÑO, S.C. - A CORUÑA
COVA COXA/GANADERIA COVA - A CORUÑA
CRUCES ANTROIDO 7100/CASA DAS CRUCES - LUGO
DEL VALLE LAVANGUARD LEA/CASA DEL VALLE - LUGO
DELLA 1644/S.A.T. O CARBOEIRO - LUGO
DOCAMPO MAGREBI NOELIA/DO CAMPO - LUGO
EIRAS CAROLA ATWOOD/CASA EIRAS, S.C. - A CORUÑA
EL SOLAR LEONA RUBENS/EL ARROYO - VIZCAYA
EL.HAYA FEVER NETY/EL HAYA MATIENZO, C.B. - VIZCAYA
F.M. 3054 GABOR 7852/S.A.T. FAMILIA MARTINEZ - A CORUÑA
FERREIRO CLAUDIA COLBY/CASA FERREIRO - ASTURIAS
FERREIRO GERARD 2576/S.A.T. O FERREIRO 977 XUGA - A CORUÑA
FERREIRO XAROPE 7380/S.A.T. O FERREIRO 977 XUGA - A CORUÑA
FRUXINDE XACOBEO 8585/FRUXINDE, S.C. - LUGO
FRUXINDE ZELGADIS 5116/FRUXINDE, S.C. - LUGO
FULLEIRO ELEGANT 8602/GANADERIA FULLEIRO - A CORUÑA
G.DUBRA.S.C. 306/GANADERIA DUBRA, S.C. - A CORUÑA
G.DUBRA.S.C. 342/GANADERIA DUBRA, S.C. - A CORUÑA
G.PEREIRA GERARDO NORMA/ANTON - PONTEVEDRA
G.SAR XOIA ALEXANDER 150/GANDERIA SAR, S.L. - A CORUÑA
GABELLE 852/PORTALOUSA - LUGO
GAROLO CUNQUEIRO 6914/CASA GAROLO - LUGO
GIL SANCHEZ TULIPA/CASA DE GIL - LUGO
GOMELLE AIRRAID FOCA/S.A.T. GOMELLE 494 - LUGO
GOMELLE XACOBEO BATUKA/S.A.T. GOMELLE 494 - LUGO
GONZALEZ ALVAREZ REDENT.XATOLA/GONZALEZ ALVAREZ - LUGO
GORRELLA SIRA SID/GORRELLO, S.C. - ASTURIAS
GRANADERO DARTER NEVADA/CASA GRANADERO - LUGO
GRANDIO LAUTAMIC FURIA/CASA GRANDIO - LUGO
GRANDIO STEADY PETUNIA/CASA GRANDIO - LUGO
GRAÑA 46 XACOBEO/GRAÑA CAMBA, S.C. - A CORUÑA
IGREXA SID MONICA 446/GANADERIA CELTIGOS, S.L. - A CORUÑA
ILMA 113 MURRAY/S.A.T. 828 ILMA-XUGA - A CORUÑA
ILMA MORRISON 27/S.A.T. 828 ILMA-XUGA - A CORUÑA
JAIME SANCHEZ 453/S.A.T. EMILIO DO JAIME - LUGO
JERRIAMI 5292/CASA PENELAS - LUGO
JOSMAR GOLD CHIP PASTORA 2094/JOSMAR GANADERIA, S.C. - LUGO
LAGO DANCER 6922/GANADERIA LAGO - LUGO
LALA/FOCARA, S.C. - ASTURIAS
LINDA 1845/SANTA CRISTINA, S.C. - A CORUÑA
LISTE 934 XACOBEO/GANDERIA LISTE, S.C. - A CORUÑA
LISTE 964 DUNO/GANDERIA LISTE, S.C. - A CORUÑA
LORENA/VILADAELLE - ASTURIAS
LOUREIROS ANUSKA AMSTERDAM/RIAL DE LOUREIROS - A CORUÑA
LSCG 857 ALTAMETEOR/LANDEIRA SDAD.COOP.GALEGA - A CORUÑA
LUCHANA TKO 9827/CASA LUCHANA - LUGO
MANTOÑO BOLIVIA DONELLA/S.A.T. GAN. VILA DE SANTAIA - A CORUÑA
MARAGOTO MELBOURNE ESTRELLA/SAN MARTIÑO, S.A.T. - LUGO
MARTO SEAVER 4264/GANADERIA MARTO - A CORUÑA
MINERO SECRET 1678/LOPEZ ZOLLE, S.C. - LUGO
NAVE BUCKEYE MOESLY 1654/LA NAVE, S.C. - LUGO
NAVE GABOR LAU 9214/LA NAVE, S.C. - LUGO
NAVE SID KIMERA 5010/LA NAVE, S.C. - LUGO
NELETA/FOCARA, S.C. - ASTURIAS
NOVOA MONTORO ANUSKA/NOVOA, S.C. - LUGO
NUVEIRA BEIRA DANCER/NUVEIRA - A CORUÑA
NUVEIRA XATA AMSTERDAM/NUVEIRA - A CORUÑA
O LAMEIRO 2500 PELIQUEIRO/GANDEIRIA O LAMEIRO, S.C.G - A CORUÑA
OPORTO GABOR VANESA/PORTO - PONTEVEDRA
OSLOUREIROS PATAQUEIRA 566 WIN/GAN. OS LOUREIROS, S.C. - A CORUÑA
OUTEIRO LAKOTA LENA/BELLO - A CORUÑA
OUTEIRO STANLEYCUP LARA/SC GANADERIA OUTEIRO - LUGO
PACA DUPLEX MELISA 693/PACA, S.C. - LUGO
PALLON GOLOSO 5181/GANDEIRIA PALLON, S.C. - PONTEVEDRA
PALMERA 9328 BRODHER/SOTO - A CORUÑA
PENA DAMION BLITZ/GANADERIA PENA - LUGO
PENA DAMION SEPTEMBER/GANADERIA PENA - LUGO
PENA DUPLEX ALLEN/GANADERIA PENA - LUGO
PENA PRIMA 396 SPRINT/PENA-BAMELA, S.A.T. 931 XUGA - A CORUÑA
PENA RAMPAGE TALENTO ROJA/GANADERIA PENA - LUGO
PORTELA RIVAS MARGOT SALTARINA/PORTELA RIVAS, S.C. - LUGO
PORTELA RIVAS MERCURIO CHISPA/PORTELA RIVAS, S.C. - LUGO
POUSADOIRO 6197/GANADERIA O MERO,S.C. - A CORUÑA
POZOSAA JORDAN 6948 ROSIKA/DE POZO - LUGO
POZOSAA LAUTHORITY 6562 FRANCI/CASA POZO,S.C. - LUGO
PROAS DARRIBA MAGREBI NAVIDAD/G. PROAS DARRIBA, S.C. - PONTEVEDRA
PUMAREGA MARTA WYMAN/GANADERIA LA PUMAREGA, S.C. - ASTURIAS
QUINTIAN COLT P-RED ROSA ROJA/QUINTIAN, S.C. - LUGO
RAMOS MARIPOSA TALENT/RAMOS - A CORUÑA
REIGOSA DANCER CACHORRA/REIGOSA - PONTEVEDRA
REY XACOBEO ROUKA 5014/CASA REY - LUGO
RIO 5127 JEFFER 4247/S.A.T. RIO - LUGO
RIO LECCISO 4241/S.A.T. RIO - LUGO
ROMAN XACOBEO LUA/S.A.T. CASA ROMAN - LUGO
S.C.REGUEIRO 335 AMSTERDAM/DAMIAN REGUEIRO, S.C. - A CORUÑA
SAA SHOTTLE 8949/CASA DA SAA, S.C. - LUGO
SAN ANTONIO ALEXANDER 824/S.A.T. SAN ANTONIO - LUGO
SAN MIGUEL XACOBEO 367/S.A.T. SAN MIGUEL - LUGO
SAN XULIAN 5385 LAVANGUARD/S.A.T. SAN JULIAN - A CORUÑA
SAN-RIAN NAIR DEMPSEY/SAN RIAN SDAD.COOP.GALEGA - A CORUÑA
SAN-RIAN SHOWLEIRA ARTES ET/SAN RIAN S.COOP.GALEGA - A CORUÑA
SANTA MARIA CID 368-1051/STA.MARIA DE LOXO S.A.T. 1153 - A CORUÑA
SAT FERNANDO 915 BERNARDA XIC/C. FERNANDO SAT.1122 XUGA-A CORUÑA
SAT FERNANDO 925 VALERIA XILO/C FERNANDO SAT.1122 XUGA - A CORUÑA
SATDOCAMPO 835 MAGOT/DO CAMPO S.A.T. 975 XUGA - A CORUÑA
SATDOCAMPO 961 LAUTHORITY/DO CAMPO S.A.T. 975 XUGA - A CORUÑA
SEOANE JORDAN CHARLOTE 285/GANDEIRIA SEOANE,S C. - A CORUÑA
TARREO DANCER 519-5858/FINCA TARREO,S.A. - A CORUÑA
TASIL DANCER DUQUESA/SILVA - PONTEVEDRA
TASIL ROY ENCANTADORA/SILVA - PONTEVEDRA
TASIL XACOBEO ELENA 12/SILVA - PONTEVEDRA
TENDEIRO SANCHEZ 1298 ET/TENDEIRO,S.C. - LUGO
TENDEIRO XACOBEO 5773/TENDEIRO,S.C. - LUGO
TOMAS XACOBEO 1111/CASA TOMAS - LUGO
TOXAL BRANDY 4316/TOXAL - LUGO
TUMBIADOIRO Nº9091 RAYNO/MONASTERIO CISTERCIENSE - A CORUÑA
V.NEGRAL DUNO 917/S.A.T. VILLAMAYOR DE NEGRAL - LUGO
VALIÑA XACOBEO BADIOLA/VALIÑA - LUGO
VEIGAR XACOBEO GALLEGA/CASA DA VEIGA - PONTEVEDRA
VH PILAR ATWOOD 4360/S.A.T. FINCA EL PILAR 868 XUGA - A CORUÑA
VILA BOLTON MERA 4543/GRANXA VILA - LUGO
VILA WINDBROOK MORRIÑA 7693/GRANXA VILA - LUGO
VILARIÑO GRAND NIVEA 653/GRAN. VILARIÑO, S.A.T. 985 XUGA - A CORUÑA
VISPALIA GERARD MAGRA/S.A.T. AS PANDAS - LUGO
VISPALIA LASSON LILI/S.A.T. AS PANDAS - LUGO
VISPALIA SHOTTLE SAPA/S.A.T. AS PANDAS - LUGO
XACOBEO XACOBEO 9013/CASA XACOBE, S.C. - LUGO
XERCASPORTA XACOBEO PALOMA/PORTALOUSA - LUGO
XIANSA ARZUANA XACOBEO/XIANSA - A CORUÑA
063 ALBAÑIL SUPER 2868/CASA DO ALBAÑIL - LUGO
178-8046 MIMOSAS DIXIE/EIRA DAS MIMOSAS, S.C. - A CORUÑA
240/S.A.T. PUMARIÑO - A CORUÑA
0710 FARRAPA XACOBEO/S.A.T. A FARRAPA - A CORUÑA
0729 FARRAPA FEVER/S.A.T. A FARRAPA - A CORUÑA
1285/GANDEIRIA VENTURA, S.C. - A CORUÑA
1523 FARRAPA XACOBEO/S.A.T. A FARRAPA - A CORUÑA
2512 SANDRA ALTAIOTA/TUBIO BUSTO, S.C. - A CORUÑA
2695 MALENA/TRISCO, S.C. - A CORUÑA
3319/GANDEIRIA VENTURA, S.C. - A CORUÑA
560 2168 SPRINT/S.A.T. BUSTO-CORZON - A CORUÑA
6623 FARRAPA JORDAN/S.A.T. A FARRAPA - A CORUÑA
6654 FARRAPA GABOR/S.A.T. A FARRAPA - A CORUÑA
HEMBRAS MB DE 2º O MAS PARTOS - 85 PUNTOS
A ESTIVADA ATWOOD ANFORA/A ESTIVADA S.COOP.GALEGA - A CORUÑA
A PEDRA XACOBEO 481/A PEDRA S.A.T. Nº 1188 XUGA - A CORUÑA
A.PENIÑA XACOBEO RULA/GANDEIRIA S.A.T. PENIÑA 1043 - PONTEVEDRA
ALGRABUSAN SID 404-5544/S.A.T. ALGRABUSAN - LUGO
ALGRABUSAN XACOBEO 292-1526/S.A.T. ALGRABUSAN - LUGO
ALMA VIDALA DANCER/ALMA - A CORUÑA
ALMOZARA 861 TALENT/GANADERIA CELTIGOS, S.L. - A CORUÑA
ANDURIÑA DENA SID ET/ANDURIÑA - A CORUÑA
ANTELANA MAGREBI DANCER 14183/C.ANTELANA,S.C.GALEGA - OURENSE
AS REGAS MILLION 8362/S.A.T. AS REGAS N.924 XUGA - A CORUÑA
AUGASANTAS LEOPARD 549/AUGASANTAS S.A.T. Nº 1357 XUGA - A CORUÑA
AVELINO 2297 DANCER/CASTRO NOYA,S.C. - A CORUÑA
BALADO ANTONIA XACOBEO/BALADO - A CORUÑA
BARANGUEIRA LAUTAMIC LATA/CASA BARANGUEIRA - LUGO
BASADRE SID 5220/GANADERIA BASADRE - LUGO
BELLO 211 EXPLODE/BELLO - A CORUÑA
BERLAI DANCER 542/S.A.T. BERLAI - LUGO
BERLAI HOWIE 396/S.A.T. BERLAI - LUGO
BERTALO XACOBEO VALERIA/GRANJA SARA - LUGO
BOS EIRAS ESTRELLA WINDBR. ET/CASA EIRAS, S.C. - A CORUÑA
BOURIO CHENOA ALEXANDER/JOSE ANTONIO DE BOURIO,S.C. - ASTURIAS
BOURIO CORONA JORDAN/JOSE ANTONIO DE BOURIO,S.C. - ASTURIAS
CABADO SACHO CHINA/CASA GIL, S.C. - LUGO
CABO DOLMAN MODELO/CASA DO CABO - LUGO
CAMANZO SHOTTLE SHOTA/CAMANZO - PONTEVEDRA
CAMPA GOLD CHIP 1210/S.A.T. A CAMPA - A CORUÑA
CANDENDO 293/GANADERIA CANDENDO, S.C. - A CORUÑA
CANDENDO ATWOOD MARIA/GANADERIA CANDENDO, S.C. - A CORUÑA
CANEDA SANA GABOR/S.A.T. CANDESA - A CORUÑA
CARBOEIRO DELETE 7158/S.A.T. O CARBOEIRO - LUGO
CASA DE LOLA GOLONDRINA XACOBE/CASA DE LOLA - A CORUÑA
CASACURRO PIRATA XACOBEO/CASA CURRO - A CORUÑA
CASEIRODERNES WINDBROOK LAUHAN/CASEIRO DE ERNES S.A.T. - LUGO
CESARES BELELLE JAYZ/CESARES HOLSTEIN, S.C. - A CORUÑA
CESARES BERNESCA RUSH/CESARES HOLSTEIN, S.C. - A CORUÑA
CHAO IGLESIA LOLO 2883/CHAO IGLESIA S.A.T. 1207 XUGA - LUGO
CIVES XACOBEO 1663/CARREIRA DE CIVES, S.C. - A CORUÑA
COREN STEADY O 1375/ODILO BORRAJO E HIJOS, S.C. - OURENSE
COUQUIÑO-S.C. 513 WINDBROOK/COUQUIÑO, S.C. - A CORUÑA
COVA COXA/GANADERIA COVA - A CORUÑA
CRUCES ANTROIDO 7100/CASA DAS CRUCES - LUGO
DEL VALLE LAVANGUARD LEA/CASA DEL VALLE - LUGO
DELLA 1644/S.A.T. O CARBOEIRO - LUGO
m/a 212 Frisona Española 71

Calendario de Calificación

Mayo
Asturias, Cantabria, Álava, Vizcaya y Guipúzcoa

Junio

Cantabria, Navarra, Zaragoza, Huesca, Lérida y Soria
DOCAMPO MAGREBI NOELIA/DO CAMPO - LUGO
EIRAS CAROLA ATWOOD/CASA EIRAS, S.C. - A CORUÑA
EL SOLAR LEONA RUBENS/EL ARROYO - VIZCAYA
EL.HAYA FEVER NETY/EL HAYA MATIENZO, C.B. - VIZCAYA
F.M. 3054 GABOR 7852/S.A.T. FAMILIA MARTINEZ - A CORUÑA
FERREIRO CLAUDIA COLBY/CASA FERREIRO - ASTURIAS
FERREIRO GERARD 2576/S.A.T. O FERREIRO 977 XUGA - A CORUÑA
FERREIRO XAROPE 7380/S.A.T. O FERREIRO 977 XUGA - A CORUÑA
FRUXINDE XACOBEO 8585/FRUXINDE, S.C. - LUGO
FRUXINDE ZELGADIS 5116/FRUXINDE, S.C. - LUGO
FULLEIRO ELEGANT 8602/GANADERIA FULLEIRO - A CORUÑA
G.DUBRA.S.C. 306/GANADERIA DUBRA, S.C. - A CORUÑA
G.DUBRA.S.C. 342/GANADERIA DUBRA, S.C. - A CORUÑA
G.PEREIRA GERARDO NORMA/ANTON - PONTEVEDRA
G.SAR XOIA ALEXANDER 150/GANDERIA SAR, S.L. - A CORUÑA
GABELLE 852/PORTALOUSA - LUGO
GAROLO CUNQUEIRO 6914/CASA GAROLO - LUGO
GIL SANCHEZ TULIPA/CASA DE GIL - LUGO
GOMELLE AIRRAID FOCA/S.A.T. GOMELLE 494 - LUGO
GOMELLE XACOBEO BATUKA/S.A.T. GOMELLE 494 - LUGO
GONZALEZ ALVAREZ REDENT.XATOLA/GONZALEZ ALVAREZ - LUGO
GORRELLA SIRA SID/GORRELLO, S.C. - ASTURIAS
GRANADERO DARTER NEVADA/CASA GRANADERO - LUGO
GRANDIO LAUTAMIC FURIA/CASA GRANDIO - LUGO
GRANDIO STEADY PETUNIA/CASA GRANDIO - LUGO
GRAÑA 46 XACOBEO/GRAÑA CAMBA, S.C. - A CORUÑA
IGREXA SID MONICA 446/GANADERIA CELTIGOS, S.L. - A CORUÑA
ILMA 113 MURRAY/S.A.T. 828 ILMA-XUGA - A CORUÑA
ILMA MORRISON 27/S.A.T. 828 ILMA-XUGA - A CORUÑA
JAIME SANCHEZ 453/S.A.T. EMILIO DO JAIME - LUGO
JERRIAMI 5292/CASA PENELAS - LUGO
JOSMAR GOLD CHIP PASTORA 2094/JOSMAR GANADERIA, S.C. - LUGO
LAGO DANCER 6922/GANADERIA LAGO - LUGO
LALA/FOCARA, S.C. - ASTURIAS
LINDA 1845/SANTA CRISTINA, S.C. - A CORUÑA
LISTE 934 XACOBEO/GANDERIA LISTE, S.C. - A CORUÑA
LISTE 964 DUNO/GANDERIA LISTE, S.C. - A CORUÑA
LORENA/VILADAELLE - ASTURIAS
LOUREIROS ANUSKA AMSTERDAM/RIAL DE LOUREIROS - A CORUÑA
LSCG 857 ALTAMETEOR/LANDEIRA SDAD.COOP.GALEGA - A CORUÑA
LUCHANA TKO 9827/CASA LUCHANA - LUGO
MANTOÑO BOLIVIA DONELLA/SAT. GANADERIA VILA DE SANTAIA -A CORUÑA
MARAGOTO MELBOURNE ESTRELLA/SAN MARTIÑO, S.A.T. - LUGO
MARTO SEAVER 4264/GANADERIA MARTO - A CORUÑA
MINERO SECRET 1678/LOPEZ ZOLLE, S.C. - LUGO
NAVE BUCKEYE MOESLY 1654/LA NAVE, S.C. - LUGO
NAVE GABOR LAU 9214/LA NAVE, S.C. - LUGO
NAVE SID KIMERA 5010/LA NAVE, S.C. - LUGO
NELETA/FOCARA, S.C. - ASTURIAS
NOVOA MONTORO ANUSKA/NOVOA, S.C. - LUGO
NUVEIRA BEIRA DANCER/NUVEIRA - A CORUÑA
NUVEIRA XATA AMSTERDAM/NUVEIRA - A CORUÑA
O LAMEIRO 2500 PELIQUEIRO/GANDEIRIA O LAMEIRO, S.C.G - A CORUÑA
OPORTO GABOR VANESA/PORTO - PONTEVEDRA
OSLOUREIROS PATAQUEIRA 566 WIN/G. OS LOUREIROS, S.C. - A CORUÑA
OUTEIRO LAKOTA LENA/BELLO - A CORUÑA
OUTEIRO STANLEYCUP LARA/SC GANADERIA OUTEIRO - LUGO
PACA DUPLEX MELISA 693/PACA, S.C. - LUGO
PALLON GOLOSO 5181/GANDEIRIA PALLON, S.C. - PONTEVEDRA
PALMERA 9328 BRODHER/SOTO - A CORUÑA
PENA DAMION BLITZ/GANADERIA PENA - LUGO
PENA DAMION SEPTEMBER/GANADERIA PENA - LUGO
PENA DUPLEX ALLEN/GANADERIA PENA - LUGO
PENA PRIMA 396 SPRINT/PENA-BAMELA, S.A.T. 931 XUGA - A CORUÑA
PENA RAMPAGE TALENTO ROJA/GANADERIA PENA - LUGO
PORTELA RIVAS MARGOT SALTARINA/PORTELA RIVAS, S.C. - LUGO
PORTELA RIVAS MERCURIO CHISPA/PORTELA RIVAS, S.C. - LUGO
POUSADOIRO 6197/GANADERIA O MERO,S.C. - A CORUÑA
POZOSAA JORDAN 6948 ROSIKA/DE POZO - LUGO
POZOSAA LAUTHORITY 6562 FRANCI/CASA POZO,S.C. - LUGO
PROAS DARRIBA MAGREBI NAVIDAD/G. PROAS DARRIBA, S.C. - PONTEVEDRA
PUMAREGA MARTA WYMAN/GANADERIA LA PUMAREGA, S.C. - ASTURIAS
QUINTIAN COLT P-RED ROSA ROJA/QUINTIAN, S.C. - LUGO
RAMOS MARIPOSA TALENT/RAMOS - A CORUÑA
REIGOSA DANCER CACHORRA/REIGOSA - PONTEVEDRA
REY XACOBEO ROUKA 5014/CASA REY - LUGO
RIO 5127 JEFFER 4247/S.A.T. RIO - LUGO
RIO LECCISO 4241/S.A.T. RIO - LUGO
ROMAN XACOBEO LUA/S.A.T. CASA ROMAN - LUGO
S.C.REGUEIRO 335 AMSTERDAM/DAMIAN REGUEIRO, S.C. - A CORUÑA
SAA SHOTTLE 8949/CASA DA SAA, S.C. - LUGO
SAN ANTONIO ALEXANDER 824/S.A.T. SAN ANTONIO - LUGO
SAN MIGUEL XACOBEO 367/S.A.T. SAN MIGUEL - LUGO
SAN XULIAN 5385 LAVANGUARD/S.A.T. SAN JULIAN - A CORUÑA
SAN-RIAN NAIR DEMPSEY/SAN RIAN SDAD.COOP.GALEGA - A CORUÑA
SAN-RIAN SHOWLEIRA ARTES ET/SAN RIAN S.COOP.GALEGA - A CORUÑA
SANTA MARIA CID 368-1051/STA.MARIA DE LOXO S.A.T. 1153 - A CORUÑA
SAT FERNANDO 915 BERNARDA XIC/C. FERNANDO SAT.1122 XUGA-A CORUÑA
SAT FERNANDO 925 VALERIA XILO/C. FERNANDO SAT.1122 XUGA - A CORUÑA
SATDOCAMPO 835 MAGOT/DO CAMPO S.A.T. 975 XUGA - A CORUÑA
SATDOCAMPO 961 LAUTHORITY/DO CAMPO S.A.T. 975 XUGA - A CORUÑA
SEOANE JORDAN CHARLOTE 285/GANDEIRIA SEOANE,S C. - A CORUÑA
TARREO DANCER 519-5858/FINCA TARREO,S.A. - A CORUÑA
TASIL DANCER DUQUESA/SILVA - PONTEVEDRA
TASIL ROY ENCANTADORA/SILVA - PONTEVEDRA
TASIL XACOBEO ELENA 12/SILVA - PONTEVEDRA
TENDEIRO SANCHEZ 1298 ET/TENDEIRO,S.C. - LUGO
TENDEIRO XACOBEO 5773/TENDEIRO,S.C. - LUGO
TOMAS XACOBEO 1111/CASA TOMAS - LUGO
TOXAL BRANDY 4316/TOXAL - LUGO
TUMBIADOIRO Nº9091 RAYNO/MONASTERIO CISTERCIENSE - A CORUÑA
V.NEGRAL DUNO 917/S.A.T. VILLAMAYOR DE NEGRAL - LUGO
VALIÑA XACOBEO BADIOLA/VALIÑA - LUGO
VEIGAR XACOBEO GALLEGA/CASA DA VEIGA - PONTEVEDRA
VH PILAR ATWOOD 4360/S.A.T. FINCA EL PILAR 868 XUGA - A CORUÑA
VILA BOLTON MERA 4543/GRANXA VILA - LUGO
VILA WINDBROOK MORRIÑA 7693/GRANXA VILA - LUGO
VILARIÑO GRAND NIVEA 653/G. VILARIÑO, S.A.T. 985 XUGA - A CORUÑA
VISPALIA GERARD MAGRA/S.A.T. AS PANDAS - LUGO
VISPALIA LASSON LILI/S.A.T. AS PANDAS - LUGO
VISPALIA SHOTTLE SAPA/S.A.T. AS PANDAS - LUGO
XACOBEO XACOBEO 9013/CASA XACOBE, S.C. - LUGO
XERCASPORTA XACOBEO PALOMA/PORTALOUSA - LUGO
XIANSA ARZUANA XACOBEO/XIANSA - A CORUÑA
063 ALBAÑIL SUPER 2868/CASA DO ALBAÑIL - LUGO
178-8046 MIMOSAS DIXIE/EIRA DAS MIMOSAS, S.C. - A CORUÑA
240/S.A.T. PUMARIÑO - A CORUÑA
560 2168 SPRINT/S.A.T. BUSTO-CORZON - A CORUÑA
0710 FARRAPA XACOBEO/S.A.T. A FARRAPA - A CORUÑA
0729 FARRAPA FEVER/S.A.T. A FARRAPA - A CORUÑA
1285/GANDEIRIA VENTURA, S.C. - A CORUÑA
1523 FARRAPA XACOBEO/S.A.T. A FARRAPA - A CORUÑA
2512 SANDRA ALTAIOTA/TUBIO BUSTO, S.C. - A CORUÑA
2695 MALENA/TRISCO, S.C. - A CORUÑA
3319/GANDEIRIA VENTURA, S.C. - A CORUÑA
6623 FARRAPA JORDAN/S.A.T. A FARRAPA - A CORUÑA
6654 FARRAPA GABOR/S.A.T. A FARRAPA - A CORUÑA
Resumen de Calificación por tipo 2016. Categorías: n
72 Frisona Española 212 m/a
Meses Excelentes Muy Buenos Más que Buenos Buenos Regulares Insuficientes Aptas Hembras Totales Total Animales Total Ganaderías visitadas Machos Hembras Machos Hembras Machos Hembras Machos Hembras Machos Hembras Machos Hembras Machos Hembras Enero 0 21 2 494 7 5.086 0 4.744 0 295 0 2 579 9 11.221 11.230 611 Febrero 0 6 4 507 12 5.663 5 5.375 0 457 0 3 629 21 12.640 12.661 847 TOTAL 0 27 6 1.001 19 10.749 5 10.119 0 752 0 5 1.208 30 23.861 23.891 1.458
25 años ayudándote a crecer
Detrás de todos nuestros productos existe un asesoramiento y supervisión técnica para lograr mayor equilibrio, mejor rendimiento y más calidad
NUEVA PLATAFORMA DE FORMACIÓN ONLINE

“NO SÓLO SOBREVIVE EL QUE ES más fuerte ni el más inteligentE, sino el que se adapta mejor al cambio” CharLes

www.nutricor .es
R. Darwin (1809 - 1882) cr3ativa.com
Mejores vacas en producción
A continuación aparecen las 25 mejores productoras por kg de grasa + kg de proteína a 305 días en 1ª, 2ª, 3ª, 4ª, 5ª y 6ª lactación o posteriores, según acuerdo adoptado por la Junta de Gobierno de CONAFE.
Las producciones a 305 días corresponden a las lactaciones finalizadas en el período del 1 de octubre de 2014 al 30 de septiembre de 2015, enviadas a CONAFE por los organismos responsables del control lechero en las CC.AA.
Las edades mínimas y máximas (años, meses) admitidas para cada lactación son las siguientes:
Los límites aplicados a los porcentajes por lactación de grasa y proteína son:
2 ≤ % grasa ≤ 6
2 ≤ % proteína ≤ 5
Los porcentajes de grasa y proteína de todos y cada uno de los controles individuales, hasta los 305 días de lactación, deben cumplir los filtros aplicados en evaluación genética, que son:
1,5 ≤ % grasa ≤ 7
1 ≤ % proteína ≤ 5
Los índices genéticos que acompañan a los datos de producción pertenecen a la última evaluación genética de noviembre de 2015.
La información sobre estos animales se puede ampliar en la página web www.conafe.com, a través del servicio SinbadFree
Vacas de 1ª lactación

Vacas de 2ª lactación

Nombre y nº genealógico Califica. Morfológ. Edad al parto kg Leche kg Gra. + kg Prot. kg Grasa % Grasa kg Proteí. % Proteí. V. Genética Padre Ganadería propietaria Leche Grasa Proteí. IGT Penedo Flor Chamoso ESPH1503593756 78 2,01 16.441 1.227 704 4,28 523 3,18 800 37 27 0,93 Chamoso Finca Marisa/A Coruña Fermar 898 ESPH3403749672 81 1,11 16.643 1.166 655 3,93 511 3,07 1117 47 41 0,16 Fiction Hnos. Fernández Martín, S.C./Palencia Estabano SC Geneva Tomba ESPH2703427688 82 2,07 14.843 1.161 675 4,54 486 3,27 1333 48 37 1,06 Geneva Estebano, S.C./Lugo 8356 ESPH3903856653 82 2,03 14.202 1.148 658 4,63 490 3,45 913 30 35 0,14 Zenjo S.A.T. Ventisca Nº 7102/Cantabria 1330 Ross ESPH2803478338 80 2,05 14.664 1.135 662 4,51 473 3,22 846 29 30 0,68 Altaross Hiflomar, S.A.T./Madrid Fdez_Fdez Diana ESPH2403549475 76 2,06 14.176 1.134 686 4,83 448 3,16 1237 39 42 -0,16 Usonet Fin Fernández Fernández, S.C./León Valdenebro 293 ESPH2803478666 78 2,10 14.602 1.133 699 4,78 434 2,97 1279 60 32 0,67 Beacon Exp. Ganadera Valdenebro/Madrid 1336 Manifold ESPH2803666520 83 2,00 13.953 1.133 690 4,94 443 3,17 1616 72 57 1,79 Manifold Hiflomar, S.A.T./Madrid 460 ESPH2403233180 80 3,02 15.758 1.130 621 3,94 509 3,23 1481 32 49 0,,08 Usonet Fin Herrero Méndez, S.C./León Blanco Valiant Bess Rose ESPH3603491041 86 2,08 17.989 1.126 579 3,21 547 3,04 1417 47 25 2,08 Delete Blanco/Pontevedra Moro Otto 1110 ESPH4503293545 74 3,03 15.033 1.124 635 4,22 489 3,25 1045 63 38 -0,52 Otto El Moro de Castillo S.L./Toledo Rey 547 Sonrrisa Sid ESPH2703525149 87 2,04 12.786 1.123 700 5,47 423 3,30 391 40 23 2,33 Sid S.A.T. Rey de Miñotelo/Lugo Bos Maceiras Million Judith ET ESPH3603391498 75 3,00 14.852 1.117 640 4,30 477 3,21 1110 42 34 1,34 Million Gandeiria Maceiras SAT/Pontevedra Campo Cricket Boukje ET ESPH3903857990 77 2,03 13.473 1.115 674 5,00 441 3,27 133 39 20 0,28 Cricket S.A.T. El Campo de Anero/Cantabria 665 ESPH2803667911 RA-A 3,04 15.950 1.112 629 3,94 483 3,02 SAT N.18 Soto de Navalafuente/Madrid Seixas Fever 3125 ESPH2703530858 83 2,11 16.041 1.109 659 4,10 450 2,80 618 36 18 1,39 Fever S.A.T. Seixas/Lugo 3391 ESPH1503584203 78 2,03 14.117 1.107 629 4,45 478 3,38 870 49 31 0,35 Dono Ganadería Carballeira, S.C./A Coruña Berzal_Martin 1069 ESPH4003636051 84 2,02 16.141 1.105 646 4,00 459 2,84 1689 39 39 1,61 Sylvester Berzal Martín, S.C./Segovia Eiras Artes Princesa ESPH2703630811 81 2,06 13.474 1.101 641 4,75 460 3,41 800 44 30 1,86 Artes S.A.T. Pazo de Eiras/Lugo Cantarranas Pride 1943 ESPH1303510892 74 2,03 15.422 1.097 630 4,08 467 3,02 1160 46 31 0,05 Pride Finca Cantarranas/Ciudad Real Penedo Adriana Sid ESPH1503682906 78 2,02 14.584 1.095 626 4,29 469 3,21 667 24 19 1,25 Sid Finca Marisa/A Coruña 1319 Manifold ESPH2803664914 79 1,11 12.730 1.093 683 5,36 410 3,22 1207 65 43 0,36 Manifold Hiflomar, S.A.T./Madrid SAT Varela Sid 709 ESPH2703580064 81 2,01 11.736 1.090 691 5,88 399 3,39 206 53 27 1,70 Sid S.A.T. Varela 992 Xuga/Lugo Carreira Shottle Flor ESPH2703486765 82 2,06 13.484 1.089 672 4,98 417 3,09 1129 62 23 1,23 Shottle Casa Carreira/Lugo Gonzar Toystory 6422 ESPH2703580285 81 2,01 13.589 1.086 640 4,70 446 3,28 1865 74 49 0,99 Toystory S.A.T. Gonzar/Lugo
Nº Parto Edad Nº Parto Edad mínima máxima mínima máxima 1 1,6 3,4 5 4,10 9,2 2 2,4 4,11 6 5,8 10,6 3 3,2 6,5 7 ó + 6,6 11,10 4 4,0 7,10 Nombre y nº genealógico Califica. Morfológ. Edad al parto kg Leche kg Gra. + kg Prot. kg Grasa % Grasa kg Proteí. % Proteí. V. Genética Padre Ganadería propietaria Leche Grasa Proteí. IGT Fdez_Fdez Naty ESPH2403347124 81 3,02 18.679 1.462 912 4,88 550 2,94 1658 62 48 0,05 Usonet Fin Fernández Fernández, S.C./León Barbeiro Xacobeo Perica ESPH2703315031 85 3,07 20.731 1.441 798 3,84 643 3,10 1269 46 34 1,71 Xacobeo Casa Barbeiro, S.C./Lugo SAT Varela Xacobeo 675 ESPH2703426225 81 2,11 17.266 1.422 879 5,09 543 3,14 1215 48 37 2,18 Xacobeo S.A.T. Varela 992 Xuga/Lugo Sf. 406 4933 BaxterESPH1503263715 82 4,00 16.976 1.421 927 5,46 494 2,90 1250 64 27 0,96 Baxter S.A.T. Fontecoba Xuga/A Coruña E. Bolton Straus Vicuña ESPH3903285769 85 3,01 15.678 1.417 860 5,48 557 3,55 1733 79 56 1,56 Bolton S.A.T. Los Tanagos Nº 7243/Cantabria Cristiana 7476 Cubela Shottle ESPH1503419743 86 3,01 15.006 1.408 975 6,49 433 2,88 1174 55 33 1,71 Shottle
S.A.T./A Coruña Reigada Calino 8667 ESPH2703314388 82 3,04 17.811 1.405 806 4,52 599 3,36 1021 58 33 1,15 Calino
Control Lechero
Cubela Xuga
Reigada, S.L./Lugo
74 Frisona Española 212 m/a



Vacas de 2ª lactación Vacas de 3ª lactación Vacas de 4ª lactación Nombre y nº genealógico Califica. Morfológ. Edad al parto kg Leche kg Gra. + kg Prot. kg Grasa % Grasa kg Proteí. % Proteí. V. Genética Padre Ganadería propietaria Leche Grasa Proteí. IGT SAT Varela Altaiota 717 ESPH2703591469 78 2,10 17.145 1.404 872 5,08 532 3,10 1270 59 47 1,29 Altaiota S.A.T. Varela 992 Xuga/Lugo Framboise ESPH2203665917 80 3,00 19.156 1.394 778 4,06 616 3,21 1404 64 54 1,05 Stol Joc Granja San José S.A./Huesca Fermar 679 ESPH3403241975 81 3,08 19.062 1.382 791 4,14 591 3,10 1481 66 48 1,22 Jobess Hnos. Fernández Martín, S.C./Palencia Bianca 703 ESPH2703891728 RA-A 3,02 16.168 1.370 803 4,96 567 3,50 S.A.T. A Campiña/Lugo Herradura Bolton Gerla ESPH4003344176 84 3,05 21.211 1.370 714 3,36 656 3,09 1789 25 42 1,08 Bolton Torres Sdad. Civil/Segovia Outeiro Howie Mireya ESPH2703270789 80 3,04 15.458 1.364 919 5,94 445 2,87 1836 49 35 0,89 Howie Casa Gabino/Lugo H. Geneva Samina ESPH4003451306 79 2,11 16.582 1.359 830 5,00 529 3,19 1470 47 35 0,96 Geneva Torres Sdad. Civil/Segovia Bea 147 0232 ESPH2703784748 79 3,01 14.576 1.352 900 6,17 452 3,10 451 43 28 -0,60 Surprise S.A.T. Lado/Lugo Gala Bolton Señorita ESPH4003445890 78 3,02 19.017 1.348 741 3,89 607 3,19 1571 43 43 0,79 Bolton Gala Merino, S.C./Segovia SAT Varela Shottle 694 ESPH2703522283 80 3,00 16.248 1.347 844 5,19 503 3,09 792 44 26 0,69 Shottle S.A.T. Varela 992 Xuga/Lugo Favorite ESPH2203664294 RA-A 3,08 18.905 1.342 699 3,69 643 3,40 201 8 8 -0,17 Granja San José S.A./Huesca Campo Baylen ESPH3903284359 80 3,11 21.715 1.340 780 3,59 560 2,57 529 -4 18 -0,35 Fortune S.A.T. El Campo de Anero/Cantabria Herradura Shottle Dalila ESPH4003453779 80 3,03 16.898 1.339 749 4,43 590 3,49 896 50 29 0,87 Shottle Torres Sdad. Civil/Segovia Seixas Fever 4678 ESPH2703515896 76 3,01 17.120 1.330 783 4,57 547 3,19 1280 53 48 0,67 Fever S.A.T. Seixas/Lugo Sf 391-1419 Blitz ESPH1503213237 82 4,01 17.445 1.326 853 4,88 473 2,71 1681 33 22 0,91 Blitz S.A.T. Fontecoba Xuga/A Coruña SAT Varela Jordan 691 ESPH2703522280 79 3,03 15.929 1.320 800 5,02 520 3,26 466 30 18 0,91 Jordan S.A.T. Varela 992 Xuga/Lugo Mariposa 1669 Cubela Xaco. ESPH1503413746 80 3,01 15.738 1.311 866 5,50 445 2,82 2107 34 39 1,36 Xacobeo Cubela Xuga S.A.T./A Coruña Crespo Marion 4070 Risa ESPH2703411444 85 3,07 21.517 1.309 725 3,36 584 2,71 1639 37 22 0,86 Marion Casa Crespo/Lugo Nombre y nº genealógico Califica. Morfológ. Edad al parto kg Leche kg Gra. + kg Prot. kg Grasa % Grasa kg Proteí. % Proteí. V. Genética Padre Ganadería propietaria Leche Grasa Proteí. IGT Caseiro Miquel 6964 ESPH2703264030 81 4,01 14.440 1.468 974 6,74 494 3,42 -68 28 8 0,11 Miquel S.A.T. Caseiro 991 Xuga/Lugo Barbeiro Mimosa ESPH2703517182 RA-A 4,07 22.281 1.452 795 3,56 657 2,94 Casa Barbeiro, S.C./Lugo Herradura Shottle Magnifica ESPH4003239486 86 4,10 23.416 1.448 759 3,24 689 2,94 1654 35 38 1,37 Shottle Torres Sdad. Civil/Segovia 0264 ESPH2403449784 RA-A 4,08 17.554 1.445 902 5,13 543 3,09 Ganadería Flórez Fdez., S.C./León Cid Goldwyn Sonda ESPH2703157787 85 4,05 18.298 1.438 860 4,69 578 3,15 1068 48 30 1,15 Goldwyn Gandeiria Cid, S.C./Lugo Conchados Blitz 9635 ESPH2703209535 81 4,02 15.525 1.436 972 6,26 464 2,98 1121 27 17 0,77 Blitz Conchados, S.C./Lugo 2472 ESPH1503317822 80 4,01 16.728 1.419 863 5,15 556 3,32 523 38 20 1,00 Baxter Ganadería Carballeira, S.C./A Coruña 472 MH ESPH0503039847 80 4,10 17.959 1.414 865 4,81 549 3,05 1637 51 41 0,37 Alino M.H. S.C./Ávila Xacobo Mercurio Nº140 ESPH1503168212 86 4,04 14.241 1.409 964 6,76 445 3,12 986 52 30 0,94 Mercurio G. Xacobo/A Coruña Veiguela Jocko Besn Suki ESPH2703062482 77 5,00 17.076 1.406 879 5,14 527 3,08 718 27 27 0,34 Jocko Besn Casa Veiguela/Lugo SAT Varela Shottle 590 ESPH2703207988 79 3,11 15.793 1.406 849 5,37 557 3,52 758 72 47 1,19 Shottle S.A.T. Varela 992 Xuga/Lugo Bea 9280 Cubela Blitz ESPH1503060215 76 4,10 19.076 1.400 903 4,73 497 2,60 2317 32 33 0,63 Blitz Cubela Xuga S.A.T./A Coruña Castragu. Susao Hedra Bolton ESPH2703204657 85 4,08 16.333 1.385 899 5,50 486 2,97 1317 65 37 0,71 Bolton Vilar de Susao/Lugo Vietes Grata Duplex ESPH1503049439 86 5,03 17.204 1.383 834 4,84 549 3,19 967 32 37 1,26 Duplex Vieites/A Coruña SAT Varela Buckeye 614 ESPH2703269946 79 3,11 14.577 1.373 834 5,72 539 3,69 303 46 33 1,09 Buckeye S.A.T. Varela 992 Xuga/Lugo Nave Affirmed Naftalina 9746 ESPH2703010494 82 5,08 13.959 1.370 890 6,37 480 3,43 -14 16 11 0,22 Affirmed La Nave, S.C./Lugo SAT Varela Bolton 545 ESPH2703047206 79 4,07 18.786 1.370 825 4,39 545 2,90 977 39 18 0,82 Bolton S.A.T. Varela 992 Xuga/Lugo San Isidro Xacobeo Mª Luisa ESPH0503131958 85 4,08 15.776 1.364 841 5,33 523 3,31 885 39 30 1,04 Xacobeo Granja San Isidro/Ávila 0702 Win ESPH0502926445 81 5,02 19.441 1.355 785 4,03 570 2,93 1470 38 36 -1,14 Win 395 Álvarez Fuentes, S.C.P./Ávila Herradura Jeeves Golosa ESPH4003239492 85 4,03 18.185 1.351 787 4,32 564 3,10 786 12 19 0,32 Jeeves Torres Sdad. Civil/Segovia Sat Varela Ashlar 620 ESPH2703275786 79 4,04 16.158 1.347 816 5,05 531 3,28 333 27 17 1,03 Ashlar S.A.T. Varela 992 Xuga/Lugo Ferreiro Talent Shelby II ESPH3303230067 91 4,04 18.808 1.346 711 3,78 635 3,37 249 -7 10 2,17 Talent Ganadería Ferreiro, S.C./Asturias Lodos Stol Joc Zaneta ESPH2703063311 81 4,06 18.447 1.345 765 4,14 580 3,14 2104 56 64 1,33 Stol Joc S.A.T. Lodos e Perez N.940 Xuga/Lugo Campo Gloria ESPH3903191331 80 4,04 17.413 1.342 753 4,32 589 3,38 536 26 32 0,33 Paramount S.A.T. El Campo de Anero/Cantabria Campo Sevilla ESPH3903184807 82 4,04 19.138 1.341 747 3,90 594 3,10 982 46 33 1,04 Pagewire S.A.T. El Campo de Anero/Cantabria Nombre y nº genealógico Califica. Morfológ. Edad al parto kg Leche kg Gra. + kg Prot. kg Grasa % Grasa kg Proteí. % Proteí. V. Genética Padre Ganadería propietaria Leche Grasa Proteí. IGT SAT Varela Talent 506 ESPH2702911429 82 5,11 19.369 1.564 974 5,02 590 3,04 60 5 8 1,36 Talent S.A.T. Varela 992 Xuga/Lugo SAT Varela Buckeye 450 ESPH2702718344 83 7,00 18.602 1.535 918 4,93 617 3,31 476 16 22 0,81 Buckeye S.A.T. Varela 992 Xuga/Lugo Raula 8381 Blitz ESPH1503013931 80 5,08 17.627 1.476 917 5,20 559 3,17 1025 58 27 0,05 Blitz Ganadería do Mouro, S.C./A Coruña SAT Varela Buckeye 555 ESPH2703062537 77 5,00 17.433 1.416 868 4,97 548 3,14 278 12 8 0,51 Buckeye S.A.T. Varela 992 Xuga/Lugo Blancoh. Dancer Leire ESPH3603057213 87 5,08 20.405 1.408 771 3,77 637 3,12 568 -1 9 1,80 Dancer Blanco/Pontevedra Grande Lida Samu. Lawrence ESPH2702715740 87 7,00 14.824 1.407 937 6,32 470 3,17 -158 25 10 1,43 Samuelo S.A.T. Grande/Lugo Alto Miño Bolton Callie ET ESPH2702840400 81 6,02 17.718 1.403 851 4,80 552 3,11 856 25 28 1,69 Bolton S.A.T. Varela 992 Xuga/Lugo 0570 ESPH2703050253 RA-A 7,00 19.182 1.402 822 4,28 580 3,02 S.A.T. Os Foros/Lugo Ferpar 9666 Ginebre ESPH2702907671 80 5,09 15.057 1.386 896 5,95 490 3,25 53 51 11 -0,27 Ginebre Ganaderías Ferpar, S.C./Lugo Danube 2713 ESPH1503375962 83 5,08 19.797 1.386 726 3,66 660 3,33 710 25 33 0,41 Asidor S.A.T. Finca A Cortiña/A Coruña Aglae ESPH2703005179 78 7,04 14.470 1.379 878 6,06 501 3,46 441 56 34 -0,38 Nezel Lord S.A.T. Lamelas 982 Xuga/Lugo Edrada Botafogo Puleva ESPH2703019545 82 5,04 18.536 1.371 783 4,22 588 3,17 915 38 37 0,38 Botafogo S.A.T. Edrada 1113 Xuga/Lugo Sanjose Jazzman Acelga ESPH2203002200 79 5,07 20.810 1.370 735 3,53 635 3,05 1309 45 40 0,55 Jazzman Granja San José S.A./Huesca SAT Varela Throno 523 ESPH2702957735 80 5,06 15.191 1.369 858 5,64 511 3,36 369 27 11 0,49 V.T. Throno S.A.T. Varela 992 Xuga/Lugo Boto Danesa ESPH3303301984 RA-A 5,09 17.306 1.369 805 4,65 564 3,25 Boto/Asturias Rio Zesty 219 ESPH3703033729 79 5,03 17.469 1.366 808 4,62 558 3,19 1141 39 48 0,77 Zesty Los del Rio, S. Coop./Salamanca m/a 212 Frisona Española 75
Vacas de 4ª lactación



Vacas de 5ª lactación
de 6ª
Nombre y nº genealógico Califica. Morfológ. Edad al parto kg Leche kg Gra. + kg Prot. kg Grasa % Grasa kg Proteí. % Proteí. V. Genética Padre Ganadería propietaria Leche Grasa Proteí. IGT Filia 3482 ESPH3603106883 RA-A 6,10 15.646 1.361 821 5,24 540 3,45 Val do Toxa, S.C. Galega/Pontevedra Stilma 500 Pintada ESPH1503329817 77 5,04 19.456 1.355 726 3,73 629 3,23 86 8 20 -0,31 Hole One Casa Jacinto/A Coruña V.Negral Roumare 944 ESPH2702953325 84 5,08 14.755 1.354 848 5,74 506 3,42 211 34 26 1,30 Roumare S.A.T. Villamayor se Negral/Lugo Senne 26 1515 ESPH2703413881 83 5,08 17.841 1.351 755 4,23 596 3,34 834 29 32 0,84 Senna S.A.T. O Carboeiro/Lugo Liesbeth 101 ESPH1503212215 86 5,11 20.915 1.351 665 3,17 686 3,27 974 23 36 -0,54 Tikonna Coop. Ag. Provincial Coruña/A Coruña Barbeiro Pekechu Xusta ESPH2703162610 80 5,03 19.979 1.342 715 3,57 627 3,13 641 18 19 0,94 Pekechu Casa Barbeiro, S.C./Lugo SAT Seixas Buckeye 7526 ESPH2703013085 75 5,05 15.954 1.340 827 5,18 513 3,21 717 35 25 -0,73 Buckeye S.A.T. Seixas/Lugo 5238 ESPH2703048769 RA-A 5,08 16.838 1.339 846 5,02 493 2,92 Ganadería Puluan, S.C./Lugo Dolcevita ESPH2703481193 82 5,07 15.548 1.338 780 5,01 558 3,58 708 44 51 1,25 Stol Joc S.A.T. Os Arroxos/Lugo Nombre y nº genealógico Califica. Morfológ. Edad al parto kg Leche kg Gra. + kg Prot. kg Grasa % Grasa kg Proteí. % Proteí. V. Genética Padre Ganadería propietaria Leche Grasa Proteí. IGT Pedron-Ponte Curro Lula ESPH2702892691 80 7,00 18.906 1.482 897 4,74 585 3,09 766 26 22 0,16 Curro Pedrón A Ponte S.A.T./Lugo Taboada Elegant Cholita ESPH2702947448 80 6,00 16.227 1.470 967 5,95 503 3,09 151 25 13 0,78 Elegant S.A.T. Lodos e Pérez N.940 Xuga/Lugo Cancela Storma. Menta 7591 ESPH2702701377 85 7,11 17.728 1.469 914 5,15 555 3,13 1059 30 33 1,07 Stormatic La Nave, S.C./Lugo Casilmoure Goldwyn Laura ESPH2702784187 90 6,09 17.354 1.447 775 4,46 672 3,87 -21 24 17 1,21 Goldwyn Blanco/Pontevedra Ni'jbrook Lize 219 ESPH1503221621 85 6,09 17.387 1.431 901 5,18 530 3,04 519 22 21 0,36 Julius Granxa Vilariño, S.A.T. 985/A Coruña SAT Varela Goldwyn 457 ESPH2702771478 86 6,07 17.942 1.402 843 4,69 559 3,11 845 40 29 1,72 Goldwyn S.A.T. Varela 992 Xuga/Lugo SAT Seixas Buckeye 8788 ESPH2703065440 78 6,11 18.678 1.394 863 4,62 531 2,84 1071 40 29 0,75 Buckeye S.A.T. Seixas/Lugo Algrabusan Toystory 989-1651 ESPH2703019560 81 5,10 15.067 1.380 865 5,74 515 3,41 960 54 40 0,99 Toystory S.A.T. Algrabusan/Lugo Coba 209 7645 ESPH1503159920 79 6,07 15.927 1.378 855 5,36 523 3,28 546 52 39 -0,56 Delta O. S.A.T. A Farrapa/A Coruña Fondal Escribana Bolton ESPH1502949070 81 6,08 16.918 1.337 842 4,97 495 2,92 1991 53 50 1,60 Bolton S.A.T. 913 O Fondal Aboi/A Coruña Escairo Jamie Sofia ESPH2702784528 78 6,06 16.139 1.332 852 5,27 480 2,97 449 33 5 -0,91 Jamie Casa de Polo, S.C./Lugo Vilar-Alaxe Dolman 566 ESPH2702845966 84 6,06 14.739 1.327 819 5,55 508 3,44 393 39 26 1,48 Dolman S.A.T. Vilar-Alaxe/Lugo Catro Camiños Botafogo 2200 ESPH2702839306 78 6,04 16.842 1.323 792 4,70 531 3,15 1318 49 51 0,34 Botafogo S.A.T. Catro Camiños/Lugo Cabana Buckeye 574 ESPH2702838361 81 6,05 15.348 1.320 808 5,26 512 3,33 260 20 15 0,71 Buckeye S.A.T. Cabana/Lugo Asunción Goldwyn Roseta ESPH1502645840 90 7,07 17.133 1.320 802 4,68 518 3,02 380 35 18 2,36 Goldwyn S.A.T. Casa Carballo 1023 Xuga/Lugo Anduriña Chamoso Andrea ESPH2702903505 78 6,06 16.135 1.318 833 5,16 485 3,00 720 18 11 0,21 Chamoso SC Ganadería Anduriña/Lugo Mia 4486 ESPH1503158088 81 7,02 16.957 1.306 792 4,67 514 3,03 1207 47 34 -0,05 Luzian S.A.T. Lavandeira 950 Xuga/A Coruña Herman 2181 ESPH3702727460 75 8,00 17.403 1.304 780 4,48 524 3,01 883 37 33 -0,80 Its Cesáreo Alonso Beneitez/Salamanca Katya ESPH2703162902 82 7,00 15.910 1.295 804 5,05 491 3,08 433 44 17 0,10 Herold S.A.T. Os Arroxos/Lugo 1877 Elsa II ESPH3303089922 85 7,01 16.765 1.291 730 4,35 561 3,34 -87 20 8 1,08 Talent Ganadería Ferreiro, S.C./Asturias Nave Goldwyn Grada 2446 ESPH2703053359 83 5,09 14.605 1.289 828 5,66 461 3,15 404 22 18 1,35 Goldwyn La Nave, S.C./Lugo SAT Varela Buckeye 466 ESPH2702826956 80 6,06 16.693 1.285 745 4,46 540 3,23 218 -9 7 0,08 Buckeye S.A.T. Varela 992 Xuga/Lugo Foros Elegant Duquesa ESPH2702945428 85 6,03 19.435 1.281 647 3,32 634 3,26 1098 31 39 0,75 Elegant S.A.T. Os Foros/Lugo Marialba Rineau Juerga ESPH4902878704 79 5,10 16.036 1.280 733 4,57 547 3,41 416 72 27 -0,28 Rineau J. S.A.T. Rote/Zamora Freda Builder ESPH3302802701 85 7,04 17.711 1.277 744 4,20 533 3,00 765 49 23 0,57 Builder Ganadería Remeye, S.C./Asturias Nombre y nº genealógico Califica. Morfológ. Edad al parto kg Leche kg Gra. + kg Prot. kg Grasa % Grasa kg Proteí. % Proteí. V. Genética Padre Ganadería propietaria Leche Grasa Proteí. IGT Huertona Mansa Romero ESPH3302672197 86 7,10 20.008 1.549 947 4,73 602 3,00 526 37 21 1,15 Romero La Huertona/Asturias Blanco.H Duplex Sonia 315 ESPH3602655764 90 8,03 18.717 1.437 843 4,50 594 3,17 185 10 11 1,67 Duplex Blanco/Pontevedra 9201 Rudolph Saa ESPH2702346991 77 8,09 14.564 1.310 905 6,21 405 2,78 301 13 5 -0,77 Rudolph Casa Da Saa, S.C./Lugo Sanjose Zenith Lusi ESPH2202918577 77 6,09 18.257 1.309 730 3,99 579 3,17 889 50 34 0,25 Zenith Granja San José S.A./Huesca Barbeiro Jocko Besn Kala ESPH2702526447 80 8,03 18.020 1.307 712 3,95 595 3,30 798 21 28 -0,07 Jocko Besn Casa Barbeiro, S.C./Lugo Lence Belelle Liz 0995 ESPH2702411516 84 9,09 13.719 1.301 846 6,16 455 3,31 219 38 16 -0,01 Belelle La Nave, S.C./Lugo Saa Emerson 3019 ESPH2702710369 85 7,06 16.568 1.295 842 5,08 453 2,73 902 32 18 0,36 Emerson Casa da Saa, S.C./Lugo Veiguela Odiart Chusa ESPH2702770863 78 7,01 15.958 1.278 826 5,17 452 2,83 153 -8 -8 0,31 Odiart Casa Veiguela/Lugo 68 ESPH2702845465 78 8,02 15.165 1.276 782 5,15 494 3,25 -568 -11 -5 -0,72 Rudi S.A.T. Lamelas 982 Xuga/Lugo Berlai Curro 8496 ESPH2702658560 76 7,05 13.003 1.270 803 6,17 467 3,59 595 55 27 -0,80 Curro S.A.T. Berlai/Lugo Bruintje 83 ESPH3702601497 80 11,00 15.330 1.260 799 5,21 461 3,00 -430 32 2 -0,57 Rembrandt Cigarrilla, Sdad. Coop./Salamanca Saa Manat 7777 ESPH2702478166 82 8,07 13.389 1.256 871 6,50 385 2,87 205 22 5 0,51 Manat Casa da Saa, S.C./Lugo Los Valles Burberrys 528 ESPH4002461570 79 8,11 16.133 1.256 764 4,73 492 3,04 -530 -23 -15 -0,36 Burberrys Artemio Martín e Hijos, S.C./Segovia Picancillo V. Eaton Bombi 014 ESPH3702879109 RA-A 8,11 17.972 1.251 671 3,73 580 3,22 Picancillo/Salamanca Beauty 9543 Roja ESPH1503016117 76 6,10 19.037 1.249 659 3,46 590 3,09 -559 6 -12 -0,75 Rustler S.A.T. Finca A Cortiña/A Coruña 525 ESPH2702717929 81 6,10 19.139 1.248 689 3,59 559 2,92 1537 23 31 0,86 Buckeye S.A.T. Vilar-Alaxe/Lugo Lagos 2782 Blizt ESPH3702460166 79 7,06 16.613 1.239 762 4,58 477 2,87 658 17 1 0,19 Blitz Riberas del Tormes S Coop/Salamanca Aquarelle 6883 ESPH2702956622 77 8,04 16.853 1.239 710 4,21 529 3,13 882 25 27 0,26 Onoz For S.A.T. O Carboeiro/Lugo Penaquente Roy Nela ESPH2702648753 88 8,04 14.885 1.238 761 5,11 477 3,20 238 -1 6 1,83 Roy Esvi, S.C./Lugo 4374 Teis Barrido ESPH2702578324 79 7,09 17.070 1.237 743 4,35 494 2,89 1012 37 24 0,82 Teis Prolesa SAT 1226 Xuga/Lugo Joke 209 ESPH3702601487 78 10,05 14.814 1.230 745 5,02 485 3,27 485 45 37 -1,13 Rettgo Cigarrilla, Sdad. Coop./Salamanca H. Los Tobias Iron Lucia ESPH1402441662 90 8,11 15.597 1.220 716 4,59 504 3,23 -23 30 6 1,43 Iron Huerta Los Tobías/Córdoba Boesegem ESPH2202920186 81 7,08 16.190 1.216 662 4,08 554 3,42 100 52 19 0,97 Okazaki Granja San José S.A./Huesca Facunda Cados ESPH1502579490 77 8,03 12.313 1.212 766 6,22 446 3,62 -447 -19 9 -0,47 Cados Taboada de Casaldoeiro (C.D.)/Coruña Casei 1976 Landoi ESPH2702535575 78 7,09 15.040 1.211 738 4,90 473 3,14 572 14 13 0,26 Landoi S.A.T. Caseiro 991 Xuga/Lugo 76 Frisona Española 212 m/a
Vacas
o más lactación

Mamitis y reproducción

Soy el propietario de una granja de vacas de leche en Galicia, desde hace un tiempo tenemos bastantes problemas de mamitis y de reproducción
¿Podrían estar relacionados estos problemas?
Responde: Luis Quintela Arias* - ANEMBE
La respuesta a la pregunta es, sí. A los numerosos efectos negativos, de sobra conocidos, de las mamitis: pérdida de producción, pérdida de calidad de la leche, eliminación prematura de animales, etc…, debe sumarse un efecto negativo sobre la reproducción: disminución de la fertilidad, incremento del intervalo entre el parto y la gestación e Incremento de perdidas de gestación.
Los estudios a este respecto son relativamente recientes, de ahí que hace algunos años no se mencionara este efecto.
Pero, ¿cómo de importante es este efecto?, ¿cómo se produce? y, lo que es más relevante, ¿qué puedo hacer para disminuir este efecto ne-

Lo primero a mencionar es que se produce, tanto con las mamitis clínicas como con las subclí-

nicas. Para hacernos una idea de su magnitud, en un estudio realizado, precisamente en Galicia, utilizando 1700 lactaciones, se observo un descenso de la fertilidad de algo más del 6% en las vacas que en los días posteriores a la inseminación tenían recuentos de células somáticas superiores a 200.000 (Gráfica 1), lo que supuso, en las vacas con alta producción, un 10% menos de animales preñados en cualquier momento del postparto (gráfica 2). Por ejemplo, a los 150 días tras el parto, en el grupo de vacas con recuentos de células somáticas superiores a 200.000 tras la inseminación, teníamos un 55% de vacas preñadas, mientras que en el grupo de animales con recuentos bajos era
En otros estudios realizados en diferentes lugares, se habla de una reducción de la fertilidad de
Anembe Responde
y Obstetricia. Dpto. de Patología Animal. Facultad de Veterinaria. Lugo
*Reproducción
78 Frisona Española 212 m/a 35 30 25 20 15 10 5 Fertilidad en 1ª IA Células somátics
IA 31,2 24,7 ≤ 200> 200
30 días posteriores a la 1ª
Gráfica 1. Fertilidad en función del recuento de células somáticas en los días posteriores a la inseminación.
100 80 60 40 20 0 050100150 RCS 200 ≤200 >200 Porcentaje de vacas preñadas Días postparto
Gráfica 2. Porcentaje de vacas preñadas en función de los días postparto y del recuento de células somáticas en los días posteriores a la inseminación (RCS), en vacas de alta producción.


Reducción hormonas

Estrés
Reducción calidad y viabilidad embrión

Toxinas bacterianas Medidores inflamación



Alteración función ovario





DISMINUCIÓN DE LA EFICIENCIA REPRODUCTIVA



Tras la entrada de microorganismos a la mama, se produce una inflamación en la misma. Esta inflamación no es más que una reacción defensiva del animal frente a la infección, pero que tiene unos efectos secundarios. Las sustancias que se producen en la inflamación (mediadores de la inflamación), junto a sustancias tóxicas producidas por los microorganismos (Toxinas bacterianas) pasan a la sangre y llegan a diferentes partes del organismo produciendo diferentes efectos: en el cerebro, reducen la pro-
hasta el 14%, en el caso de mamitis subclínicas, y del 24% en clínicas.
Como consecuencia, en una explotación con graves problemas de mamitis (clínicas o subclínicas) la eficiencia reproductiva del rebaño puede verse muy afectada.
¿Cómo se produce este efecto?
La mamitis es un proceso inflamatorio de la glándula mamaria debido, por lo general, a la infección causada por microorganismos patógenos que penetran en la mama a través del canal del pezón.
Como consecuencia, se producen en la mama una serie de sustancias (toxinas bacterianas y mediadores de la inflamación) que pasan a la sangre y afectan a diferentes órganos relacionados con la función reproductiva (hipotálamo, hipófisis, ovarios y útero) provocando una alteración en el normal funcionamiento de los mismos. Por otra parte, toda situación en la que se produce mal estar/dolor, provoca estrés en el animal y el estrés también afecta negativamente a la reproducción (figura 1).
¿Qué podemos hacer?
Realmente la mejor forma de evitar estos problemas es prevenir y, en caso de mamitis clínicas, tratar lo antes posible de forma eficiente. Además, en caso de mamitis clínicas diagnosticadas, sería recomendable, si tenemos que inseminar la vaca
MAMITIS

ducción de hormonas necesarias para el correcto funcionamiento del aparato reproductor; en el útero, reducen la calidad y viabilidad de los embriones y, en el ovario, alteran su normal funcionamiento. Al mismo tiempo, el malestar generado por la inflamación provoca un estrés en el animal que afecta, también, a la producción de hormonas reproductivas. La consecuencia de todo esto es el descenso de la eficiencia reproductiva.
en esos días, retrasar la inseminación unos días hasta la curación o, en todo caso, ser conscientes de que ese celo será menos fértil.
En conclusión, si una vaca tiene mamitis en los días previos o posteriores a la inseminación, la probabilidad de quedar preñada se reduce. Si el problema es de rebaño, la eficiencia reproductiva del mismo se reduce. Como no existen tratamientos para evitar este efecto, lo mejor es prevenir la aparición de mamitis con un buen control periódico de las mismas.











ANEMBE y Frisona Española colaboran en este foro informativo que pretende ser la sección ANEMBE RESPONDE. Aquí tienen cabida las preguntas que normalmente se plantean al veterinario en su actuación cotidiana en el campo.
Aquellos ganaderos interesados en plantear cuestiones, las pueden enviar a la redacción de la revista Frisona Española. Desde aquí se trasmitirán a ANEMBE que las dirigirá a profesionales de prestigio de las diferentes áreas de la clínica y producción bovina y cuyas respuestas se publicarán en estas páginas.

m/a 212 Frisona Española 79
Figura 1. Esquema de cómo las mamitis influyen en la función reproductiva de la vaca.
Buzón Jurídico
Indemnización del despido improcedente: nuevo criterio del Tribunal Supremo
La tan nombrada reforma laboral llevada a cabo en el año 2012, mediante el Real Decreto-Ley 3/2012, de 10 de febrero, de medidas urgentes para la reforma del mercado laboral, publicado en el BOE de 11 de febrero de 2012 y que entró en vigor al día siguiente de su publicación, supuso una reducción de la indemnización prevista para los despidos improcedentes, como todo el mundo conoce.
El artículo 56.1 del Estatuto de los Trabajadores, tras la reforma, establece:
“Cuando el despido sea declarado improcedente, el empresario, en el plazo de cinco días desde la notificación de la sentencia, podrá optar entre la readmisión del trabajador o el abono de una indemnización equivalente a treinta y tres días de salario por año de servicio, prorrateándose por meses los períodos de tiempo inferiores a un año, hasta un máximo de veinticuatro mensualidades. El abono de la indemnización determinará la extinción del contrato de trabajo, que se entenderá producida en la fecha del cese efectivo en el trabajo.»”. Antes de esa reforma, la indemnización prevista para el despido improcedente era de cuarenta y cinco días por año de servicio, prorrateándose por meses los períodos inferiores al año, con el tope de cuarenta y dos mensualidades. Por ello, se ha venido hablando tanto del abaratamiento del despido.
No obstante, la Disposición Transitoria Quinta del citado Real Decreto-Ley 3/2012 dispuso un régimen transitorio en relación a las indemnizaciones por despido improcedente, preceptuando lo siguiente: “
1. La indemnización por despido prevista en el apartado 1 del artículo 56 del Texto Refundido de la Ley del Estatuto de los Trabajadores, aprobado por Real Decreto Legislativo 1/1995, de 24 de marzo, en la redacción dada por el presente real decreto-ley, será de aplicación a los contratos suscritos a partir de la entrada en vigor del mismo.
2. La indemnización por despido improcedente de los contratos formalizados con anterioridad a la entrada en vigor del presente real decreto-ley se calculará a razón de 45 días de salario por año de servicio por el tiempo de prestación de servicios an-
Mª Teresa Jurado Caballero. Letrado de Valenzuela & Bolás Abogados.


terior a dicha fecha de entrada en vigor y a razón de 33 días de salario por año de servicio por el tiempo de prestación de servicios posterior. El importe indemnizatorio resultante no podrá ser superior a 720 días de salario, salvo que del cálculo de la indemnización por el periodo anterior a la entrada en vigor de este real decreto-ley resultase un número de días superior, en cuyo caso se aplicará éste como importe indemnizatorio máximo, sin que dicho importe pueda ser superior a 42 mensualidades, en ningún caso.
3. En el caso de los trabajadores con contrato de fomento de la contratación indefinida, se estará a lo dispuesto en la Disposición transitoria Sexta de este real decreto-ley”.
De manera que para calcular la indemnización por despido en un contrato anterior a la reforma, había que separar dos períodos: (i) calcular la indemnización correspondiente desde el inicio del contrato hasta el 11 de febrero de 2012, a razón de cuarenta y cinco días por años de servicio y (ii) calcular la indemnización correspondiente desde el 12 de febrero de 2012 hasta la fecha de la extinción del contrato, a razón de treinta y tres días por año de servicio. Este extremo estaba claro y no suscitó duda alguna, sin embargo sí han surgido dudas y discrepancias en cuanto a la aplicación de los topes legales a que alude la referida Disposición Transitoria (720 días y 42 mensualidades), habiéndose dictado resoluciones judiciales discrepantes.
Así, en un primer momento, el Tribunal Supremo en Sentencia de 29 de septiembre de 2014 (recurso 3065/2013) consideró que si el día 12 de febrero de 2012 se hubieran superado los 720 días indemnizatorios (aplicando el módulo de 45 días por año) sería posible seguir devengando indemnizaciones (a razón de 33 días por año) hasta alcanzar el módulo de las 42 mensualidades.
Posteriormente, el Alto Tribunal en la Sentencia
80 Frisona Española 212 m/a
de 2 de febrero de 2016 (recurso 1624/2016) ha advertido que el importe indemnizatorio por el período de servicios anterior al 12 de febrero de 2012 no puede ser superior a cuarenta y dos mensualidades en ningún caso, con independencia de que posteriormente se hayan prestado servicios.
A la vista de ello, el repetido Tribunal Supremo en su reciente Sentencia de 18 de febrero de 2016 (recurso de unificación de doctrina 3257/2014), con ánimo de clarificar su doctrina, como expresamente señala en dicha resolución, ha visto la necesidad de precisar el alcance que considera adecuado a la citada Disposición Transitoria Quinta, declarando literalmente en su Fundamento de Derecho Tercero lo siguiente:
La Disposición Transitoria solo se aplica a los supuestos en que el contrato se haya celebrado con anterioridad al 12 de febrero de 2012; la fecha inicial de cómputo, en supuestos (como el presente) de unidad esencial del vínculo es claro que se re-
Cuando, por aplicación de este precepto, se


toman en cuenta períodos de servicio anteriores y posteriores al 12 de febrero de 2012, "el importe indemnizatorio resultante no podrá ser superior a 720 días de salario".
c) De manera excepcional, este tope de 720 días de salario puede obviarse si por el período anterior al 12 de febrero de 2012, ya se ha devengado una cuantía superior.
d) En sentido contrario, la norma implica que si por el período de prestación de servicios anterior a 12 de febrero de 2012 no se ha sobrepasado el tope de 720 días tampoco puede saltarse como consecuencia de la posterior actividad.
e) Si los 720 días indemnizatorios se superan atendiendo a los servicios prestados antes de 12 de febrero de 2012 hay que aplicar un segundo tope: el correspondiente a lo devengado en esa fecha. A su vez, esta cuantía no puede superar las 42 mensualidades.
f) Quienes a 12 de febrero de 2012 no habían alcanzado los 720 días indemnizatorios (con el módulo de 45 días por año) siguen devengando indemnización por el período posterior (con el módulo de 33 días). El referido tope de los 720 días opera para el importe global derivado de ambos períodos.
g) El cálculo de cada uno de los dos períodos es autónomo y se realiza tomando en cuenta los años de servicios "prorrateándose por meses los períodos inferiores a un año" en los dos supuestos”
De esta forma es como el Alto Tribunal ha clarificado ahora su criterio en la aplicación de los repetidos topes legales en el cálculo de la indemnización de despido improcedente, yendo más en línea con la reforma laboral de 2012, que pretendía un menor coste a la hora de despedir a un trabajador.




n Precio: 360 € Información e inscripciones en CONAFE Tfl 94 895 24 12 / 62 / 68 conafe@conafe.com
m/a 212 Frisona Española 81


Temario
Técnicas avanzadas de manejo de la alimentación
Reducción de la excreción de nitrógeno al medioambiente en sistemas lecheros intensivos
Introducción
Uno de los principales problemas medioambientales es la emisión de nitrógeno al ambiente. El nitrógeno es un elemento químico que no puede ser ni producido ni destruido por el metabolismo animal y solo pueden ser transformadas las moléculas que lo contienen (Pfeffer y Hristov, 2005). La mayoría del nitrógeno consumido por los animales es excretado, actuando como nutriente necesario para el crecimiento de las plantas; sin embargo el principal problema durante este ciclo del nitrógeno es que se producen pérdidas elevadas de nitrógeno que contribuyen a la degradación del medioambiente (Rotz, 2004). Las mayores pérdidas de nitrógeno que ocurren en los sistemas intensivos de producción animal se producen mediante las emisiones de gases a la atmósfera (amoniaco, óxido nitroso, y óxido nítrico), y la escorrentía de nitratos a aguas superficiales y subterráneas.
Los rumiantes juegan un papel principal en el suministro de alimentos mediante la conversión de productos fibrosos incomestibles para los humanos en alimentos de alta calidad; sin embargo esta conversión produce inevitables pérdidas de nitrógeno en las heces y orina que pueden producir un alto impacto medioambiental. Así, la contribución de los rumiantes a las emisiones globales de amoniaco es superior al resto de especies de producción. Las pérdidas de nitrógeno pueden ser reducidas mediante la mejora de la eficiencia del animal para usar la proteína alimentaria, disminuyendo las pérdidas durante el almacenamiento y el manejo de las excretas, y haciendo rotación de cultivos para aprovechar mejor el N de las excretas; de esas tres opciones, la primera es la más rápida y fácil de implementar (Rotz y col., 1999).
Fernando Díaz Royón, DVM, PhD
Consumo de nitrógeno
En el ganado de leche no hay ninguna duda de que el consumo total de nitrógeno es el factor más importante que afecta la excreción de nitrógeno en las excretas (heces más orina). En ganado vacuno lechero, el consumo de nitrógeno fue identificado como el principal factor responsable de la excreción de nitrógeno. Así, disminuyendo su contenido en las dietas se puede reducir significativamente la excreción total de este mineral. La dieta no solo puede afectar a la cantidad de nitrógeno excretado por las vacas, sino también la proporción relativa de éste que es excretado en orina o heces. En dietas bajas en proteína, el nitrógeno fecal representa una mayor proporción del nitrógeno consumido (valores máximos del 50%) que el nitrógeno de

Dairy Nutrition and Management Consultant/GPS Dairy Consulting, LLC fernandodiaz@gpsdairy.com - www.gpsdairy.com
84 Frisona Española 212 m/a
a la atmósfera que el nitrógeno excretado en orina, ya que gran parte de este último se encuentra en forma de urea, y la urea puede ser rápidamente hidrolizada a amoniaco por las enzimas ureasas (Satter y col., 2002). Por lo tanto, toda estrategia de alimentación en vacuno lechero debería enfocarse en disminuir las pérdidas de nitrógeno urinario como objetivo prioritario.
Usando datos de 5 estudios llevados a cabo con vacas lecheras, investigadores de la Universidad de Reading (UK, Kebreab y col., 2001) desarrollaron un modelo matemático para predecir la cantidad y la forma del nitrógeno excretado en diferentes sistemas de manejo productivo. Estos autores encontraron que mientras el nitrógeno excretado en leche o heces estaba relacionado positivamente y de forma lineal con el nitrógeno consumido, el nitrógeno excretado en orina estaba relacionado exponencialmente con el consumo de nitrógeno, aumentando el ritmo de excreción de nitrógeno drásticamente cuando el consumo de nitrógeno ronda los 400 g por día. Olmos Colmenero y Broderick (2006) también indicaron que la proporción de nitrógeno consumido excretado en orina incrementó linealmente de 23,8 a 36,2% cuando el contenido de nitrógeno en dietas de vacas lecheras aumentó de 13,5 a 19,4%.
Los estudios comentados anteriormente (Kebreab y col., 2001; Olmos Colmenero y Broderick, 2006) demuestran la importancia de no suministrar proteína por encima de las necesidades del animal. Sin embargo, las formulaciones prácticas de proteína suelen ser superiores a las recomendaciones de los distintos sistemas de racionamiento. Resultados de una encuesta realizada en 372 granjas lecheras localizadas en la Bahía de Chesapeake (EEUU) demostraron que los productores estaban suministrando un 6,6% más de nitrógeno que el recomendado por el National Research Council, y como resultado, la excreción de nitrógeno en orina y heces estaba siendo aumentada en un 16,0 y 2,7%, respectivamente (Jonker y col., 2002).
Degradabilidad de la proteína
En concordancia con lo ya indicado para el consumo de proteína bruta, la proporción de nitró-
gado y excretadas en la orina. La proporción de nitrógeno excretado en la orina de vacas lecheras incrementó linealmente al aumentar la degradabilidad de la proteína de una dieta compuesta de ensilado de hierba y cantidades diferentes de proteína de soja sin tratar o tratada con formaldehído (Castillo y col., 2001). Además, en este estudio, el ritmo de aumento del nitrógeno urinario al incrementar la proporción de PDR fue mucho mayor en dietas con alto contenido en proteína que en dietas bajas en proteína.
Varios experimentos realizados en vacuno de leche han demostrado la posibilidad de reducir las emisiones de amoniaco mediante la disminución del aporte de PDR. Agle y col. (2010) evaluaron el efecto de varios niveles de PDR sobre las emisiones de amoniaco en vacas lecheras suministrando 3 dietas que cumplían los requerimientos en proteína metabolizable; sin embargo, una de ellas excedía los requerimientos de PDR en un 7% siendo las otras dos deficientes en este parámetro en un 14 y 27% para su nivel productivo. El nitrógeno excretado en orina, expresado como porcentaje del N consumido, fue máximo (29,3%) en la dieta con mayor contenido en PDR, mínimo (23,8%) en la dieta con menor contenido de ésta, e intermedio en la dieta con un contenido medio de PDR (26,0%). Sin embargo, la proporción del nitrógeno consumido excretado en heces no fue afectada. Además, los autores evaluaron en laboratorio el potencial de emisión de nitrógeno de las excretas durante 15 días, encontrando que la emisión de amoniaco acumulada durante este periodo fue un 37% inferior en la dieta de menor contenido en PDR que en la de mayor concentración de esta. En concordancia con este experimento, van Duinkerken y col. (2005) reportaron que las emisiones de amoniaco de vacas lecheras alojadas en un sistema de cubículos con ventilación natural se redujeron a la mitad cuando el exceso de RDP en la dieta disminuyó de 1.000 a 0 g/vaca/día.
Implicaciones prácticas
El nitrógeno consumido en exceso de los requerimientos de la vaca es excretado en las heces y orina contribuyendo a la contaminación del medioambiente. La estrategia más efectiva para disminuir las pérdidas de nitrógeno en vacas lecheras en lactación es reducir el consumo de este, especialmente en forma de proteína degradable, sin afectar la producción de leche y/o proteína láctea.

m/a 212 Frisona Española 85
Temario
El tratamiento de la mamitis clínica: cuando el antibiótico no basta
Por muy bueno que sea nuestro plan de prevención de mamitis, es difícil que no exista ningún caso en la ganadería. Sin embargo, cifras por encima del 2-3% de casos nuevos al mes indicarían un problema de mamitis clínica. En cualquier caso, cuando el plan falla debemos tratar.
Las mastitis clínicas son la mayor razón para el uso de antibióticos en vacas de leche y también es la primera causa de residuos antibióticos en el tan-

dera que un caso clínico se ha curado cuando no existe leche alterada durante al menos 3 días consecutivos. Se dice que un caso es recurrente (y por lo tanto, no se ha curado) cuando los síntomas vuelven en menos de 3 semanas.
Decidir si se trata o no un caso de mamitis va a depender del valor de la vaca: edad, estado de lactación, producción… así como de los costes y beneficios de los tratamientos, valor de la leche eliminada, probabilidad de curación, valor del animal en matadero, riesgo de residuos, trabajo de poner los tratamientos.
El objetivo de los tratamientos es el retorno lo antes posible a su nivel de producción y con una composición normal, evitar la mortalidad en casos hiperagudos, eliminación de las bacterias y la no presencia de residuos.
Los principios del tratamiento de la mamitis clínica
Se incluyen los siguientes:
1. La detección temprana
Es muy importante examinar la leche antes de poner las pezoneras para detectar sobre todo los casos leves y moderados. Cuanto más se tarde en tratar, más posibilidades tiene la bacteria de invadir tejido secretor y de ser entonces más difícil de curar. En un estudio realizado sobre 225 casos, las vacas que ya tenían un recuento celular elevado antes del caso clínico tardaron en curarse 9,5 días frente a los 7 de las que tenían recuento bajo.
2. ¿Se deben tratar todos los casos?
Uso juicioso de antibióticos
Como ya hemos explicado en artículos anteriores, se define la mamitis clínica cuando existe alteración de la leche y/o alteración del cuarterón (inflamación, enrojecimiento). En función de la gravedad del caso se clasifican en leves, moderadas o hiperagudas. Después del tratamiento, se consi-
María Martín Richard. ASPROLAC maria@asprolac.com
Sobre este aspecto existen estudios para todos los gustos. En primer lugar, hay que identificar si las bacterias que ocasionan mamitis en la explotación pueden ser curadas puesto que gérmenes tipo micoplasmas o nocardias no tienen tratamiento.
Pero en caso de bacterias potencialmente curables, se debe verificar la gravedad y la necesidad de tratar únicamente vía intramamaria o por otras vías.
Existen varios estudios sobre el interés de no tratar con antibióticos. En uno de ellos, se vio que en caso de mamitis clínicas causadas por estreptococos o coliformes no había en principio diferencia en curación entre el grupo de animales tratados y del no tratado con antibiótico (solo con oxitocina y or-
86 Frisona Española 212 m/a
deño). Sin embargo, y aunque se vio que el retorno a la producción normal y la supervivencia era similar, sí que existían más casos de vacas recurrentes en el grupo de no tratadas.
En otro estudio, en el caso de no tratar mamitis por estreptococos se vio un aumento de los recuentos celulares.
Para ver el éxito de un tratamiento se debe valorar el recuento celular y los casos que recurren (vuelven a tener mamitis clínica en menos de 3 semanas).
3. ¿Se debe tratar hasta que la leche tenga aspecto normal?
En especial con casos de mastitis coliformes, el cuarterón puede dejar de dar prácticamente leche y que esta sea tipo acuoso. Esta situación no suele mejorar por mucho antibiótico que se utilice. En alguna ocasión, el cuarterón vuelve a producir de forma normal en la siguiente lactación.
En general, si los días de tratamiento superan los 5 de media en una explotación, se debería revisar el protocolo de tratamiento porque algo está fallando.
Cuando la vaca se cura por sí misma sin ningún tratamiento, se llama curación espontánea. Esto ocurre entre el 20 y 30% de los casos, normalmente
Las razones para que fallen los tratamientos son varias: que la bacteria no entre en contacto con el antibiótico (porque haya inflamación o que la bacteria se “esconda” en glóbulos blancos), que el antibiótico no difunda bien en la ubre; que la bacteria desarrolle formas de resistencia como L-bacterias; resistencia a los antibióticos; tratamientos incorrectos (por ejemplo que no duren lo suficiente).
Para que el tratamiento antibiótico sea efectivo, es necesario que llegue al sitio de la infección superando la concentración mínima inhibitoria y que permanezca un tiempo mínimo para permitir que el agente muera o al menos no crezca.
Etiología
Para conocer la causa de la mamitis, se pueden tomar muestras de todos los casos para su identificación (poner nombre a la bacteria). Esto, junto con el antibiograma, nos da una idea del tratamiento a seguir así como de las medidas que pueden evitar esas bacterias en la ganadería.
Con los métodos actuales de cultivo, aproximadamente un 30% de los casos remitidos al laboratorio van a ser sin crecimiento, es decir no se puede identificar porque no ha crecido nada. Estas cifras pueden mejorar realizando un pcr que es una técnica más sensible pero también más cara. Tiene

El tratamiento de la mamitis clínica...

crementar la leche que se puede comercializar por no llevar residuos antibióticos.
Otros tratamientos a tener en cuenta
•Utilización de oxitocina y ordeño frecuente: no se ha demostrado beneficioso en todos los casos. Cuidado con la utilización de tratamientos fuera de la vía recomendada de utilización. La mayoría de los tratamientos recomendados para vía sistémica (ej intramuscular) tienen poca difusión en la ubre cuando se utilizan por vía intramamaria además de no conocerse el período de retirada necesario.
•El uso de antiinflamatorios es recomendable siempre que exista inflamación y favorecer así la distribución del antibiótico dentro de la ubre.
tienen un resultado positivo frente a los tratamientos antibióticos (ej, Micoplasma, Nocardia).
Además para establecer un tratamiento, se debe conocer si el caso puede ser clasificado como leve (sólo se ve afectada la leche con la presencia de “cuajarones”), moderado (leche alterada + inflamación de la ubre) o grave (lo anterior + alteración del estado general por ej con fiebre). Solo un 15% de los casos pertenecen a este grupo. Algunas bacterias como E coli son asociadas más frecuentemente a casos graves.
Se pueden tratar todos los casos clínicos que aparezcan en una ganadería sin conocer la causa que los provoca. Sin embargo, se ha visto que puede suponer un tratamiento excesivo en un 5075% de los casos. Lo ideal sería poder tomar una muestra de cada caso clínico y tratar en función de lo que diera en laboratorio. Como esto no es viable ni económicamente ni por funcionamiento, en las explotaciones grandes se puede recomendar, al menos, tener un pequeño laboratorio con medios simples que permita la identificación de los grupos de bacterias (ver si existe crecimiento y si pertenece a Gram positivos o negativos). Requiere poca expemientos. Se puede establecer entonces qué animales tratar (solo los que tengan crecimiento; solo los que sean Gram positivos) y valorar los resultados. Existen estudios en los que se ahorra hasta un 60% de los tratamientos antibióticos además de in-

•Terapia para casos hiperagudos: son generalmente producidos por bacterias coliformes. La terapia debe ir enfocada a eliminar las toxinas que provocan la alteración del estado general. Se deben administrar soluciones hipertónicas y agua en grandes cantidades además de antiinflamatorios.
•Se ha relacionado el uso de ciertas vitaminas (vitaminas A y E) y minerales (Selenio y Zinc) con la estimulación de las defensas y por lo tanto frente a bacterias que provocan mamitis. Esto no quiere decir que por suplementar en exceso con estos micronutrientes, se va a conseguir eliminar las infecciones, pero tenemos que confirmar que el aporte es suficiente y que no existen deficiencias.
Se describen estudios en los que suplementando tanto en el secado como en producción se aprecian menores recuentos celulares y menos casos de infección. Por eso se debe estar precavido en zonas donde puedan existir deficiencias.
Protocolos de tratamientos
Se debe trabajar con el veterinario para establecer los tratamientos en función de los síntomas y evaluar los resultados. Debemos evitar la presencia de residuos y no olvidar leer los prospectos. No solo los antibióticos tienen tiempo de supresión. Cuando se utilizan varios productos, los tiempos de supresión pueden variar por lo que es necesario realizar algún test apropiado antes de meter la leche en el tanque.
En los tratamientos locales, en primer lugar se debe realizar en cuarterones limpios y secos. Se debe usar una toallita o algodón impregnado en alcohol 70% o en solución desinfectante. Si no se realiza una buena desinfección, se pueden introducir bacterias que estén en la piel del pezón y provocar una nueva infección.
Si se tratan más de un pecho, se debe limpiar empezando por el más alejado de nosotros y tratar empezando por el más próximo a nosotros. Cuidado al introducir la cánula para no dañar el interior del conducto. Posteriormente, se debe usar un baño de pezones desinfectante.
Hay que llevar apuntes de los tratamientos utilizados así como de las fechas y valorar los resultados para determinar si son necesarios cambios.
88 Frisona Española 212 m/a
Toma de muestra
Placa con 3 medios de cultivo
VMS™ Spectra edición limitada
El único robot de ordeño que puntúa diariamente la condición corporal de la vaca




Con la puntuación precisa y diaria de la condición corporal puedes planificar la alimentación para asegurar la adecuada reserva de grasa en el ciclo de lactación de la vaca. Esto promueve la producción de leche, la eficiencia reproductiva y la longevidad de la vaca y está disponible de serie en el VMS Spectra.
Para saber más sobre la edición limitada del VMS Spectra contacta con tu distribuidor local o mira nuestra página web www.delaval.es . DeLaval VMS™ – mucho más que un robot de ordeño. Disponible solamente en 2016.

VMS+
www.delaval.es
Temario
Retención de placenta
En la naturaleza existen dos formas básicas de reproducción: la asexual que da lugar a individuos idénticos y la sexual, en la que la unión de los gametos masculino y femenino da lugar a un huevo, también llamado cigoto, del que nacerá un individuo distinto de los padres. Gracias a la reproducción sexual tuvo lugar la evolución. El huevo se puede formar fuera de la madre, por fecundación externa, obligatoriamente en el agua, como sucede en los anfibios y peces óseos. O bien se puede formar por fecundación interna, cuando el padre pone los espermatozoides dentro de la madre. En estos últimos, una vez formado el huevo este puede ser recubierto por una cáscara dura que protege al embrión y ser incubado fuera de la madre como sucede en algunos peces y reptiles, las aves y los mamíferos monotremas: el equidna y el ornitorrinco, además de muchos invertebrados, que son los denominados animales ovíparos.
Pero el huevo también puede incubarse y desarrollarse dentro de la madre hasta que completa su desarrollo, como sucede en muchos tiburones y otros peces, en algunos reptiles y en diversos animales invertebrados. En todos ellos, la eclosión puede darse inmediatamente después de la puesta, siendo el caso de los ovovivíparos, o justo antes del parto, de los vivíparos. Vivíparos son algunos tiburones, peces, serpientes y anfibios urodelos. También lo son los mamíferos marsupiales en los que de un huevo con bastante vitelo nace el embrión que se arrastra hasta la bolsa del marsupio, donde termina de desarrollarse mamando.
Los huevos de los animales descritos anteriormente tienen una cáscara que los protege y, dentro una membrana alantoidea y una amniótica (las membranas que están debajo de la cáscara), la clara, una membrana vitelina y la yema. Todas estas estructuras sirven para que el embrión respire, se alimente y acumule las sustancias de desecho. Y finalmente, tenemos el blastodermo o disco germinal del que se desarrollará propiamente el nuevo individuo. Estos huevos contienen todo lo necesario para el desarrollo necesitando del exterior tan sólo oxígeno y calor.
Pero en los mamíferos más evolucionados, los placentarios, las madres desarrollaron el útero. El alantoides del huevo se une a éste formando la placenta. El alantoides y el corion fusionados forman la membrana corio-alantoidea, rica en vasos sanguí-
Juan Vicente González Martín. DVM, PhD, Dipl. ECBHM Profesor Titular Dpto. de Medicina y Cirugía Animal, Facultad de Veterinaria, UCM
TRIALVET Asesoría e Investigación Veterinaria SL (Web: www.trialvet.com/ E-mail: trialvet@trialvet.com)
neos, que es la parte fetal de la placenta y la cual contacta con la porción materna o decidua basal. Existen distintos tipos de placenta dependiendo de cómo se unan la parte fetal y la materna. La placenta de la vaca es del llamado tipo epiteliocorial, donde el epitelio de la mucosa uterina sigue intacta y las membranas fetales contactan con el tejido uterino, permitiendo el paso de los nutrientes necesarios. Esta placentación se produce en unas zonas concretas del útero denominadas carúnculas, de forma oval con criptas en su superficie; a ellas se unen las partes correspondientes de la membrana corio-alantoidea, denominadas cotiledones, al desarrollar vellosidades que se introducen en las criptas carunculares, y ambas juntas forman los placentomas. En el útero de la vaca hay entre 75 y 125 placentomas.
Por lo que se ha visto anteriormente, la membrana corio-alantoidea, parte fetal de la placenta como el propio feto, derivan del huevo o cigoto, que tiene la mitad de sus genes del padre y por ello, son diferentes de la madre, inmunológicamente diferentes. Sin embargo, durante la gestación no se produce el rechazo de la placenta porque el sistema inmune está inhibido a ese nivel para permitir dicho proceso. Cuando se produce el parto, tras la segunda fase en la que se expulsa el feto, viene la tercera y última fase del parto en la que, en el plazo de unas tres a ocho horas, la placenta o mejor dicho la parte fetal de la misma, es también expulsada.
¿Y cómo se produce esa expulsión de la placenta?
Durante la tercera fase del parto hay una pérdida importante de las vellosidades de los cotiledones en las carúnculas y los placentomas se expanden lateralmente. Se reduce la circulación fetal a los cotiledones, los capilares dentro de las vellosidades colapsan, lo que lleva a una disminución de su tamaño. El útero se contrae y las criptas de las carúnculas se encogen, lo que separa más los cotiledones de carúnculas. Normalmente las membranas fetales con los cotiledones se desprenden dentro de seis horas después del parto. En la vaca no hay pérdida significativa de tejido materno, por lo que la placentación se considera no decidua. Pero para que la placenta sea expulsada, primero debe desprenderse de los cotiledones.
Durante mucho tiempo no se supo cómo se producía ese desprendimiento. No era por falta de contracciones uterinas o abdominales, pues vacas con la placenta retenida podían tener contracciones y pese a ello la placenta no se expulsaba. Incluso vacas con la matriz prolapsada podían presentar la placenta fuertemente adherida, tanto
90 Frisona Española 212 m/a
que incluso utilizando las dos manos no éramos capaces de desprenderla. Hace tan sólo un par de décadas, en 1984, Gunnink sugirió que la placenta se desprendía cuando ésta era “atacada” por los glóbulos blancos de la madre y probablemente también del feto, en concreto los neutrófilos, los cuales destruían la unión cómo si de cualquier tipo de bacteria o de cuerpo extraño se tratase. Esta acción se va preparando por efecto de las distintas hormonas que van apareciendo en todo el proceso del parto.
¿Y por qué se retiene la placenta?
Si los neutrófilos fallan, se produce la retención. Las vacas con retención tienen elevado el cortisol y disminuido el estradiol al final del embarazo. También se altera el ratio de prostaglandinas PGE2/ PGF2α, elevándose esta última, por lo que las contracciones uterinas están aumentadas en las vacas con retención.
Son muchas las causas conocidas que incrementan el porcentaje de retención como por ejemplo: aborto de más de cinco meses de gestación, mortinatos, parto gemelar, parto prematuro, distocia, cesárea, inducción del parto con prostaglandina F2α o con dexametasona, niveles bajos de selenio o vitamina E, enfermedades metabólicas como cetosis o hipocalcemia, endogamia, elevado número de partos y estrés previo al parto que eleva el cortisol. Todas estas causas conocidas que aumentan la retención de placenta están ligadas al buen funcionamiento del sistema inmune a dos niveles principales: uno a nivel de las moléculas del complejo mayor de histocompatibilidad de clase I, que al aparecer en la placenta durante el parto
ción incorrecta provocará inmunosupresión y con ella, retención de placenta. Y si la inmunosupresión persiste después del parto, además de retención tendremos metritis e incluso se producirá la muerte de la vaca.
¿Cuál sería el porcentaje normal de retención de placenta en una granja?
Para contestar a esta pregunta, lo primero que hay que definir es a partir de cuántas horas consideramos que hay retención. A efectos prácticos solemos utilizar 24 horas posparto y porcentajes de retención del orden del 5 al 15%. Si bajamos a 6 horas posparto el porcentaje se dobla y en novillas de primer parto el porcentaje es la mitad que en vacas multíparas. En condiciones óptimas, podremos situarnos alrededor del 5%, pero con estrés del tipo que sea, por ejemplo estrés por calor, o con alimentaciones inadecuadas llegaremos fácilmente al 40%.
¿Cuál es el coste aproximado de un caso de retención de placenta?
No es una pregunta fácil de contestar ya que depende mucho de cada vaca. Todos hemos tenido vacas que no nos percatamos de que se quedó con la placenta, arrancó bien y un día la echó sin más consecuencias. Y por otro lado está la vaca que como hemos dicho se queda con la placenta y luego desarrolla metritis, desplazamiento de abomaso, mamitis y finalmente muere. La retención de placenta disminuye la producción de leche, retrasa los días a la preñez, aumenta el porcentaje de mamitis e incrementa el riesgo de que sea eliminada de la granja.

Una vez nacido el ternero en la segunda fase del parto, se expulsará la placenta en la tercera 212 m/a Frisona Española 91
Retención de placenta
El tratamiento de la retención de placenta, otro tema candente
Se han probado muchas formas de tratar la retención, mecánicas cómo la extracción manual o colgar peso de la placenta que cuelga; tratamientos intrauterinos cómo la aplicación de bolos o infusiones antibióticas; desinfectantes, azúcar u ozono; la aplicación de tratamientos parenterales como oxitocina, prostaglandina F2α, calcio, selenio, vitamina E; o incluso orales como el caso de la administración de calcio oral.
Desde luego, la extracción manual está completamente desaconsejada, como mucho cortaremos con higiene la parte de la placenta que cuelgue hacia el exterior de la vulva para que esta no esté continuamente entrando y saliendo y con ello contaminando más el útero. En lo que a los tratamientos intrauterinos y parenterales se refiere, ninguno está completamente avalado por la literatura científica. De todos los tratamientos podemos encontrar casi el mismo número de artículos científicos que demuestran su efecto positivo como los que demuestran que no hacen nada o incluso que empeoran los índices reproductivos. En lo que sí parece estar todo el mundo de acuerdo es en que se vigile estrechamente a esas vacas y si presentan signos generales de enfermedad, como puede ser fiebre,

les con retención que presentan complicaciones como cetosis, desplazamiento de abomaso o mastitis, por lo que las vacas con retención deben ser completamente exploradas para detectar esas enfermedades y ser rápida y completamente tratadas frente a todos los problemas que se detecten. La placenta retenida, independientemente del tratamiento aplicado, puede tardar en expulsarse hasta 12 días.
Prevención
Puesto que el coste de la enfermedad es muy alto, las complicaciones muchas y no disponemos de un tratamiento que solucione rápidamente el problema, todos nuestros esfuerzos deben estar enfocados en la prevención. El objetivo sería tener un porcentaje de retenciones de más o menos el 5%, ya que bajar de esa cifra sería casi imposible.
En lo que a las causas relacionadas con el parto, quizá la más efectiva sea la utilización de toros con facilidad de parto para evitar las distocias y todos los problemas que acarrean. La inducción del parto con prostaglandinas o corticoides para evitar la distocia no es una solución pues como hemos visto estos tratamientos aumentan mucho el riesgo de retención de placenta. Los problemas relacionados con el parto, la inducción de este, los abortos, mortinatos y partos gemelares tienen un porcentaje de retención del orden del 80%.
En lo que a la alimentación se refiere, la retención estaría relacionada con el fallo del sistema inmune. La deficiencia de selenio, de vitamina E, la hipoglucemia, los niveles altos de ácidos grasos no esterificados (NEFAS), de cuerpos cetónicos como el β hidroxibutirato (BHB) o la hipocalcemia producen distintos grados de inmunodepresión y por ello impiden el correcto funcionamiento de los neutrófilos, dando lugar a la retención de placenta. Con el agravante de que todos estos problemas metabólicos y nutricionales se suelen extender al posparto dando lugar a metritis, que como hemos dicho, pueden llegar a ser mortales. Por lo tanto una correcta alimentación que evite engordar a las vacas secas y prevenga la hipocalcemia es muy importante. La aplicación de vitamina E o selenio inyectable, si los niveles aportados por la ración son correctos, no nos aportará ningún beneficio. Pero si hubiera deficiencias, sí deberemos hacerlo.
Y finalmente queda el problema del estrés. El estrés da lugar a un aumento del cortisol y éste es inmunosupresor. Los problemas nutricionales y metabólicos también elevan el cortisol. Cualquier alteración en la rutina diaria de una vaca en el preparto y las primeras horas del posparto incrementará el porcentaje de retenciones de placenta. Entre estos factores estresantes se encuentran, no sólo el cambio de corral como por ejemplo pasar la vaca a un corral de preparto pocos días antes del parto, pasarla a una paridera o a una enfermería; sino también introducir animales nuevos en el corral en el que está, o reducir el espacio de éste aumentando la densidad de animales. El estrés nutricional o hídrico también deben ser tenidos en cuenta, así como el estrés por calor.
En fin, trabajar en mejorar el bienestar animal, una vez más, es la mejor recomendación que podemos hacer…
En caso de fallar la expulsión, la placenta puede ser retenida hasta 12 días después del parto
92 Frisona Española 212 m/a

Monobox – Unidad de ordeño robotizada GEA Farm Technologies
¡Nuestra fórmula funciona!
El nuevo concepto de ordeño robotizado de una sola cabina incorpora los más avanzados sistemas de ordeño automático ideal para explotaciones
El único sistema robotizado con sellado automático en la pezonera.
GEA Farm Technologies Ibérica S.L.
Avda. Sant Julià 147, 08403 Granollers, España
Telefono: +34 938 617 120, e-mail: agricola@gea com / www.gea.com
engineering for a better world

Farm Technologies
GEA
Temario Uso de cama acumulada de compost en vaca de leche (II)
Introducción
En el número nº 210 abordábamos la primera parte de este trabajo, referido al uso de cama acumulada de compost como una alternativa de alojamiento a los tradicionales de cama de paja o de otro material y al sistema de cubículos. En esa priducir el coste inicial del establo (Wagner, 2002), a la vez que, potencialmente, reducir el riesgo de mamitis asociada a las camas convencionales, sobre todo de paja1.


En esta segunda entrega veremos cuáles son los criterios fundamentales a la hora de diseñar y dimensionar un alojamiento con este tipo de cama y cuál es su coste, comparándolo con el de otros sistemas más conocidos.
Para evitar confusiones, queremos recordar que la denominada “cama caliente” es diferente del sistema de compostaje. Aquél es el sistema habitual sin cubículos y en el que el material orgánico empleado como absorbente (lo más habitual es paja de cereales, pero se pueden utilizar otros) es añadido diariamente para mantener la cama seca (Figura 1). La temperatura que puede alcanzar (15-45 ºC) y las condiciones de anaerobiosis son ideales para el crecimiento de microorganismos patógenos.
Por el contrario, en el compostaje de la cama, la aireación frecuente (2 veces/día) de la capa más superficial (20-30 cm) contribuye a disipar el calor generado en el proceso y a introducir el oxígeno necesario en dicho proceso. El material se introduce periódicamente, entre 1 y 5 semanas, dependiendo de la estación del año, el nivel de humedad y la limpieza de los animales. Cuando se empieza a observar suciedad en ellos suele ser un buen indicador de la necesidad de aportar cama en la zona de reposo.
También cabe la posibilidad del uso de compost como cama para las vacas, ya elaborado y maduro y adquirido en una planta de compostaje, y el cual se va incorporando periódicamente a la zona de reposo (Figura 2). Requiere mayor disponibilidad de superficie por animal.
Criterios de dimensionamiento Densidad
La densidad óptima de ocupación depende de la cantidad de deyecciones, sólidas y líquidas, depositadas en la cama. Más humedad requiere mayor superficie por vaca o más material que absorba esa humedad. Basándose en la producción
1 En nuestra opinión, el tipo de alojamiento per se no es la causa principal de una mayor incidencia de mamitis, sino un mal diseño, dimensionamiento o manejo del mismo.
Antonio Callejo Ramos. Dr. Ingeniero Agrónomo Dpto. de Producción Agraria-E.T.S.I.A.A.B.-UPM antonio.callejo@upm.es
Figura 2. Establo con cama de compost comprado y sin pasillo de alimentación (cortesía de Kammel)
Figura 1. Sistema de alojamiento con “cama caliente”, con uso de paja (cortesía de Kammel)
94 Frisona Española 212 m/a
de heces y orina de una vaca, Janni y col. (2007) recomendaban 7,5 m2/vaca para animales Holstein de 540 kg o 6 m2/vaca para vacas Jersey de 410 kg2. Las granjas israelíes no añaden material de cama durante el proceso por lo que, para compensar la menor capacidad de retención de agua, recomiendan un mínimo de 15 m2/vaca cuando el pasillo de alimentación, hormigonado, se limpia con arrobadera, y entre 20-30 m2/vaca cuando el compost también cubre el pasillo de alimentación (por tanto, éste no está hormigonado).
Téngase en cuenta que las condiciones climatológicas de Israel (Figura 3) provocan una gran evaporación y no suele ser necesario aportar material que vaya absorbiendo una creciente humedad como sucede en zonas o épocas frías.
En cualquier caso, como mínimo, todas las vacas deben poder estar tumbadas a la vez y aún dejar espacio para que algunas puedan desplazarse al comedero o al bebedero.
Diseño
Las naves donde se va a utilizar cama compostada (compostaje in situ) requieren un diseño y orientación adecuadas y un excelente manejo en lo que se refiere a proporcionar una adecuada ventilación y una superficie seca sobre la que las vacas van a tumbarse. Su diseño no va a diferenciarse mucho de una “cama caliente” convencional, con paja como material absorbente; tendrá un pasillo de alimentación, generalmente de hormigón y limpiado mediante pala arrobadera, y una zona de reposo con cama en compostaje. La diferencia fundamental es que esta zona de reposo se separa del pasillo de alimentación mediante un muro que suele tener 1,20 m de altura, accediéndose a dicho pasillo a través de únicamente dos o tres zonas abiertas en el muro. Su misión será la de sujetar la cama que, según va compostándose y añadiéndose material absorbente, va ganando altura, de forma que impida que esta cama se derrame sobre el pasillo de alimentación. Debe también considerarse la instalación de una barrera protectora sobre este muro para evitar accidentes cuando la acumulación de cama llegue o esté próxima a su altura máxima (Figura 4).
Puede ser necesaria una altura de 1,8 m si el establo se limpia sólo una vez al año. Algunos técnicos sugieren que la base de la zona de reposo esté 60 cm por debajo del nivel del pasillo de alimentación, empezar el proceso de compostaje con una cama de 60 cm de espesor y así sólo acumular otros 60 cm por encima del nivel de dicho pasillo.
Este muro de contención de la cama también puede configurarse con bloques prefabricados de hormigón (Figura 5).
Debido a esta acumulación de la cama, y para garantizar un volumen estático suficiente y no dificultar el paso de la maquinaria, estas naves deben tener suficiente altura en las fachadas, del orden de 4,5-5 m, y de 1 a 3 cm de abertura en la cumbrera por cada metro de anchura de nave. Esta cumbrera debe estar protegida con un caballete para evitar la entrada de agua en los días de lluvia que humedezca la cama, o bien disponer un faldón de la cubierta sobrepuesto al otro (ver Frisona Española, nº 197, pág. 110, figura 7). Los faldones sobre-



2 A nosotros nos parece una superficie insuficiente, máxime cuando el peso de las vacas Holstein que manejamos actualmente es muy superior al indicado. Pensamos que la superficie mínima debería ser de 10 m2/vaca.
puestos en la cumbrera pueden limitar la salida del aire caliente si la parte abierta está orientada hacia la dirección de donde proceden los vientos dominantes.
Puesto que en el proceso de compostaje se debe eliminar un gran cantidad de humedad, es preciso garantizar la ventilación, con necesidades superiores a las de otro sistema de alojamiento, y para eliminar rápidamente el polvo que se origina en el proceso de aireación de la cama, dos veces
Figura 3. Las granjas de Israel requieren mucha menos cantidad de aporte de cama (Galama y col., 2011)
Figura 4. Muro de contención de la cama con valla protectora (cortesía de Kammel)
Figura 5. Bloques prefabricados de hormigón para contener la cama acumulada (cortesía de Kammel)
m/a 212 Frisona Española 95
96
Uso de cama acumulada de compost en vaca de leche (II)
por día. Ventiladores dispuestos al efecto se observan en la Figura 4 y en la Figura 6.
Los bebederos deben situarse en el pasillo de alimentación y a ellos las vacas sólo deben acceder


Ejemplo de dimensionamiento:
Consideremos que un ganadero planea construir un establo para 60 animales con este tipo de zona de reposo. Esta zona tendría 10 m de ancho. Si consideramos una superficie por vaca de 10 m2,
•el área de reposo debería tener una superficie de 60 vacas x 10 m2/vaca = 600 m2.
•Longitud del establo: 600 m2/10 m = 60 m
•Dimensiones de la zona de reposo: 60m x 10m. A esta anchura deberíamos añadirle 4,5 m del pasillo de alimentación (al colocar los bebederos en este pasillo, recomendaríamos 5 m de anchura para una cómoda circulación de los animales y buen acceso al comedero), más otros 5 metros de anchura del pasillo de distribución, para una cómoda circulación del remolque distribuidor de la ración. El establo tendría, por tanto, unas dimensiones de 60m x 20m = 1.200 m2.
La tabla 1 muestra las necesidades de espacio para alojar 80 vacas en cinco tipos diferentes de alojamiento.
Costes del sistema
Coste de construcción
Cuando se construye una nueva nave para alojar a las vacas el coste de la misma es uno de las principales inversiones de la granja, además de la sala de ordeño. El alojamiento en cama de compost tiene menor coste inicial que el de cubículos por el menor empleo de hormigón en el suelo, la ausencia de separadores de los cubículos y la ausencia o menor necesidad de arrobaderas para la limpieza de los pasillos; sólo existe, y no siempre, el pasillo de alimentación, de acceso al comedero, si bien puede ocurrir que la normativa ambiental exigiera una base de hormigón bajo la cama para evitar filtraciones de nutrientes (N, P, K) al suelo.
No obstante, la mayor superficie por vaca necesaria requiere una estructura de mayores dimensiones.
Black y col. (2013), en un estudio realizado en 47 granjas de Kentucky (EE.UU.), calcularon un coste de 79±29 USD3/m2 con pasillo de alimentación hormigonado, y de 49±21 USD/m2 sin este pasillo. En estas naves no hubo que hormigonar el suelo bajo la cama.
Asumiendo una superficie de 9,3 m2/vaca, el coste de estas naves fue de 1.051± 407 USD/vaca con pasillo hormigonado y de 493±196 USD/vaca sin dicho pasillo.
Horner y col (2007) elaboraron distintos modelos de alojamientos representando 29 situaciones diferentes, con variaciones en el número de vacas, el sistema de ventilación, el tipo de cama y el sistema de manejo de deyecciones. En su estudio estimaron que el alojamiento de cama compostada tenía un
3 USD. Dólares USA

1 La longitud original (en pies) se ha redondeado considerando distancia entre pórticos de 5 m
2 Considerando 61 cm/vaca de comedero,
3 Considerando la anchura de una nave de
de superficie de reposo
m2/vaca de superficie de reposo.
Figura 6. Ventilación con ventiladores de baja velocidad y elevado caudal
Figura 7. El acceso al bebedero debe hacerse únicamente desde el pasillo de alimentación (cortesía de Kammel)
Tipo de alojamiento Dimensiones de la nave (m x m)1 Superficie total (m2) Espacio de comedero (cm/vaca) Superficie (m2/vaca) 81 cubículos en 3 filas 45 x 16 720 55,5 8,9 80 cubículos en 2 filas (cola-cola) 55 x 13,5 742,5 69 9,3 80 cubículos en 2 filas (cabeza-cabeza) 65 x 13 845 81 10,5 Cama de compost2 50 x 20 1.000 62,5 12,5 Cama de compost3 65 x 16 1.040 81,25 13,0
Tabla 1. Comparativa de la superficie total necesaria en 5 tipos de alojamientos
y 9,3 m2/vaca
cubículos
3 filas de
y 9,3
98)
Frisona Española 212 m/a (pasa pág.
Estoy mas que seguro
¡Estoy agroseguro!
Las enfermedades, los accidentes... Son muchos los riesgos a los que está expuesta una explotación ganadera. Riesgos que pueden arruinar tu negocio de la noche a la mañana. Por eso cuando me preguntan si estoy seguro, yo siempre respondo... ¡Estoy AGROSEGURO!

Incluye como garantía adicional el saneamiento ganadero


El seguro de los que están más seguros
PARA SUSCRIBIR SU SEGURO DIRÍJASE A: MAPFRE ESPAÑA, CÍA. DE SEGUROS Y REASEGUROS • AGROPELAYO SOCIEDAD DE SEGUROS S.A. • SEGUROS GENERALES RURAL • CAJA DE SEGUROS REUNIDOS (CASER) • PLUS ULTRA SEGUROS • ALLIANZ, COMPAÑIA DE SEGUROS
• UNIÓN DEL DUERO, CÍA. DE SEGUROS • MUTUALIDAD ARROCERA DE SEGUROS • CASER MEDITERRÁNEO SEGUROS GENERALES • HELVETIA CÍA. SUIZA S.A. DE SEGUROS• BBVASEGUROS, S.A., DE SEGUROS • GENERALI DE ESPAÑA, S.A. SEGUROS • CAJAMAR SEGUROS GENERALES S.A. • AXA SEGUROS GENERALES • SEGUROS CATALANA OCCIDENTE • ASEFA, S.A. SEGUROS • FIATC, MUTUA DE SEGUROS Y REASEGUROS • REALE SEGUROS GENERALES • MGS SEGUROS Y REASEGUROS S.A. • AGROMUTUA-MAVDA,
SDAD. MUTUA DE SEG. • MUSSAP, MUTUA DE SEGUROS • PELAYO, MUTUA DE SEGUROS A PRIMA FIJA • SANTA LUCÍA, S.A. CÍA DE SEGUROS
con
Consulte
su mediador de seguros
Uso de cama acumulada de compost en vaca de leche (II)
Tabla 2. Comparativa de costes de dos

coste por vaca (900 USD) del 46% respecto al de otro con cubículos con cama de colchoneta (1.950 USD) y del 50% respecto a cubículos con cama de arena (1.800 USD).
Como hemos comentado, un alojamiento con cama compostada requiere de menos gasto en hormigón y otras instalaciones que otro con cubículos, pero debe ser más grande por la mayor superficie necesaria, por lo que puede que el coste inicial no sea, a priori, más ventajoso para el primer sistema citado.
De las cifras expuestas en la tabla 1 se deduce que un establo de cama compostada requiere entre un 40 y un 55% más de superficie que otro con
3 filas de cubículos. Por tanto, únicamente considerando los costes de inversión, debería determinarse si el ahorro en hormigón, en separadores y en arrobaderas para limpieza de pasillos podría compensar el coste extra de esta mayor superficie necesaria.
La tabla 2 muestra los costes de un alojamiento para 150 vacas con cama de compost ya curado adquirido en una planta de compostaje y otro con cama en compostaje continuo in situ (viruta de madera y aireación) frente a un sistema de cubículos. Los alojamientos con cama de compost, en sus dos versiones, tienen menores costes de inversión en infraestructura debido a la ausencia de fosa de puri-

nes, aunque sí se requiere una instalación exterior para almacenar el compost que se re-

Cubículos Compost Compostaje in situ Nº de vacas 150 150 150 Área de reposo (m2/vaca 3 15 8 Material de cama Compost Viruta de madera Acumulación de cama en un año (m) 0,5 1 Precio de material de cama (€/m3) 10 5 Longitud del establo (m) 48 49 49 Anchura del establo (m) 29 59 37,5 Sup. disponible (m2/vaca) 7,7 17,6 10,6 Sup. del establo (m2/vaca) 9,3 19,3 12,2 Precio de superestructura (POS) (€/m2) 80 80 80 POS con fosa de purín (€/m2) 180 POS de área de reposo (€/m2) 24 49 POS de área de alimentación y de ejercicio (€/m2) 49 49 Tiempo de trabajo requerido (h/vaca y año) 1,2 1,8 1,2
tipos de cama compostada frente a un alojamiento de cubículos (Galama y col., 2011)
Inversión estimada
tres sistemas
alojamiento (Galama
Cubículos Compost Compostaje in situ Estructura Trabajos preparatorios 10.850 9.378 7.002 Infraestructura 250.387* 83.859 88.659 Cubierta 111.283 228.750 144.750 Total construcción 372.521 321.988 240.412 Instalaciones Sistema retirada de deyecciones 7.500 5.000 5.000 Cornadiza 10.819 10.920 10.920 Cubículos, bebederos 43.800 15.000 15.000 Iluminación 6.955 14.297 9.047 Fontanería y electricidad 10.000 10.000 10.000 Ventilación 24.000 12.000 Aireación de la cama 18.000 Total instalaciones 79.074 79.221 79.969 Almacenamiento de deyecciones Fosa de purín (para 6 meses) 63.360 63.360 Solera de estercolero (para 6 meses 6.188 3.300 Total almacenamiento deyecciones 0 69.548 66.660 Total 451.595 470.756 387.041 Total por vaca 3.011 3.138 2.580 Diferencia respecto a cubículos +128 -430
Tabla 3.
en
de
y col., 2011)
*Incluyendo fosa de purines
98 Frisona Española 212 m/a
que se precisa para proporcionar la superficie necesaria en cada uno de ellos.
El precio del material de cama puede ser bastante diferente en cada zona, según sea su disponibilidad.
La tabla 3 muestra los costes de inversión para cada uno de los tres sistemas indicados. El establo con compostaje in situ es 430 €/plaza más económico que el de cubículos, mientras que el establo con compost adquirido es 128 €/plaza más caro, debido a la mayor superficie por vaca que requiere.
El coste anual del establo con cama con compostaje in situ son 14€/vaca más bajo que el de cubículos, mientras que el de cama de compost comprado es 91 €/vaca más caro (Tabla 4).
Coste del material de cama
Al coste de la construcción habría que añadir el coste del material de cama y su disponibilidad. El mejor material, la viruta de madera, no siempre es fácil de conseguir, sobre todo en invierno, cuando la demanda puede ser mayor. Un incremento de 25 céntimos por vaca y día puede suponer un incremento de la factura anual de 7.300 € en un establo de 80 vacas. Por ello, es recomendable considerar la posibilidad de construir un almacén cubierto para comprar y acumular este material de cama cuando mayor es la disponibilidad y menor es el precio.
En el estudio de Horner citado el coste del material de cama suponía una media de 6,55±4,72 USD/m3 para todos los materiales empleados, lo que se traducía en 0,07±0,03 m3/vaca y día (0,70±0,49 USD/vaca y día) con material más húmedo, y 0,05±0,04 m3/vaca y día (0,35±0,37 USD/vaca y día) con materiales más secos.
El mayor uso de cama se produce en épocas frías o húmedas, cuando el calor generado por la cama en compostaje no es suficiente para mantenerla seca ni hay una elevada evaporación ambiental. En esta situación, se puede reducir el gasto

•Usar un material más seco en invierno y otro más húmedo en verano.
•Almacenar el material de cama bajo cubierta para evitar que se humedezca con la lluvia y la humedad ambiental. No obstante, no sólo debe considerarse el coste de construcción del establo y el del material de cama. Los estudios realizados hasta el momento muestran que en estos establos el confort de los animales es mayor, mejor es también la manifestación de los celos (menos días abiertos), mayor es la longevidad de las vacas (menor coste de reposición) y menor puede ser la incidencia de mamitis y de cojeras (menores costes veterinarios y menores costes por eliminación involuntaria de animales).
Además, el mayor volumen del establo (por la mayor superficie suministrada a cada vaca y la mayor altura de la nave) también conduce a unas mejores condiciones ambientales, sobre todo en verano.
En cualquier caso, siempre recomendamos que un establo sin cubículos se diseñe y dimensione para que sea fácil su posible transformación posterior a cubículos, si se desea, aunque el número de anima-

Cubículos Compost Compostaje in situ Estructura 236 204 152 Instalaciones 48 49 50 Almacenamiento deyecciones 0 44 42 Energía 57 68 63 Material de cama 20 75 40 Mano de obra 24 37 24 Total 385 477 371 Diferencia respecto a cubículos +91 -14
Tabla 4. Coste anual de los tres sistemas de alojamiento (Galama y col., 2011)
Uso de cama acumulada de compost en vaca de leche (II)

a ser cuestionado en aquellas zonas, como la UE, donde una buena parte de la población es muy sensible a estos temas.
Como todo sistema de alojamiento, tiene sus luces y sus sombras, algunas de las cuales han sido expuestas en las páginas anteriores. Como no nos cansamos de repetir, muchos de los fallos que se pueden observar en cualquier granja no son inherentes al alojamiento per se, sino a un mal manejo del mismo. Así, en este modelo de cama compostada es importante respetar determinadas condiciones para que pueda funcionar correctamente:
•Suficiente superficie por animal.
•Ventilación adecuada.
-Altura elevada
-Evitar proximidad de edificios
-Aberturas en cumbreras suficientes
-Adecuado diseño de esta cumbrera
-Disponibilidad y colocación de ventiladores
•Correcta orientación del edificio.
•Muros de contención de la cama.
•Suficiente espacio de comedero.
•Suficiente espacio de bebedero y acceso al mismo desde el pasillo de alimentación.
•Evitar cuello de botella en el movimiento de animales.
•Mantener la humedad y la temperatura de la cama en valores adecuados.
•Evitar empezar el compostaje en otoño o invierno.
•Aportar la cantidad de cama necesaria.
propiedades para su compostaje, incluso la posible utilización de suelos sintéticos bajo la cama que proporcionen drenaje en climas donde la pérdida de humedad mediante evaporación es más problemática. Asimismo, la excesiva humedad de la cama produce mayores emisiones de amoniaco, siendo éste otro inconveniente a solucionar.
Referencias Bibliográficas
Klass, I.C. y col. 2010. Cultivated barns for Dairy cows: An option to promote cattle welfare and environmental protection in Denmark? Dansk Veterinaertidsskrift, 93;20-29.
Black, R.A. y col. 2013. Compost bedded pack dairy barn management, performance, and producer satisfaction. Journal of Dairy Science, 96:80608074.
Galama, p. y col. 2011. Prospects for bedded pack barns for dairy cattle. Wageningen UR Livestock Research. 70 pp.
Tyson, J. Thinking about a compost bedding pack? Acceso el 11 de abril de 2016. http:// extension.psu.edu/animals/dairynews/2011/thinking-about-a-compost-beddinge-pack
Janni, K. y col. 2005. Composting bedded pack barns for Dairy housing. University of Minnesota. Dairy Extension Service.
Kammel, D.W. 2010. Compost bedded barn design and management. University of Wisconsin Extension.
Taraba, J. 2012. Compost bedded pack barns. Composting and design considerations. Univer-
Gay, S.W. Bedded pack dairy barns. Acceso el 10 de abril de 1016. https://pubs.ext.vt.edu/

100
212 m/a
Frisona Española
EL SECADO
DONDE TODO COMIENZA
Problemática
actual del secado de la vaca
Hasta la fecha, el secado ha supuesto un problema tanto para el ganadero como para la vaca . Los métodos actuales, abrupto y gradual, tienen una serie de inconvenientes desde tres puntos de vista: manejo, salud de la ubre y bienestar de la vaca .
- Con un secado abrupto, las vacas se ordeñan y se alimentan de forma habitual, hasta el último día. El problema es que, al dejar de ordeñar la vaca, la ubre se llena de leche, aumenta el riesgo de nuevos casos de mamitis y la vaca siente dolor e incomodidad (pasan menos tiempo tumbadas y algunas expresan su malestar con mugidos).
Por lo tanto, el secado abrupto supone una ventaja por tener un manejo sencillo, pero tiene inconvenientes para la salud de la ubre y el bienestar de la vaca
- Por el contrario, con un secado gradual buscamos reducir la producción de leche de forma progresiva, ordeñando con menos frecuencia o dando menos comida a las vacas. Este tipo de manejo es más laborioso y además conlleva una pérdida de producción
La ventaja del método gradual es que la vaca llega al secado con menos litros, pero tiene varios inconvenientes: un manejo más difícil, afecta al bienestar de la vaca y, en el caso de ordeñar con menos frecuencia, es un problema para la salud de la ubre.
Por todo ello, ninguno de los métodos actuales cubre todas las necesidades de la vaca y el ganadero. Es necesaria una nueva forma de realizar el secado, que facilite el manejo, cuide la salud de la ubre y tenga en cuenta el bienestar de la vaca.
Antonio Jiménez Ceva, salud animal antonio.jimenez@ceva.com
MANEJO
SALUD DE LA UBRE BIENESTAR
PROVISIONAL














Concurso Nacional CONAFE 2016 de la Raza Frisona
Recinto Ferial de Asturias “Luis Adaro”. Gijón, 22 al 25 de septiembre
Reglamento del Concurso
Artículo 1º.- Organizado por la Confederación de Asociaciones de Frisona Española (CONAFE) y la colaboración de Asturiana de Control Lechero Asociación Frisona (ASCOLAF) se celebrará el 37º Concurso Nacional CONAFE 2016 de la Raza Frisona, en el Recinto Ferial de Asturias “Luis Adaro” (Gijón), durante los días 22 al 25 de septiembre.
Este Concurso está autorizado y dirigido técnicamente por el Ministerio de Agricultura, Alimentación y Medio Ambiente.
Fines
Artículo 2º.- Los fines que se persiguen, fundamentalmente son: poner de manifiesto la mejora que se viene haciendo en el país respecto al ganado de la raza a través de la labor selectiva practicada; estimular la dedicación de los ganaderos a la vía de ganado de pedigrí y su participación en los procesos selectivos; orientar la selección y facilitar la adquisición de reproductores selectos, como base para la mejora de las explotaciones y la cría de ganado de esta raza y para competir en el mercado interior y extranjero.
Comités
Artículo 3º.-Comité Organizador.
La función es la de ejercer de responsable máximo de la ejecución de todos los servicios y medios necesarios para la celebración del certamen y de la aplicación del Reglamento, así como de cualquier incidencia que se presente no prevista en el Reglamento o las dudas que pudieran existir en la interpretación del mismo.
Presidente:
•Germán de la Vega Delgado. Presidente de CONAFE.
Vicepresidentes:
•José Emilio García Suárez. Presidente de ASCOLAF.
•Director del Recinto Ferial de Asturias “Luis Adaro”.
•Presidente de la Sociedad Mixta de Turismo y Festejos de Gijón.
•Director General de Agroganadería del Principado de Asturias.
Vocales:
•Todos los miembros de la Junta de Gobierno de CONAFE
•Todos los miembros de la Junta de Gobierno de ASCOLAF
Coordinadores:
•Sofía Alday Martínez de Cestafe. Directora Gerente de CONAFE.
•Carlos Méndez Suárez. Director Gerente de ASCOLAF.
Artículo 4º.- Comité de Admisión.
4.1 Estará compuesto por:
Presidente:
Un miembro de la Junta de Gobierno de CONAFE que no presente ganado al Certamen.
Vocales:
•Gabriel Blanco del Campo. Jefe del Departamento de Morfología de CONAFE.
•Juan Manuel Fernández Ahedo. Coordinador de Calificadores de CONAFE.
•Un Juez Nacional de CONAFE.
•Un Técnico de la Consejería de Agroganadería y Recursos Autóctonos del Principado de Asturias, designado por dicho Organismo.
•Otros técnicos nombrados por la Junta de Gobierno de CONAFE.
Secretarios:
•Los coordinadores generales del Concurso.
4.2 Sus funciones son:
-Verificar la documentación genealógica y su correspondencia con los animales presentados y corroborar que se ajustan a las secciones para las que se presentan al Concurso.
-Colaborar con el Servicio Veterinario de Inspección Sanitaria para garantizar que cada animal se presenta con la documentación sanitaria exigida.
-Comprobar y verificar, en cualquier momento y sin lugar a nin-
guna objeción por parte de los participantes, que la preparación y presentación de animales se ajusta a los requisitos del Reglamento.
4.3 Sus facultades son:
-Cualquier miembro del Comité puede circular libremente por el recinto del ganado, pudiendo exigir cualquier control o verificación de un animal.
-Podrá dividir las secciones de mucha participación en dos grupos con el objeto de hacer más fácil el juzgamiento.
-Ante una anomalía observada que incumpla este Reglamento, se comunicará a los coordinadores generales, quienes podrán reunir al Comité para tomar la decisión que estime adecuada. El Comité podrá sancionar con la exclusión de un animal del Concurso o con la anulación de un resultado otorgado en el mismo.
Artículo 5º.- Comité de Juzgamiento.
5.1 Estará compuesto por un Juez único a quien acompañará en pista un Técnico de CONAFE, quien actuará de auxiliar para aquél, facilitándole todo tipo de información que se solicite sobre el ganado concursante y hará, al mismo tiempo, de intérprete.
-El Juez será Bonet Cid, Juez Internacional de CONAFE.
-Las decisiones del Juez serán inapelables.
5.2 Obligaciones del Juez.
-Clasificar todos los animales en cada sección según el mérito morfológico, colocándolos en la pista según dicho orden y dar explicación verbal, al menos, de los cinco primeros.
-El Juez debe comportarse en la pista con corrección hacia la Organización, participantes y público, evitando cualquier conducta que pudiera ser objetable o provocativa o que pudiera, de alguna manera, incitar a cuestionar su imparcialidad.
-Firmar el Acta con los resultados del Concurso y emitir un informe de las incidencias.
5.3 Facultades del Juez.
-Eliminar de la pista los animales que no reúnan las condiciones mínimas de juzgamiento o que contravengan los requisitos del Reglamento.
-Dejar desierta alguna sección o algún premio de una sección del programa si los animales, por su cantidad o su calidad, no son a su juicio merecedores de la sección o del puesto.
Artículo 6º.- Todas aquellas cuestiones que exceden de la competencia del Comité de Admisión y del Comité de Juzgamiento, así como cualquier incidencia que se presente y no esté prevista en este Reglamento, o las dudas que pudieran existir en la interpretación del mismo, serán resueltas por la Comisión Organizadora del certamen.
Artículo 7º.- Podrán tomar parte en el certamen todos los ganaderos con animales inscritos en el Libro Genealógico que lo deseen y así lo soliciten mediante la Cédula de Inscripción, siempre que lo hagan dentro del plazo establecido y que el ganado concurrente reúna todas las condiciones que para el mismo se exigen en este Reglamento. Sólo se impondrán limitaciones en cuanto al número de ejemplares concursantes por ganadería, en caso de que la cifra de solicitudes rebase las posibilidades de alojamiento ferial.
Artículo 8º.- Las solicitudes de participación se formularán rellenando las "Cédulas de Inscripción" correspondientes y remitiéndolas, una vez cumplimentadas, a la Confederación de Asociaciones de Frisona Española (CONAFE), cuya dirección postal es: Apartado de Correos nº 31 (o Crta. de Andalucía, Km. 23,600) - 28340 Valdemoro (Madrid) o a la dirección de correo electrónico conafe@conafe.com. Sólo tendrán derechos y obligaciones en el Concurso los ganaderos que se hayan inscrito en plazo y forma.
37 102 Frisona Española 212 m/a
Artículo 9º.- Los impresos de Cédulas de Inscripción pueden descargarse de la web www.conafe.com, solicitarse a la Confederación de Asociaciones de Frisona Española (CONAFE), a la dirección indicada en el Artículo precedente o a Asturiana de Control Lechero Asociación Frisona (ASCOLAF).
Artículo 10º.- Las Cédulas de Inscripción indicadas se rellenarán a máquina, cumplimentándose todos los datos que en ellas se piden; si no es posible rellenarlas a máquina, se hará con letra clara y se utilizarán letras mayúsculas para poner el número genealógico de cada ejemplar, su nombre y fecha de nacimiento.
Artículo 11º.- El plazo concedido para remitir las Cédulas de Inscripción, cumplimentadas según las normas indicadas en los Artículos precedentes, finalizará el día 8 de septiembre de 2016, a las 16:00 horas. Los animales que no figuren inscritos en el Catálogo, no podrán participar en el Concurso.
Condiciones Generales a)De tipo general.
Artículo 12º.- El ganado concursante será nacido en España, procederá de explotaciones inscritas en el Libro Genealógico y contará con la calificación sanitaria hecha en la explotación que lo inscriba.
Artículo 13º.- Para la inscripción de animales en las categorías de vacas en lactación es condición necesaria que, tanto los animales a inscribir como las ganaderías propietarias de los mismos, estén incluidos en Control Oficial de Rendimiento Lechero, tal como se establece en el R.D. 368/2005, de 8 de abril, por el que se regula el Control Oficial de Rendimiento Lechero para la evaluación genética en las especies bovina, ovina y caprina.
Artículo 14º.- Los animales asistentes deberán encontrarse en las suficientes condiciones de presentación y manejo que la categoría y distinción de la raza exigen. Los ejemplares que no reúnan suficientes condiciones serán eliminados del recinto del certamen por el Comité de Admisión.
Artículo 15º.- Las edades citadas en las distintas secciones del Programa se entenderán referidas al 31 de agosto de 2016.
b)De carácter genealógico.
Artículo 16º.- Serán condiciones indispensables que todos los animales concursantes figuren inscritos en el Libro Genealógico de la Raza a nombre de la ganadería que los presenta y que se presenten al certamen con las correspondientes Cartas Genealógicas o Certificaciones de Registro, cumplimentadas según las normas exigidas por el Reglamento de dicho Libro Genealógico. No podrán participar animales inscritos en el Registro Auxiliar Categoría “A”.
Artículo 17º.- Las Cartas Genealógicas o Certificados de Registro, una vez examinados y hechas las comprobaciones oportunas por el Comité de Admisión, serán devueltas a los propietarios o encargados del ganado.
c)De aspectos sanitarios: Artículo 18º.
NORMAS GENERALES
1. Todos los animales vendrán acompañados de la Guía de Origen y Sanidad Pecuaria (GOSP) y del Documento de Identificación Bovina (DIB).
2. Los vehículos de transporte deberán reunir las condiciones exigidas en la normativa vigente, sobre protección de animales durante el transporte.
EXPLOTACIONES
1. No hallarse sometida a restricciones para el movimiento de animales por motivos de sanidad animal, de acuerdo con la normativa vigente.
2. Estar situadas en una zona que no esté sometida a una prohibición o restricción de conformidad con la legislación sanitaria vigente.
3. Certificado oficial acreditando que los animales proceden de explotaciones oficialmente indemnes a: Tuberculosis (T3), Brucelosis (B4), Leucosis, libres de Perineumonía contagiosa Bovina.
ANIMALES
1. Identificación Oficial individual y DIB.
2. Certificado veterinario acreditando que los animales han recibido tratamiento antiparasitario interno y externo en los últimos 30 días a su traslado.
medad infectocontagiosa, al menos en las 48 horas anteriores al traslado.

3. No presentarán sintomatología que haga sospechar de enfer-
4. Respecto a IBR: certificado oficial veterinario o certificado veterinario e informe laboratorial acreditando que en los 30 días anteriores a la entrada en el concurso todos los animales han resultado negativos a una prueba de detección de anticuerpos frente a la IgE del virus de la IBR.
5. Certificado Oficial veterinario, acreditando que en los 30 días anteriores a la entrada en el Concurso, los animales han resultado negativos frente a las pruebas sanitarias individuales contra las siguientes enfermedades:
Animales menores de 12 meses
-Tuberculosis.
-Paratuberculosis.
-Prueba de detección de Antígeno negativa, de la Diarrea Vírica Bovina, realizada en un laboratorio oficial.
Animales mayores de 12 meses
-Tuberculosis.
-Brucelosis.
-Leucosis Enzoótica Bovina.
-Perineumonía Contagiosa Bovina.
-Paratuberculosis.
-Prueba de detección de Antígeno negativa, de la Diarrea Vírica Bovina, realizada en un laboratorio oficial.
Respecto a la Lengua Azul, consultar condiciones sanitarias con la Organización o con las autoridades competentes de cada Comunidad Autónoma.
Artículo 19º.- Con objeto de poder obtener las certificaciones anteriormente citadas, los ganaderos que piensen concurrir con su ganado al Certamen, las solicitarán de la Jefaturas Provinciales de Producción Animal u órgano equivalente de las Comunidades Autónomas.
Vigilancia Sanitaria
Artículo 20º.- El equipo de veterinarios del Servicio de Ganadería de la Consejería de Agroganadería y Recursos Autóctonos del Principado de Asturias será el encargado del examen de los animales a su llegada al recinto ferial y durante su permanencia en el mismo para comprobar su estado sanitario y exigir, examinar y retener hasta la salida del ganado la documentación sanitaria que se indica en los Artículos 18º y 19º de este Reglamento. Este personal constituye el "Servicio de Inspección Sanitaria".
Artículo 21º.- Aquellos animales que presenten síntomas de enfermedades o los que carezcan de alguno de los documentos o requisitos sanitarios exigidos, no serán autorizados a entrar en el recinto ferial y serán secuestrados o devueltos a su origen, según proceda.
Artículo 22º.- El transportista de los animales, deberá presentar certificado o talón de desinfección, expedido conforme al Real Decreto 1559/2005, de 23 de diciembre.
Artículo 23º.- Este Servicio de Inspección Sanitaria colaborará con el Comité de Admisión, al que dará cuenta de las incidencias que se produzcan en su actuación.
Instalaciones
Artículo 24º.- El recinto en el que se celebre este certamen ganadero de carácter nacional, dispondrá en sus instalaciones o en sus en proximidades de un centro de limpieza y desinfección de vehículos de transporte de ganado, autorizado por la Consejería de Agroganadería y Recursos Autóctonos, en cumplimiento del artículo 54 de la Ley 8/2003, de 24 de abril, de Sanidad Animal.
Transporte de Ganado
Artículo 25º.- Para atender a los gastos originados por el transporte del ganado, la Organización compensará a los ganaderos concursantes mediante factura dirigida a CONAFE a razón de 0,27 euros (terneras y novillas) y 0,37 euros (vacas) por kilómetro recorrido y por animal, contando los kilómetros una sola vez desde la finca al recinto ferial.
Artículo 26º.- Los vehículos de transporte del ganado estarán debidamente desinfectados, lo que acreditarán con el Talón correspondiente en el que figurará la fecha de la desinfección y el procedimiento empleado.
Descarga y Alojamiento del Ganado
Artículo 27º.- La descarga del ganado se hará previa autorización del Servicio de Inspección Sanitaria indicado en el Artículo 20º y en
m/a 212 Frisona Española 103

su presencia, una vez comprobada la documentación sanitaria presentada por los conductores del ganado.
Artículo 28º.1- El alojamiento del ganado en el recinto ferial se hará bajo la dirección del Comité de Admisión, debiendo ocupar cada animal el lugar que le sea asignado. No obstante, se permitirá que animales participantes en el Concurso permanezcan en los stands comerciales siempre que éstos estén habilitados para ello. 28.2 Queda prohibida la salida de animales de la zona delimitada por el pabellón de estabulación y la carpa de lavado, sin permiso de la Organización.
Sujeción del Ganado
Artículo 29º.- Cada ejemplar deberá presentarse provisto de cabezada y ramal para su manejo y sujeción.
Entrada y Estancia del Ganado
Artículo 30º.- Los animales concursantes deberán ser presentados en las instalaciones del certamen, hasta las 20:00 horas del día 24 de septiembre. Aquellos concursantes que no presenten su ganado en el plazo fijado, no serán admitidos al certamen.
Artículo 31º.- Los animales expuestos en el recinto ferial no podrán ser retirados del mismo hasta la finalización del certamen, es decir, después de las 18:00 horas del día 27 de septiembre. Quienes contravinieran esta norma serán privados de los premios que hubieran podido alcanzar y podrán ser sancionados a no admitirlos en futuros certámenes.
Custodia del Ganado
Artículo 32º.- La custodia y manejo del ganado correrá a cargo de sus propietarios, que deberán adoptar las medidas más apropiadas para garantizar la seguridad de su ganado, ya que serán responsables de las incidencias o alteraciones que puedan provocar durante su permanencia en el recinto ferial.
Artículo 33º.- Los riesgos que puedan concurrir durante la carga, descarga y transporte del ganado, así como las incidencias que puedan producirse durante su permanencia en el recinto del Certamen, quedarán bajo la responsabilidad de los expositores.
Artículo 34º.- En ningún caso la Organización será responsable de los accidentes, enfermedades de cualquier tipo o sustracciones que puedan ocurrir a los expositores, a sus ejemplares o a terceras personas, así como a los animales durante el desarrollo del Concurso.
Seguro del Ganado
Artículo 35º.- Con la finalidad de cubrir parte de los riesgos indicados en los Artículos precedentes, la Organización suscribirá a su cargo un seguro "tipo" de ganado, con entidad de la máxima garantía, que compense los accidentes que pueda sufrir el ganado durante la operación de carga, transporte y descarga, así como de los que puedan producirse durante su permanencia en el recinto ferial.
Alimentación y Limpieza
Artículo 36º.- La organización facilitará la alimentación del ganado (alfalfa y pulpa) en cantidades suficientes. Igualmente se facilitará la paja y serrín necesarios para preparar la cama.
Artículo 37º.- Los expositores podrán disponer de cantidad extra de los productos, previo pago de su importe, en el almacén habilitado por la Organización dentro del recinto.
Artículo 38º.- El recambio de las camas correrá a cargo de los expositores; éste deberá ser realizado durante las horas en que permanezca cerrado al público el recinto ferial y siempre antes de las 08:00 horas.
Los participantes aceptan expresamente, y para facilitar las tareas de limpieza, el depositar la paja y el estiércol en el lugar que la comisión organizadora destine a este fin.
Artículo 39º.- El lavado de los animales deberá realizarse en los puntos oportunamente señalados por la Organización.
Carteles
Artículo 40º.- Se permitirán tres tipos de carteles:
a) Carteles publicitarios de la Asociación/Federación participante.
b) Carteles publicitarios de la ganadería.
Ambos carteles estarán homologados con las siguientes características:
•Han de ser sobre fondo blanco.
•Sus medidas serán entre 3 y 6 metros de largo y 0,80 de ancho.
c) Carteles de identificación del animal. Estos últimos carteles serán facilitados por la entidad organizadora y en ellos constarán los siguientes datos:
•Nombre del animal.
•Número Genealógico o CIB.
•Número de identificación en la pista.
•Fecha de nacimiento.
•Sección a la que pertenece.
•Nombre del padre.
•Nombre del padre de la madre.
•Índice Genético (ICO).
•Nombre de la ganadería.
Asistencia Sanitaria
Artículo 41º.- Durante la celebración del Certamen funcionará en el recinto del mismo un servicio veterinario gratuito, al que podrán acudir cuantos expositores lo precisen para la atención del ganado, siendo el importe de los medicamentos a utilizar por cuenta de los propietarios del ganado.
Presentación del Ganado en Pista y Exhibiciones
Artículo 42º.- La presentación del ganado en pista, cuantas veces sean necesarias para su calificación, así como su participación en las exhibiciones que determine la Organización, será obligatoria, debiendo ser conducido por los propietarios y/o personal a su cargo. Los animales que lleguen tarde a su presentación en pista ocuparán el último lugar dentro de la sección.
Artículo 43º.- De la presentación en pista.
Los concursos son la base para presentar a la raza y útiles para fomentar el contacto entre ganaderos. Los animales serán presentados en la pista de la forma más natural posible, con un cuidado, tanto veterinario como estético, que no afecte al bienestar, a la salud, al estrés y a la morfología del animal. Debe cumplirse la siguiente premisa: Los animales sanos no deben ser tratados y los enfermos no deben salir a pista.
1.Preparación y acicalado de los animales
Con el fin de que los animales se presenten en pista de la forma más natural posible, todas las prácticas y procedimientos, tanto técnicos como cosméticos, están prohibidos, a excepción de:
-Lavar y pelar el animal.
-Preparación de la línea dorso lumbar solamente con pelo nacido de su propio folículo piloso y que no exceda de los tres centímetros de longitud.
-Equilibrado y llenado natural de las ubres con leche propia del animal y sin alterar su bienestar.
-El uso de una cola postiza.
-Tratar el animal con substancias no irritantes para resaltar el color de la capa y la textura de la ubre.
-Sellado de pezones para evitar pérdidas de leche.
-Arreglo de pezuñas.
2.Uso de medicamentos veterinarios
Está prohibido, por parte de preparadores, propietarios, visitantes o cualquiera, el uso o la posesión de medicamentos veterinarios durante todo el concurso, a excepción de:
-Xylazina, obtenida y administrada por el servicio veterinario.
-Oxitocina, por si fuera necesaria para el ordeño.
-Finadyne, administrada por el servicio veterinario.
-Otros medicamentos aparte de los anteriormente citados (Oxitocina, Finadyne y Xylazina) solo podrán ser administrados por el servicio veterinario. Cualquier medicamento administrado, a excepción de la Xylazina, Finadyne u Oxitocina, después de las 08:00 horas del día del concurso, descalificará al animal para el concurso, salvo justificación y aprobación del servicio veterinario.
3.Conforme a las normas
-Cualquier otra modificación no recopilada en los puntos anteriores, que afecte al estado natural del animal y que pueda interferir, a juicio de la Comisión de Admisión, en la salud, estrés, bienestar del animal y morfología del mismo.
- El propietario de un animal es responsable del cumplimiento de la normativa del Concurso. Él debe asegurarse de que sus técnicos, agentes u otras personas que actúan en su animal cumplen con las normas del Concurso.
- Los participantes en el concurso están obligados a obedecer las reglas y el reglamento del concurso, aceptando someterse a cualquier inspección requerida por la Organización.
-Obligatoriamente las tres primeros vacas de cada sección en producción serán sometidas a una prueba de escáner ecográfico de la ubre, inmediatamente después de terminar el juzga-
104 Frisona Española 212 m/a
miento de la sección.
-Se podrá llevar a cabo un examen de la ubre con ultrasonidos, de cualquier vaca antes o después del juzgamiento, si el Comité de Admisión lo considera oportuno.
-Ninguna vaca será sometida al escáner ecográfico antes del juzgamiento si no es autorizado por el Comité de Admisión.
-El Comité de Admisión tiene autoridad para recoger y examinar, en cualquier momento, muestras biológicas del cuerpo de los animales, para su análisis.
-El propietario debe aceptar las normas incluidas en el presente Reglamento y comprometerse a su cumplimiento, para lo que firmará un documento (ver Anexo) de aceptación de las mismas que adjuntará a la Cédula de Inscripción o entregará a la Organización antes del inicio del Concurso.
-Habrá vigilancia para controlar prácticas que contravengan estas normas las 24 horas de los días del Concurso, durante los cuales la Organización podrá realizar inspecciones.
4.Medidas frente al incumplimiento de las normas éticas
-Si se comprueba una infracción o resulta positivo al escaneado un animal, se descalificará al animal del Concurso y se le retirarán sus premios y títulos conseguidos, ocupando sus puestos los animales inmediatamente siguientes .
-Se prohíbe entrar en pista a todos los animales a los que se detecte cualquier infracción al cumplimiento del Reglamento.
-El Comité de Admisión emitirá un informe a la Junta de Gobierno de CONAFE, quien se reserva el derecho de imponer medidas complementarias al propietario.
-Las decisiones de la Junta de Gobierno de CONAFE son definitivas.
Faltas y Sanciones
Artículo 44º.- Además de las atribuciones conferidas en el Art. 4º al Comité de Admisión y en el Art. 5º al Comité de Juzgamiento, serán consideradas las siguientes faltas y sanciones, tomando como fecha de inicio de la sanción la fecha de notificación de la falta.
1.Faltas
Leves
-Falta de diligencia y celo en la confección de los documentos para el Concurso.
-Falta de colaboración con los Servicios Veterinarios de Inspección Sanitaria o con el personal de la Organización.
Graves
-Realización de actividades que sean contrarias a los principios inspiradores de un Concurso Nacional en la forma que se prevé, o bien en contra de la actividad ganadera, del bienestar y salud de los animales o de los intereses del sector.
-El incumplimiento probado por el Comité de Admisión de las prácticas no permitidas que se recogen en el Art. 43, apartado 2.
-Dar positivo al escaneado de un animal, según Art. 43 apartado 4, punto 3º.
-Falta de consideración manifiesta hacia el Juez del Concurso, secretarios de pista, otros participantes y/o hacia personal de CONAFE y de la Asociación/Federación autonómica colaboradora en la organización del Concurso.
-Comportamiento incorrecto en pista.
-Reiteración de faltas leves.
Muy Graves
-Incumplimiento del Art. 43, apartados 1 y 2.
-Cualquier falsificación de la documentación genealógica y su correspondencia con los animales presentados.
-Reiteración de resultado positivo en el escaneado de un animal o de una misma ganadería.
-Reiteración de faltas graves.
2.Sanciones
Además de lo que ya se contempla en el propio Reglamento del Concurso, de acuerdo con la calificación de la falta, se podrían aplicar las siguientes sanciones:
-Apercibimiento verbal en el momento de la infracción y por escrito de la Junta de Gobierno de CONAFE a la ganadería infractora con copia a la Asociación/Federación de su C.A., en todos los casos en los que se aprecie falta leve.
-Además de las acciones tomadas por las faltas leves, se dará público conocimiento de la infracción, a través de la revista Frisona Española, si ésta pusiera en peligro la defensa de los intereses del sector y/o de la raza y en todos los casos de falta grave o muy grave.
-Además de las acciones tomadas por las faltas graves, en las faltas consideradas como muy graves, se dará parte al Inspector de la Raza y al Gobierno de la C.A., del interesado, si la falta además fuera en contra de la actividad ganadera, de la higiene, salud y bienestar de los animales.
-Aquella ganadería que haya incurrido en una falta grave no podrá participar durante un año en ningún otro Concurso Nacional o regional de la raza frisona. En el caso de las faltas muy graves, la sanción será de dos años sin posibilidad de participar en concursos regionales o nacionales de la raza frisona.
-Las decisiones de estas sanciones podrán ser recurridas por los interesados, antes de un mes, a la Asamblea General de la Confederación, que decidirá y agotará la vía administrativa, debiéndose realizar su estudio en la primera de sus reuniones.
Artículo 45º.- El ganado que no sea presentado en pista en el momento indicado para su calificación, será eliminado del Concurso. Los animales que lleguen con retraso ocuparán el último lugar dentro de la sección.
De los Presentadores
Artículo 46º.- Cada presentador llevará un distintivo con el número identificativo del animal en pista, facilitado por la Organización, que coincidirá con el correspondiente número de orden del Catálogo del Certamen.
Artículo 47º.- Los presentadores irán uniformados con pantalón blanco y camisa blanca.
Artículo 48º.- Se establecen tres premios a presentadores que serán otorgados por el Juez, después de observar su actuación a lo largo de todo el Concurso.
Salida del Ganado
Artículo 49º.- Una vez finalizado el certamen, para la salida del ganado del recinto ferial, los propietarios deberán proveerse de la oporAnexo
CERTIFICADO
DON ..........................................................., con D.N.I..............................., en mi calidad de ..................................... de la explotación ganadera ............................................................, por medio de la presente ACEPTO dar cumplimiento al Reglamento del Concurso, redactado por CONAFE, que conozco, tengo a mi disposición y he leído, por el que se rige el 37º CONCURSO NACIONAL CONAFE’16 a celebrar entre los días 22 al 25 de septiembre del año 2016, en la ciudad de Gijón, por lo que, y en base al contenido del mismo, por la firma del presente documento me COMPROMETO a,
1.-Actuar de acuerdo a lo establecido en el Reglamento del Concurso, y muy concretamente, a las normas y prácticas relacionadas con el bienestar de los animales.
2.-A mantener mis animales en perfectas condiciones de salud y bienestar durante el Concurso, reconociendo ser el único y exclusivo responsable de las acciones de mis empleados, mías propias, y de las de cualquier otra persona que me ayude con el equipamiento, cuidado y preparación de los animales durante la vigencia del Concurso.
3.-A evitar y denunciar ante la Organización cualquier incumplimiento de las normas del Concurso, que a su vez, pueda perjudicar a la ganadería de la raza frisona, a los propios ganaderos participantes en el Concurso, a otros expositores y a los trabajadores en el Concurso y a los visitantes.
4.-Eximir a los organizadores, y a su personal, de cualquier acción de sanción que se pueda tomar por los mismos al amparo del Reglamento del Concurso.
5.-Asumir, a mi costa y cargo, cualquier perjuicio, daño o pérdida, sufrida durante el tiempo de duración del Concurso, tanto si es debido, directa o indirectamente, a las acciones u omisiones de los organizadores del mismo, como si no.
Una vez leído y de acuerdo con su texto y contenido, se firma en ........................, a .......... de ............................ de 2016.
FirmaGanadería

m/a 212 Frisona Española 105
tuna Guía de Origen y Sanidad, e interprovincial en los casos necesarios, debiendo retirar igualmente la documentación sanitaria que les fue recogida a la entrada por el Servicio de Inspección Sanitaria.
Artículo 50º.- No se permitirá la carga del ganado en vehículos que no estén previamente desinfectados y que lo demuestren mediante el talón correspondiente.
Premios a Concursantes
Artículo 51º.- Todo ganadero expositor recibirá los diplomas, trofeos, banderines, estandartes, etc., que se mencionan en las diferentes secciones del programa.
-La primera clasificada de cada sección, las campeonas y las subcampeonas tendrán derecho y obligación a una fotografía gratuita oficial para la difusión de la raza, realizada en el set que se instale al efecto en el recinto del Concurso. El incumplimiento de este punto será sancionado con la pérdida de la publicidad
Jueves, día 22 de septiembre:

gratuita y de los premios en metálico.
-Se concederá una página gratuita de publicidad en la revista Frisona Española a la Ternera Campeona, Novilla Campeona, Gran Campeona Nacional (Novillas), Vaca Joven Campeona, Vaca Intermedia Campeona, Vaca Adulta Campeona, Gran Campeona Nacional (Vacas), Gran Campeona Nacional Reserva (Vacas), Mejor Autonomía, Mejor Rebaño Nacional y Mejor Criador Nacional.
Ayudas a la participación
Artículo 52º.- Todo ganadero concursante recibirá las siguientes cantidades en concepto de ayuda económica a la participación:
-Terneras y Novillas: 30 € por animal presentado en pista.
-Vacas: 50 € por animal presentado en pista.
-El genotipado gratuito de hembra en baja densidad por cada animal presentado en pista.
Calendario de actuaciones
Entrada de ganado. La entrada de ganado deberá realizarse hasta las 20 horas del día 22 de septiembre.
Viernes, día 23 de septiembre:
Descanso del ganado.
Sábado, día 24 de septiembre:
Mañana: Concurso (Terneras y Novillas)
Primera Sesión: desde las 10:00 horas.
Juzgamiento de las secciones:
1, 2, 3, 4, 5, 6, 7, 8 y 9.
Tarde:
16:30 horas. XVI Campeonato Nacional de Manejadores
Domingo, día 25 de septiembre:
Mañana: Concurso (Vacas lactación y grupos).
Segunda Sesión: desde las 10:00 horas.
Juzgamiento de las secciones:
10, 11, 12, 13, 14, 15, 16, 17, 18, 19, 20, 21, 22, 23 y 24.
NOTA: Todos los actos comenzarán rigurosamente a las horas fijadas.
NOTAS PREVIAS DE INTERÉS
Fecha de referencia: A efectos de determinar la edad, se considera como tal el día 31 de agosto de 2016.
1. La identificación, edad, parentesco y propiedad de los animales se comprobarán por el Comité de Admisión mediante la correspondiente Carta Genealógica Oficial o Certificado de Registro, que deberá ser entregado siempre que el Comité lo solicite. El animal del que no se presente la documentación anterior no podrá competir.
2. Definiciones:
a) Novilla no parida: Toda aquella que no haya parido nunca.
b) Hembra lactación: Es aquella que se encuentra en ordeño.
3. El Juez en cada sección establecerá un orden de mejor a peor.
4. Se publicará a continuación del Concurso, antes de finalizar los actos, una relación de todos los animales con el lugar establecido por el Juez de pista en cada sección.
5. A efectos de consecución de premios (banderines, estandartes, trofeos, diplomas, etc.) se considerarán los cinco primeros puestos en pista.
6. Los estandartes y/o banderines y trofeos se entregarán en la misma pista de competición, en el momento de realizar su dictamen el Juez al final de cada sección.
7. Los campeonatos no serán premios únicos, sino que se subdividirán en:
-Campeona.
-Subcampeona.
8. El Gran Campeonato de Novillas será premio único y el Gran Campeonato de Vacas se subdividirá en:
-Gran Campeona Nacional (Vacas).
-Gran Campeona Nacional Reserva (Vacas).
9. El título de Campeona queda reservado para animales individuales, no para grupos de animales.
10. Los grupos de animales obtendrán el título de Mejor y Segundo.
11.Se concederán Estandartes de color azul (letras y cenefas doradas) a:
•Campeona y Subcampeona.
•Gran Campeona Nacional y Gran Campeona Nacional Reserva (Vacas).
•Mejor Rebaño Nacional y Segundo Rebaño Nacional.
•Mejor Criador Nacional y Segundo Criador Nacional.
•Mejor Autonomía y Segunda Autonomía.
12. Se concederán Banderines a los cinco primeros clasificados en cada sección individual, con el distintivo de color único (azul), indicando su clasificación.
13. Se concederá Banderín a la mejor ubre de cada sección.
14. Las actuaciones del Juez en pista se realizarán de forma ininterrumpida, desde el comienzo de cada sección hasta finalizar el programa previsto para el día.
15. Cada sección será juzgada siguiendo el orden que figura en el calendario.
Secciones y premios
Sección 1ª. Terneras de 8 a 10 Meses
Son las hembras de 8 a 10 meses. (Nacidas entre el 1 de octubre de 2015 y el 31 de diciembre de 2015).
Sección 2ª. Terneras de 11 a 13 Meses
Son las hembras de 11 a 13 meses. (Nacidas entre el 1 de julio de 2015 y el 30 de septiembre de 2015).
Sección 3ª. Terneras de 14 a 16 Meses
Son las hembras de 14 a 16 meses. (Nacidas entre el 1 de abril de 2015 y el 30 de junio de 2015).
Sección 4ª. Novillas de 17 a 19 Meses
Son las hembras de 17 a 19 meses, no paridas. (Nacidas entre el 1 de enero de 2015 y el 31 de marzo de 2015).
Sección 5ª. Novillas de 20 a 22 Meses
Son las hembras de 20 a 22 meses, no paridas. (Nacidas entre el 1 de octubre de 2014 y el 31 de diciembre de 2014).
Sección 6ª. Novillas de 23 a 26 Meses
Son las hembras de 23 a 26 meses, no paridas. (Nacidas entre el 1 de junio de 2014 y el 30 de septiembre de 2014).
106 Frisona Española 212 m/a
Fecha de Referencia: A efectos de determinar la edad, se considera como tal el día 31 de agosto de 2016

Nota: la Organización podrá limitar la participación a 3 animales por ganadería, en las secciones 1ª, 2ª, 3ª, 4ª, 5ª y 6ª.
Sección 7ª. Ternera Campeona
Competirán las dos primeras clasificadas en las secciones 1ª, 2ª y 3ª. Se obtendrán los títulos de Ternera Campeona y Ternera Subcampeona.
Sección 8ª. Novilla Campeona
Competirán las dos primeras clasificadas de las secciones 4ª, 5ª y 6ª. Se obtendrán los títulos de Novilla Campeona y Novilla Subcampeona.
Sección 9ª. Gran Campeona Nacional (Novillas)
Competirán la Ternera Campeona (Sec. 7ª) y la Novilla Campeona (Sec. 8ª). Se obtendrá el premio único de Gran Campeona Nacional (Novillas).
Nota: El juzgamiento de las secciones 7ª, 8ª y 9ª (Campeonato de Terneras, Campeonato de Novillas y Gran Campeonato de Novillas), se realizará simultáneamente en pista.
Sección 10ª. Vaca Joven Lactación hasta 30 Meses
Hembras hasta 30 meses en ordeño. (Nacidas después del 31 de enero de 2014). Se entregará un banderín a la Mejor Ubre.
Sección 11ª. Vaca Joven Lactación de 31 a 35 Meses
Hembras de 31 a 35 meses en ordeño. (Nacidas entre el 1 de septiembre de 2013 y el 31 de enero de 2014). Se entregará un banderín a la Mejor Ubre.
Sección 12ª. Vaca Intermedia Lactación de 36 a 41 Meses
Hembras de 36 a 41 meses en ordeño. (Nacidas entre el 1 de marzo de 2013 y el 31 de agosto de 2013). Se entregará un banderín a la Mejor Ubre.
Sección 13ª. Vaca Intermedia Lactación de 42 a 47 Meses
Hembras de 42 a 47 meses en ordeño. (Nacidas entre el 1 de septiembre de 2012 y el 28 de febrero de 2013). Se entregará un banderín a la Mejor Ubre.
Sección 14ª. Vaca Intermedia Lactación de 4 Años
Hembras de 48 a 59 meses en ordeño. (Nacidas entre el 1 de septiembre de 2011 y el 31 de agosto de 2012). Se entregará un banderín a la Mejor Ubre.
Sección 15ª. Vaca Adulta Lactación de 5 Años
Hembras de 60 a 71 meses en ordeño. (Nacidas entre el 1 de septiembre de 2010 y el 31 de agosto de 2011). Se entregará un banderín a la Mejor Ubre.
Sección 16ª. Vaca Adulta Lactación de 6 Años o más
Hembras de 72 meses o más en ordeño. (Nacidas antes del 1 de septiembre de 2010). Se entregará un banderín a la Mejor Ubre.
Sección 17ª. Vaca en Producción de más de 50.000 kg
Competirán un mínimo de cinco hembras en lactación, con al menos tres partos, que hayan producido en lactaciones naturales finalizadas un total de 50.000 kg de leche o más según los datos de producción registrados en la Base de Datos de CONAFE e incluidos en la valoración genética de junio de 2016. Se entregará un banderín a la Mejor Ubre.
En caso de no alcanzarse el mínimo de participación establecido para esta categoría, los animales inscritos en la misma competirán en la sección anterior (Sección 16ª. Vaca adulta lactación de 6 años o más) y se les entregará el banderín que corresponda según la sección 17ª. Los puntos se asignarán a todas las vacas participantes, como una sección normal, no correspondiéndoles puntos por su posición respecto a las de más de 50.000 kg.
Sección 18ª. Vaca Joven Campeona
Competirán las dos primeras clasificadas en las secciones Vaca Joven Lactación hasta 30 meses (Sec. 10ª) y Vaca Joven Lactación de 31 a 35 meses (Sec. 11ª). Se obtendrán los títulos de Vaca Joven Campeona y Vaca Joven Subcampeona.
Sección 19ª. Vaca Intermedia Campeona
Competirán las dos primeras clasificadas en las secciones Vaca Intermedia Lactación de 36 a 41 meses (Sec. 12ª), Vaca Intermedia Lactación de 42 a 47 meses (Sec. 13ª) y Vaca In-
termedia Lactación de 4 años (Sec. 14ª). Se obtendrán los títulos de Vaca Intermedia Campeona y Vaca Intermedia Subcampeona.
Sección 20ª. Vaca Adulta Campeona
Competirán las dos primeras clasificadas en las secciones de Vaca Adulta Lactación de 5 años (Sec. 15ª), Vaca Adulta Lactación de 6 años o más (Sec. 16ª) y Vaca Producción de más de 50.000 kg (Sec. 17ª) . Se obtendrán los títulos de Vaca Adulta Campeona y Vaca Adulta Subcampeona.
Sección 21ª. Gran Campeona Nacional (Vacas)
Se obtendrán dos títulos:
Gran Campeona Nacional:
Competirán la Vaca Joven Campeona (Sec. 18ª), Vaca Intermedia Campeona (Sec. 19ª) y Vaca Adulta Campeona (Sec. 20ª). Se obtendrá el título de Gran Campeona Nacional (Vacas).
Gran Campeona Nacional Reserva:
Competirán las vacas campeonas de las secciones que no hayan conseguido el título de Gran Campeona Nacional y la Subcampeona de la sección de la que quede Gran Campeona. Se obtendrá el título de Gran Campeona Nacional Reserva.
Nota: El juzgamiento de las secciones 18ª, 19ª, 20ª y 21ª (Campeonatos de Vaca Joven, Vaca Intermedia, Vaca Adulta y Gran Campeona y Gran Campeona Reserva), se realizarán simultáneamente en pista.
Sección 22ª. Mejor Autonomía
Se entregará este premio a la Autonomía que obtenga el mayor número de puntos ganados en las secciones individuales por hembras en lactación cuyos criadores y propietarios sean ganaderos de la misma, en base al siguiente baremo:
1º2º3º4º5º6º7º8º9º10º
Vacas lactación 2018161412108642
Se obtendrán los títulos de Mejor Autonomía y Segunda Autonomía. Solo puntuarán los mejores cinco animales de cada Autonomía. En caso de empate a puntos, ganará la Autonomía que tenga más primeros puestos de sección y más segundos o terceros si siguiera habiendo empate.
Sección 23ª. Mejor Rebaño Nacional
Se entregará este premio al ganadero que obtenga el mayor número de puntos ganados en las secciones individuales por hembras de su propiedad, en base al siguiente baremo: 1º2º3º4º5º6º7º8º9º10º
Vacas lactación 2018161412108642
Terneras y Novillas 10987654321
Se obtendrán los títulos de Mejor Rebaño Nacional y Segundo Rebaño Nacional. Sólo puntuarán los mejores cinco animales de cada ganadería propietaria. En caso de empate a puntos, ganará el ganadero que tenga más primeros puestos de sección y más segundos o terceros si siguiera habiendo empate.
Sección 24ª. Mejor Criador Nacional
Se entregará este premio al ganadero que, inscrito como participante en el Concurso, obtenga el mayor número de puntos ganados en las secciones individuales por hembras con su prefijo ganadero, en base al siguiente baremo: 1º2º3º4º5º6º7º8º9º10º
Vacas lactación 2018161412108642
Terneras y Novillas 10987654321
Se obtendrán los títulos de Mejor Criador Nacional y Segundo Criador Nacional. Sólo puntuarán los mejores cinco animales de cada ganadería criadora. En caso de empate a puntos, ganará el ganadero que tenga más primeros puestos de sección y más segundos o terceros si siguiera habiendo empate.
m/a 212 Frisona Española 107
Distinciones a los mejores expositores de animales del Concurso
Objeto
Con estas distinciones se trata de fomentar que la exposición de los animales en sus cubículos se realice siguiendo unas características deseables de bienestar animal, limpieza y estética, además del trabajo en grupo y la colaboración entre participantes.
Participación
Para participar hay que formar un grupo expositor, compuesto por diferentes participantes.
Los grupos se inscribirán contactando con Gabriel Blanco, jefe del Departamento de Morfología, a la llegada al recinto ferial.
1.Jurado

Valoración de Expositores
El jurado estará compuesto por:
-Gabriel Blanco, jefe del Departamento de Morfología de CONAFE
-Juan Manuel Fernández, técnico calificador de CONAFE
-Un profesor de la Escuela preparadores de CONAFE.
2.Criterios de valoración
Se valorarán los siguientes apartados desde el día de entrada de los animales en el recinto ferial hasta el último día del Concurso:
a) Bienestar de los animales expuestos: Comodidad, limpieza del espacio, alimentación y bienestar en términos generales.
b) Preparación de los animales expuestos: Limpieza y pelado.
c) Camas: Calidad y el mantenimiento de las camas durante
todo el concurso así como la limpieza del pasillo adyacente.
d) Espacio de exposición: Limpieza, orden y originalidad del mismo.
e) Trabajo en equipo: Armonía en el trabajo y el buen talante de los componentes del grupo durante el concurso y en la pista de juzgamiento.
f) Opinión del resto de grupos participantes, mediante encuesta realizada por el jurado.
3.Normas a seguir por los expositores
En todo momento hay que cumplir lo establecido en el Reglamento del Concurso y todo aquello que la organización exija.
No estará permitido obstaculizar el paso de animales ni de personas en los pasillos mediante la colocación de elementos ornamentales en los mismos.
Se podrá ambientar musicalmente la exposición, pero no está permitido poner música demasiado alta.
Distinciones
Las distinciones se harán públicas y se otorgarán el domingo, 25 de septiembre.
Se distinguirán los 3 expositores de mayor calidad, según lo decida el jurado, con:
-Mención pública en el Concurso por megafonía.
-Reconocimiento en la revista Frisona Española.
-Entrega de diplomas.











CAMPEONATO NACIONAL DE MANEJADORES CONAFE’16
Recinto Ferial de Asturias “Luis Adaro”. Gijón, 24 de
Objetivo
CONAFE organizará durante su Concurso Nacional en Gijón, el XVI Campeonato Nacional "CONAFE 2016" de Manejadores.
Se pretende con este Campeonato:
1º Fomentar la profesionalidad y autoestima de ganaderos y profesionales.
2º Estimular a los manejadores en la formación de las técnicas de presentación de los animales en concursos, subastas, exposiciones de su ganado, etc.
Bases del Campeonato
1. Podrán participar en el Campeonato todas las personas que lo deseen sin ninguna distinción específica.
2. Se establecerán tres categorías:
•Infantil: Hasta 11 años
•Júnior: De 12 a 17 años
•Sénior: De 18 a 30 años
3. Los que deseen participar deberán inscribirse antes de las 13:00 horas del día 24 de septiembre, provistos con su D.N.I.
Condiciones de Participación
1. Todos los manejadores deberán presentarse uniformados con pantalón y camisa blancos.
2. Presentarse con un animal suficientemente domado, de tal forma que no perturbe las acciones del resto de participantes.
3. Aceptar estas norma y las decisiones del Juez.
septiembre
Condiciones de Juzgamiento
1º El Juzgamiento se basará fundamentalmente en:
1.Presentación del manejador
2.Preparación del animal: doma, limpieza, etc.
3.Habilidades del manejador en la conducción del animal
4.Atención al Juez y a sus indicaciones
2º No se valorará la morfología del animal ni su extrema preparación.
Títulos
Se concederán los títulos de:
•Campeón Nacional Infantil de Manejadores CONAFE16
•Campeón Nacional Júnior de Manejadores CONAFE16
3º) A continuación tendrá el desarrollo de las secciones. 16
•Subcampeón Nacional Infantil de Manejadores CONAFE16
•Subcampeón Nacional Júnior de Manejadores CONAFE16
•Campeón Nacional Sénior de Manejadores CONAFE16
•Subcampeón Nacional Sénior de Manejadores CONAFE16
Programa
Sábado, día 24 de septiembre.
•A las 16,15 horas se presentarán todos los participantes inscritos en la pista del Concurso con la indumentaria exigida.
•A las 16,30 horas el Juez del Concurso y Gabriel Blanco (CONAFE) explicarán:
1º) las normas para una buena presentación en pista de los animales y
2º) las reglas para ser un buen manejador.
108 Frisona Española 212 m/a


Índice de Anunciantes
Aberekin..............................Int. Contraportada
Agroseguro......................................................97
Albaitaritza -GenerVations...........................45
Anembe............................................................77
Ascol................................................Int. Portada
Bas Import/Export, S.L - GGI........................53
Ceva................................................................101
Cid Line............................................................55
CRV Genetics España, S.L.............................49
Concurso Regional de Asturias.....................17
Banco de Santander.......................................63
DeLaval Equipos.............................................89
Distrigen..........................................................59

Duran Maquinaria..........................................87
Elanco...............................................61, 82 y 83
Emporvet, S.L.................................................29
Gea Farm Technologies Ibérica, S.L.............93
Humeco ...........................................................99
Lallemand Bio, S.L.........................................67
Lely, S.L......................................38, 39, 40 y 41
Nanta................................................................69
Nutricor...........................................................73
Progenex, S.L - ABS........................................35
Sersia España - Evolution Ibérica-...............57
World Wide Sires España.........Contraportada
Xenética Fontao.....................................27 y 31


HIMALAYA

GRAN NOVEDAD

GENER HIMALAYA ZENISTA 1165 (MB-85)
C.B. Mas Gener – Riudellots de la Selva – Girona
LAS CIMAS MÁS ALTAS

• Niagra de la familia Durham Daisy EX-92.
• Producciones muy altas con buena conformación.
• Vacas longevas y funcionales, de fácil ordeño y resistentes a las mamitis.
 RHALA HIMALAYA
ALCANZANDO
NIAGRA x SHOTTLE x MORTY
RHALA HIMALAYA
ALCANZANDO
NIAGRA x SHOTTLE x MORTY

Hnos. Falcó 4 Bajo. 02002 Albacete • Tel: 967 218 218 • Fax: 967 218 272 Email: wwsires@wwsires.es • www.wwsires.es • www.facebook.com/wwsires.es JUAN JOSE MARTÍNEZ Email: juanjo@wwsires.es • Móvil: 647.47.25.45 W ORLD WIDE SIRES ESPAÑA






















































 Duf Golf
Duf Golf


























 Algendar Goldwyn Jara, Vaca Gran Campeona y Alcai Outbound Ruleta, Novilla Gran Campeona de Menorca 2016
Algendar Goldwyn Jara, Vaca Gran Campeona y Alcai Outbound Ruleta, Novilla Gran Campeona de Menorca 2016









































































 Gabriel Blanco
Jornadas prácticas de calificación en Cabaña Campazu
Gabriel Blanco
Jornadas prácticas de calificación en Cabaña Campazu



































 José Antonio Jiménez. Dpto. Técnico de CONAFE
José Antonio Jiménez. Dpto. Técnico de CONAFE

RHALA HIMALAYA
ALCANZANDO
NIAGRA x SHOTTLE x MORTY
RHALA HIMALAYA
ALCANZANDO
NIAGRA x SHOTTLE x MORTY
